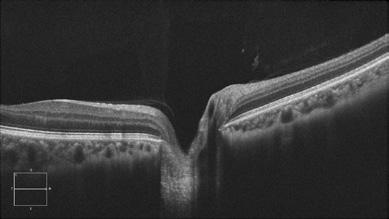

ARTICLE 1
Oxygénothérapie hyperbare et conditions oculovisuelles
ARTICLE 2
Médication soutenue, MIGS, MIBS et implants • Partie II
ARTICLE 3
Le ptérygion


ARTICLE 1
Oxygénothérapie hyperbare et conditions oculovisuelles
ARTICLE 2
Médication soutenue, MIGS, MIBS et implants • Partie II
ARTICLE 3
Le ptérygion


Pour en savoir plus, visitez coopervision.ca/fr
LA MARQUE DE LENTILLE MENSUELLE DE CONFIANCE
P armilesprofessionnels delavuecanadiens 5 #1
MAINTENANT NEUTRE PLASTIQUEENNET GRÂCE À PARTENARIATNOTREAVEC PLASTIC BANK3,4

Références : 1. Données internes, CVI. Basé sur la gamme de produits stockés et MTO disponibles aux États-Unis et en Europe en juin 2021. 2. Données internes 2021. Base de données sur la couverture des Rx ; 14-70 ans. 3. [MyDayMD à usage unique et BiofinityMD] sont définis comme des commandes et comprennent le produit [MyDayMD à usage unique, MyDayMD toric à usage unique, MyDayMD multifocal à usage unique, BiofinityMD sphere, BiofinityMD XR, BiofinityMD Energys, BiofinityMD toric, BiofinityMD XR toric, BiofinityMD multifocal et BiofinityMD toric multifocal] vendu et distribué par CooperVision au Canada. 4. L’empreinte plastique neutre nette est établie par l’achat de crédits auprès de Plastic Bank. Un crédit représente le recueil et la conversion d’un kilogramme de plastique susceptible d’atteindre ou de se retrouver dans un cours d’eau à l’échelle mondiale. CooperVision achète un nombre de crédits égal au poids du plastique dans les commandes de [MyDayMD à usage unique et BiofinityMD] au cours d’une période précise. Le plastique de [MyDayMD à usage unique et BiofinityMD] est déterminé par le poids du plastique dans l’emballage-coque, les lentilles et l’emballage secondaire, y compris les stratifiés, les adhésifs et les ajouts auxiliaires (par exemple, l’encre). RÉFÉRENCE : Données internes, CVI, 2022. 5. BiofinityMD est la marque de lentilles cornéennes souples mensuelles la plus fiable parmi les PCE canadiens. Réf. Données CV sur fichier 2023, recherche indépendante, Canada ; enquête en ligne auprès de 150 PCU qui prescrivent des lentilles de contact. Note de bas de page : D’après les 149 répondants à la question « Quelle est la marque de lentilles de contact souples à remplacement mensuel à laquelle vous faites le plus confiance pour vos patients ? » ©2024 CooperVision. SA10408-1FRCA
ÉDITEUR
Association des Optométristes du Québec 1255, boul. Robert-Bourassa, bureau 1400 Montréal, Québec H3B 3X1
COURRIEL | aoq@aoqnet.qc.ca
PRÉSIDENT
Docteur Guillaume Fortin, optométriste
ABONNEMENT ANNUEL
CANADA | 85,45 $
ÉTRANGER | 125,00 $ (taxes incluses)
COORDONNATEUR SCIENTIFIQUE
Docteur Jean-Pierre Lagacé, optométriste, M.Sc.
COURRIEL | jpierre.lagace@aoqnet.qc.ca
COORDONNATRICE DE LA PRODUCTION
Josée Lusignan | 514 288-6272
COURRIEL | josee.lusignan@aoqnet.qc.ca
PUBLICITÉ
Eric Charron
CPS Média Inc.
TÉLÉPHONE | 866 227-8414, poste 310
COURRIEL | nlalonde@cpsmedia.ca
CONCEPTION GRAPHIQUE
BooDesign.ca
ARTICLES DEMANDÉS
TÉLÉCOPIEUR | 514 288-7071
COURRIEL | aoq@aoqnet.qc.ca
SITE INTERNET | www.aoqnet.qc.ca
Bibliothèque nationale du Québec 2e trimestre 1979
Reproduction interdite sans autorisation.
LE PRÉSENT NUMÉRO A ÉTÉ TIRÉ À
3 050 exemplaires
ISSN-0708-3173
Numéro de convention postale : 41129579
L’Optométriste ouvre ses pages à toute collaboration pouvant intéresser la profession optométrique sur le plan professionnel, social, économique et syndical. Le Comité de rédaction invite tous les optométristes à soumettre le rapport d’un cas ou un article susceptible d’intéresser leurs confrères. Tous les écrits soumis deviennent la propriété de la revue l’Optométriste. Le Comité de rédaction se réserve le droit de publier un article dans le numéro qui lui convient. Aucune indemnité ne sera versée à l’auteur pour l’utilisation d’un article. Les textes ainsi que les publi-reportages publiés dans cette revue n’engagent que leur auteur.
VEUILLEZ ENVOYER VOS ARTICLES À L’ÉDITEUR
Revue l’Optométriste
1255, boul. Robert-Bourassa, bureau 1400 Montréal, Québec H3B 3X1
TÉLÉPHONE | 514 288-6272

« L’optométriste (O.D.) est un professionnel de la santé de première ligne, détenteur d’un doctorat universitaire de 5 ans, qui agit comme porte d’entrée des services oculo-visuels. Il évalue la vision, la binocularité et la santé oculaire. Son rôle est de procéder à l’examen des yeux et de la vision. Il peut également prescrire et administrer des médicaments aux fins de l’examen de la vision et du traitement de certaines pathologies oculaires. Il prescrit les lentilles ophtalmiques nécessaires, qu’elles soient cornéennes ou pour lunettes, et des traitements de rééducation visuelle. L’optométriste prodigue des conseils afin de prévenir les troubles visuels et de promouvoir la saine santé oculo-visuelle de ses patients et, au besoin, il peut diriger le patient vers d’autres professionnels de la santé. »


05 ÉDITORIAL
Du travail en vue
Docteur Guillaume Fortin, optométriste, Président
08 ARTICLE 1
Oxygénothérapie hyperbare et conditions oculovisuelles
Docteur Jean-Pierre Lagacé, optométriste, M.Sc.
17 ARTICLE 2
Médication soutenue, MIGS, MIBS et implants • Partie II
Docteur Jean-Pierre Lagacé, optométriste, M.Sc.
31 ARTICLE 3
Le ptérygion
Docteur Jean-Pierre Lagacé, optométriste, M.Sc.
40 CHRONIQUE LES CONSEILS D'AFFAIRES MNP
Marketing RH 2.0 : Évolution des pratiques dans la course aux talents
44 CHRONIQUE JURIDIQUE
Les vices de construction : quand la copropriété donne des maux de tête
46 CHRONIQUE ACTUALITÉS
57 CHRONIQUE FMOQ
L’évolution du pouvoir d’achat des ménages depuis la pandémie : de réelles surprises !
59 CHRONIQUE LUSSIER
59 Mieux vaut prévenir que « mourir »
60 Copropriétaire : ayez la bonne couverture pour votre condo
62 LES PETITES ANNONCES CLASSÉES DE L'AOQ

Une offre pensée et développée pour vos besoins personnels et professionnels.
Faites comme plusieurs optométristes et profitez de l’offre Distinction.
1 844 778-1795 poste 30 desjardins.com/optometriste

Au moment d’écrire ces lignes, vos représentants à la table de négociation sortent d’une rencontre avec nos vis-à-vis gouvernementaux pour laquelle, après neuf long mois d’attente, ils espéraient obtenir une certaine compréhension et adhésion aux demandes formulées en juin 2023. Comme vous le savez déjà, cette rencontre s’est soldée non seulement en déception, mais par ce que je qualifierais d’affront sur presque toute la ligne. Autant au niveau monétaire qu’en termes d’amélioration de la pratique tant pour nous et nos patients que pour les optométristes en cliniques et en centres de réadaptation. Ces offres gouvernementales dérisoires nous ont laissé un goût amer.

Évidemment à ce stade et par souci de respect pour le processus de négociation, nous vous épargnons les détails de ces offres ainsi qu’une profonde colère qui n’a rien de bon pour le moral. C’est notre travail de prendre cela sur nous et nous comptons toujours mener la barque à bon port. Nous nous réservons cependant, l’option de vous communiquer le nécessaire au moment opportun.
Cette négociation est bien certainement en grande partie monétaire et basée sur notre étude de frais de gestion. Nous croyons fermement et nous l’avons nombre de fois martelé, que les tarifs de la RAMQ doivent refléter les coûts inhérents à la prestation de ces services plus une rémunération personnelle adéquate pour l’optométriste. Le gouvernement n’a pas à s’immiscer dans les ententes privées qui existent entre travailleurs autonomes et propriétaires. Car oui, ces dernières comportent parfois des aberrations en ce qui a trait à qui paye sa juste part des frais de gestion…
Mais la principale cause des aberrations, la plus ancienne et la plus durable est sans contredit les tarifs RAMQ insuffisants ! Actuellement, ce qui reste des tarifs RAMQ une fois soustrait ce que cela coûte de rendre les services est autour de 3 $. Sans entrer dans les détails, ce que le gouvernement nous demande actuellement est de financer les services RAMQ à même les revenus privés… Entre autres, l’examen de la vue des 18-64 ans. Cela n’a aucun sens et est inacceptable et ce, autant pour nous que pour nos patients privés. Cette négociation est aussi une des premières où nous discutons d’accessibilité et de possibilité de nouveaux actes. Les optométristes en pratique privée… Ceux et celles qui voient des patients RAMQ et qui leur donnent des soins, sont certainement mieux placés que tout autre intervenant pour déterminer ce qui peut améliorer l’accès à certains actes et lesquels auraient avantage à être couverts ou non. Votre comité de négociations compte cinq optométristes qui pratiquent tous en cliniques d’optométrie et qui facturent tous la RAMQ. Avant le dépôt de nos demandes en juin 2023, votre comité a analysé les possibilités de nouveaux actes et de nouvelles couvertures.
Nous recevrons donc très mal des demandes de nouvelles couvertures qui nous semblent « sorties du champ gauche » ou qui nous semblent refléter la volonté d’influences externes qui n’ont rien à voir avec celle de nos membres et celle de leurs représentants élus à l’AOQ ! Aussi, nous recevrons très mal les tentatives de modifications de ce qui fonctionne bien et les refus de modifier ce qui fonctionne moins bien.
Voilà. Parfois on écrit peu alors qu’on en aurait pourtant très long à dire… Parfois c’est peut-être plus sage ainsi. Cette semaine fut très difficile pour nous à la suite de ce retour gouvernemental, mais nous sommes malgré tout prêts à donner une chance à cette négociation. Cela dit, il faudra des pas de géant pour entamer une vraie discussion.
Après une telle contre-offre, sachez que nous n’écartons rien en termes de moyens pour améliorer la situation de tous nos membres. Nous sommes déjà passés par là il n’y a pas si longtemps alors nous pouvons le refaire. En attendant, nous sommes tout de même disposés à écouter, mais aussi et plus que jamais, prêts à débattre haut et fort.
Docteur Guillaume Fortin, optométriste Président
POUR NOUS JOINDRE
514 288-6272 1 888-SOS-OPTO
DES QUESTIONS ?
écrivez-nous à aoq@aoqnet.qc.ca
FAIRE UN CHANGEMENT D'ADRESSE
Rendez-vous sur le portail de l'AOQ | aoqnet.qc.ca
Les petites annonces classées de l’AOQ




Grâce à la section des petites annonces classées de la revue l’Optométriste vous faites d’une pierre deux coups : votre annonce, au coût de 25 $ par parution (taxes en sus), sera publiée dans la revue et sera distribuée aux optométristes, aux opticiens d’ordonnances, aux ophtalmologistes et aux compagnies d’optique. Elle se retrouvera également sur notre site Internet jusqu’à la parution de la prochaine revue. Vous bénéficierez donc d’une visibilité accrue.
Votre annonce doit contenir environ 50 mots et doit être au nom d’un optométriste membre de l’AOQ. Vous devez nous faire parvenir votre annonce par courriel à josee.lusignan@aoqnet.qc.ca ou par télécopieur au 514 288-7071.

POUR LE SAVOIR, RIEN DE MIEUX QUE DE COMPARER LES RENDEMENTS, LE RISQUE ET LES FRAIS DE VOS PORTEFEUILLES AUX MARCHÉS
Demandez un deuxième avis pour vous rassurer dans vos choix ou revoir vos investissements. Service offert aux optométristes et à leurs proches.
COMMUNIQUEZ AVEC NOUS !
NOUS SOMMES À VOTRE ENTIÈRE DISPOSITION
MONTRÉAL : 514 868-2081 ou 1 888 542-8597
QUÉBEC : 418 657-5777 ou 1 877 323-5777 info@fondsfmoq.com | FONDSFMOQ.COM



L’oxygénothérapie hyperbare (OHB) consiste à utiliser de l’oxygène pur à une pression accrue (en général, 2 à 3 atmosphères), ce qui entraîne une augmentation des niveaux d’oxygène dans le sang (hyperoxémie) et dans les tissus (hyperoxie). L’augmentation de la pression et de la biodisponibilité de l’oxygène peut être liée à une pléthore d’applications, en particulier dans les régions hypoxiques, exerçant également des propriétés antimicrobiennes, immunomodulatrices et angiogéniques, entre autres. L’inclusion de l’OHB dans les futures recherches cliniques pourrait constituer un soutien supplémentaire dans la prise en charge clinique de multiples pathologies1
L’oxygénothérapie hyperbare (OHB) est une approche thérapeutique basée sur l’exposition à des concentrations pures d’oxygène (O2) dans une pression atmosphérique accrue. Selon la Undersea and Hyperbaric Medical Society (UHMS), cette pression peut être égale ou supérieure à 1,4 atmosphère (atm) [1]. Cependant, toutes les indications actuelles approuvées par l’UHMS exigent que les patients respirent près de 100 % d’oxygène tout en étant enfermés dans une chambre pressurisée à un minimum de 2 ATA2
La première utilisation documentée de la thérapie médicale hyperbare a été réalisée en 1662 par Henshaw, un médecin britannique qui a placé des patients dans un conteneur contenant de l’air sous pression. Il est intéressant de noter que cette expérience a été réalisée avant la formulation de la loi de Boyle-Mariotte, qui décrit la relation entre la pression et le volume d’un gaz, et avant la découverte de l’O2 par John Priestly plus de 100 ans plus tard3 Par la suite, l’utilisation de l’OHB dans les soins médicaux a été retardée par l’observation, par Lavoisier et Seguin en 1789, d’effets indésirables possibles de l’O2 à des concentrations de 100 %.
Des années plus tard, en 1872, Paul Bert, considéré comme le « père de la physiologie hyperbare », a décrit la base physiologique de l’air sous pression dans le corps humain, définissant également les effets neurotoxiques de l’O2 dans le corps humain, appelés par conséquent l’effet Paul Bert4, suivi par la description de la toxicité pulmonaire de l’O2 par Lorrain Smith5. Simultanément, un intérêt croissant pour l’utilisation de l’OHB dans le traitement de différentes affections a été signalé, y compris le traitement des plongeurs qui ont souffert de la maladie de décompression pendant la Seconde Guerre mondiale6. Depuis lors, une pléthore d’études ont été réalisées, et des centaines d’installations basées sur l’OHB ont été créées au début du 21e siècle7 Il existe actuellement 14 indications approuvées pour l’OHB, dont une grande variété de complications telles que l’embolie gazeuse, l’anémie sévère, certaines maladies infectieuses ou la surdité sensorielle idiopathique. En outre, la dernière conférence de consensus européenne sur la médecine hyperbare a mis en évidence l’utilisation de l’OHB comme méthode de traitement primaire pour certaines pathologies en fonction de leur degré de preuve modéré à élevé (par exemple, après un empoisonnement au monoxyde de carbone [CO]), ou comme adjuvant potentiel à considérer dans d’autres pathologies avec un degré de preuve scientifique modéré (par exemple, le pied diabétique)8. Dans ce travail, nous examinerons en détail les fondements de l’O2 en tant qu’agent thérapeutique et les principes de la médecine hyperbare en ce qui concerne les applications les plus pertinentes de l’OHB et les implications potentielles pour les différentes approches, y compris la COVID-19.
L’O2 est un nutriment souvent négligé en raison de son accès particulier à l’intérieur du corps humain, par les poumons et non par le tractus gastro-intestinal, comme c’est le cas pour tous les autres nutriments9. L’O2 est essentiel pour que les cellules humaines puissent effectuer la respiration aérobie, qui a lieu dans les mitochondries. L’O2 y joue le rôle d’accepteur d’électrons, ce qui conduit finalement à la synthèse d’ATP dans un processus connu sous le nom de phosphorylation oxydative. D’un point de vue évolutif, l’absorption de l’O2 est à l’origine des cellules eucaryotes, résultant d’une relation endosymbiotique entre des cellules procaryotes (archées et eubactéries) qui étaient capables d’utiliser ce nutriment10. Ce fait représentait un avantage adaptatif par rapport aux cellules incapables de l’utiliser, les organismes complexes coévoluaient avec l’O2, devenant ainsi un nutriment essentiel pour nos cellules11
Indications approuvées pour l’OHB12
Embolie gazeuse ou aérienne
Brûlure thermique aiguë
Intoxication au monoxyde de carbone
Intoxication au monoxyde de carbone compliquée par une intoxication au cyanure
Occlusion de l’artère rétinienne centrale
Myosite clostridienne et myonécrose (gangrène gazeuse)
Greffes et lambeaux compromis
Lésions par écrasement, syndrome du compartiment et autres ischémies traumatiques aiguës
Maladie de décompression
Lésions par irradiation retardée (nécrose des tissus mous et des os)
Amélioration de la cicatrisation de certaines plaies problématiques
Perte auditive neurosensorielle soudaine et idiopathique
Abcès intracrânien
Infections nécrosantes des tissus mous
Ostéomyélite réfractaire
Anémie sévère
Nous savons que l’ORC (occlusion de l’artère rétinienne centrale) est une complication oculaire causée par une occlusion permanente de l’artère centrale de la rétine, principalement due à un embole dans sa partie la plus étroite, qui est typiquement associée à une perte soudaine et massive de la vision dans l’œil affecté13. Le pronostic de récupération visuelle est mauvais, car le tissu rétinien ne tolère pas l’hypoxie et présente le taux de consommation d’oxygène le plus élevé de l’organisme, soit 13 ml/100 g par minute. Par conséquent, l’OHB est une indication solide pour les patients atteints d’ORC et de nombreuses études ont rapporté des résultats encourageants de son utilisation, au minimum à huit séances, avec certains avantages présentés par rapport à d’autres lignes de traitement, comme une méthode non invasive avec peu d’effets indésirables14-17 Cependant, et malgré ces avantages, l’OHB est rarement proposée aux patients atteints d’ORC17, probablement en raison du manque d’installations dans les services hospitaliers.

Chambre hyperbare en utilisation. Photo prise par moi-même de notre chambre hyperbare Sechrist à l’hôpital Moose Jaw Union, Saskatchewan, Canada. Autorisation de photographier le sujet pour Wikipédia accordée. Photo prise le 11 juillet 2008 18 Selon licence CC BY-SA 3.0 DEED
La rétine a le taux de consommation d’oxygène le plus élevé de tous les organes; par conséquent, des lésions hypoxiques-ischémiques sont fréquemment observées dans de nombreuses maladies ophtalmiques. L’oxygénothérapie hyperbare (OHB), un traitement médical qui vise à augmenter les niveaux d’oxygène dissous dans les tissus, a été utilisée comme traitement adjuvant de maladies menaçant la vision, comme l’occlusion de l’artère rétinienne (OAR), l’occlusion de la veine rétinienne (OVR), l’œdème maculaire diabétique (OMD) et la neuropathie optique aiguë; cependant, l’OHB n’a pas été approuvée pour ces conditions par les autorités de réglementation.
Pendant l’OHB, les patients respirent presque 100 % d’oxygène à l’intérieur d’un caisson hyperbare pressurisé à 1 atmosphère absolue (ATA). L’azote contenu dans le vitré est remplacé par de l’oxygène pendant la thérapie et le vitré agit comme une réserve d’oxygène pendant les deux premiers jours du traitement. On a observé que le niveau d’oxygène dans les tissus restait élevé jusqu’à 4 heures après le traitement19
L’administration d’oxygène à haute pression atmosphérique augmente le transport de l’oxygène dans les tissus, et il a été démontré que l’utilisation de l’OHB intraoculaire dans les troubles ophtalmiques ischémiques augmentait la saturation en oxygène du corps vitré. L’OHB protège les cellules neuronales rétiniennes lésées de l’apoptose20. Sur la base des résultats observés lors d’études expérimentales sur des modèles animaux, des effets bénéfiques similaires de l’OHB peuvent être observés dans le traitement de l’ischémie rétinienne chez l’homme21. L’OHB peut également être utilisée pour obtenir un gradient de diffusion plus élevé de la circulation choroïdienne vers les couches externes22 Cependant, l’OHB est sous utilisée en ophtalmologie en raison de la piètre qualité des données probantes à l’appui de l’OHB en tant que traitement, et toutes ses indications ne sont actuellement pas mentionnées sur l’étiquette.
En 2008, Butler et ses collaborateurs23 ont examiné en détail le rôle de l’OHB dans les troubles oculaires en passant en revue neuf troubles oculaires pour lesquels l’Undersea and Hyperbaric Medical Society a indiqué l’OHB, notamment la maladie de décompression ou l’embolie gazeuse artérielle et l’intoxication au monoxyde de carbone accompagnée de symptômes visuels. D’autres indications oculaires de l’OHB sont étayées par des preuves considérables, notamment la neuropathie optique ischémique, l’occlusion de l’artère ou de la veine rétinienne et l’œdème maculaire. Selon leur analyse, l’efficacité de l’OHB dans ces troubles varie en raison des différences dans le délai entre l’apparition des symptômes et le début de l’OHB. Cependant, depuis la publication de cet article, de nombreuses études ont démontré l’efficacité et la polyvalence de la thérapie hyperbare en ophtalmologie21, 24, 25-29
L’artère rétinienne (AR) et la choroïde sont les deux principales sources d’approvisionnement en sang de la rétine. La diffusion à partir de la circulation choroïdienne (CC) alimente la rétine externe et la zone avasculaire fovéale (ZAF). Bien que le système d’autorégulation interne de la rétine modifie le flux sanguin et la densité vasculaire en réponse à des conditions inattendues afin de maintenir la stabilité du flux sanguin et de l’oxygénation30, il peut ne pas fonctionner correctement dans des conditions telles que la rétinopathie diabétique (RD) ou la dégénérescence maculaire liée à l’âge31, 32
La microvasculature maculaire est un système complexe comprenant trois plexus capillaires pour l’approvisionnement en sang de la rétine interne : le plexus rétinien superficiel (SP), situé dans la couche des fibres nerveuses rétiniennes, et les deux plexus situés aux bords interne et externe de la couche nucléaire interne, qui constituent le plexus rétinien profond (DP)33. On a observé que les réponses à l’hypoxie dans la circulation de l’AR et de la CC varient34
Des études récentes ont évalué l’impact de l’OHB sur les caractéristiques anatomiques d’une rétine saine à l’aide de techniques d’imagerie modernes, telles que la tomographie par cohérence optique dans le domaine spectral (SD-OCT) et l’angiographie par OCT. Cependant, leurs résultats sont contradictoires.
Une étude récente menée par Sayin et coll.24 a examiné les effets de l’OHB sur les couches rétiniennes d’yeux sains. Le groupe d’étude était composé de 30 patients : 14 femmes et 16 hommes. Les indications de l’OHB étaient les suivantes : perte auditive soudaine chez 21 patients (70 %), ostéomyélite chronique chez deux patients (6,7 %) et nécrose aseptique chez sept patients (23,3 %). Le groupe de contrôle était composé de neuf patients de sexe féminin et de onze patients de sexe masculin. La SD-OCT a été réalisée pour obtenir des mesures automatisées de l’épaisseur de chaque couche rétinienne. Les scans OCT de la rétine ont été effectués avant l’OHB et après la première et la dixième séance, et les résultats ont été comparés entre les visites. Aucune modification de l’épaisseur des couches rétiniennes n’a été observée après la première et la dixième séance dans les yeux sains.
Ce résultat ne concorde pas avec celui de l’étude de Tukenmez Dikmen et coll.36, qui ont évalué l’effet de l’OHB sur les composantes vasculaires et stromales de la choroïde et de la macula dans des yeux sains. Ils ont effectué un SD-OCT avant et une demi-heure après la première et la vingtième séance d’OHB et ont mis en évidence une modification statistiquement significative de l’épaisseur maculaire centrale avant et après l’OHB. Ils ont ainsi émis l’hypothèse que l’OHB pourrait être considérée comme une option thérapeutique complémentaire et facilitante, en plus des traitements actuels, pour les patients souffrant d’un œdème maculaire dû à des troubles vasculaires rétiniens. Çevik et coll.35 ont signalé qu’une rétine saine réagit à la sursaturation en oxygène de l’OHB, ce qui entraîne une diminution de la densité vasculaire de toutes les couches. Ils ont également signalé des diminutions significatives des densités des réseaux capillaires SP et DP dans la région maculaire. Ils ont souligné que l’OHB augmente la concentration d’oxygène dans la rétine externe avasculaire grâce à l’apport accru de la CC, qui maintient un débit constant à des niveaux d’oxygène élevés. Le DP doit contrecarrer une vasoconstriction plus importante pour maintenir un flux d’oxygène constant dans la rétine externe.
L’OHB dans les maladies de la rétine
Rétinopathie diabétique
L’OHB a été signalée comme pouvant être utile dans le traitement de la rétinopathie diabétique38
Des études expérimentales ont montré que l’hyperoxie diminue l’expression du VEGF dans la rétine adulte et que l’OHB améliore la rupture de la barrière hématorétinienne (BRB). Elle peut donc prévenir et traiter l’œdème maculaire persistant dû à la rupture de la barrière hématorétinienne chez les patients atteints de diabète39
Le traitement par OHB d’un cas d’œdème maculaire diabétique a entraîné une amélioration bilatérale de la vision, qui est passée de 20/125 à 20/63 dans l’œil droit et de 20/320 à 20/160 dans l’œil gauche, après 14 séances sur une période d’un mois. Bien que l’œdème maculaire soit réapparu au cours des mois suivants, l’OHB a permis de contrôler la baisse de la vision à chaque fois40. De même, deux essais cliniques portant sur des patients atteints d’œdème maculaire ont fait état d’une amélioration de l’acuité visuelle après une OHB chronique. L’un d’eux a montré une amélioration de 2 lignes ou plus dans 68 % des yeux, tandis que l’autre a fait état d’une augmentation moyenne de 3,5 lignes41, 42 Récemment, une étude de cohorte prospective a révélé que l’OHB avait un effet amincissant sur la macula dans les yeux diabétiques, ce qui confirme le mécanisme hypothétique de l’oxygène hyperbare sur la dégradation du BRB43. Ces premiers résultats sont encourageants et d’autres études sont nécessaires pour élucider l’efficacité de l’OHB sur la rétinopathie diabétique et les occlusions de l’artère rétinienne.
La RD et l’OMD sont considérés comme les complications microvasculaires chroniques les plus courantes du diabète sucré, qui peuvent entraîner une déficience visuelle et une diminution de la qualité de vie chez les adultes en âge de travailler29. Sur la base de l’évaluation des lésions microvasculaires de la rétine, la RD peut être classée en deux stades : la rétinopathie diabétique non proliférante (NPDR) et la rétinopathie diabétique proliférante (PDR), plus grave. La NPDR se caractérise par la présence de microanévrismes, d’hémorragies intrarétiniennes, de perles veineuses, de taches d’ouate, d’exsudats durs et d’anomalies microvasculaires intrarétiniennes. En revanche, la PDR se caractérise par une néovascularisation (NV), c’est-à-dire la formation de nouveaux vaisseaux sanguins anormaux dans la rétine, le disque optique et l’iris, et peut entraîner une perte de vision due à une hémorragie du vitré, à un décollement de la rétine par traction et à un glaucome. L’acuité visuelle (AV) peut se détériorer à n’importe quel stade de la rétinopathie, indépendamment de la présence d’un OMD.
L’occlusion microvasculaire, la rupture de la barrière hématorétinienne entraînant une fuite capillaire et l’inflammation locale chronique sont considérées comme les principaux mécanismes de la RD. Cependant, des études récentes ont montré que le dysfonctionnement de l’unité neurovasculaire de la rétine contribue à la pathogenèse de la RD25. Le rôle physiopathologique de la choroïdopathie diabétique ne peut être négligé. La compréhension des pathogènes de la RD et de l’OMD est devenue cruciale pour le développement de nouvelles thérapies. La photocoagulation au laser et les agents pharmacologiques intravitréens, tels que les inhibiteurs de la voie du facteur de croissance dérivé de l’endothélium vasculaire (VEGF) et les corticostéroïdes, ont révolutionné le traitement de la RD et de l’OMD. Néanmoins, le développement de nouveaux traitements pour les patients qui ne répondent pas aux thérapies disponibles reste crucial.
Depuis plus de trente ans, les chercheurs ont émis l’hypothèse que l’OHB pourrait être bénéfique dans le traitement de la RD. Cependant, il n’existe aucune preuve concluante de l’effet de l’OHB sur l’évolution de la RD dans la littérature. Des études expérimentales antérieures ont démontré que l’OHB améliore la dégradation de la barrière hématorétinienne; on peut donc supposer que l’OHB peut traiter l’œdème maculaire44
Cependant, seuls quelques rapports préliminaires ont fait état de l’impact positif de l’OHB sur l’œdème maculaire45, 46 Sellman et coll.27 ont évalué les effets de l’OHB sur l’AV et la rétinopathie chez des patients souffrant d’ulcères chroniques du pied diabétique dans le cadre d’une étude prospective, randomisée, en double aveugle, contrôlée par placebo et assortie d’une période de suivi de deux ans. Les 50 patients inclus dans l’étude ont été divisés en deux groupes et les résultats du groupe OHB ont été comparés à ceux du groupe placebo. Aucune différence n’a été observée entre les deux groupes en ce qui concerne l’acuité visuelle, le stade de la rétinopathie ou l’œdème maculaire. Le traitement par OHB a donc été considéré comme neutre d’un point de vue ophtalmologique. Ces résultats diffèrent considérablement de ceux rapportés par Maalej et coll.47, qui ont mis en évidence une réduction de l’épaisseur maculaire centrale (CMT) et une stabilisation des lésions de la RD chez les patients ayant reçu l’OHB. Dans leur étude, les patients atteints de NPDR ont été divisés en deux groupes de 25 patients chacun. Le premier groupe a reçu une OHB pendant six semaines pour traiter les ulcères du pied diabétique, tandis que le second groupe a été suivi sans OHB. Les patients n’ont pas reçu de traitement ophtalmologique concomitant. Les examens ophtalmologiques et le SD-OCT effectués avant et 6 semaines après le traitement ont révélé que l’OHB pouvait être utilisée comme traitement d’appoint pour la prise en charge de l’ischémie rétinienne et de l’hyperperméabilité capillaire dans la RD.
Des résultats similaires ont été obtenus dans une étude de cohorte prospective et non randomisée menée par Kaldırım et coll.48. Dans cette étude, les patients atteints de diabète de type 2 et d’ulcères du pied diabétique chroniques coexistants ont été répartis dans les trois groupes de traitement adjuvant suivants : (1) NPDR légère à modérée, (2) NPDR grave et (3) PDR sans signes prolifératifs actifs ayant bénéficié d’un traitement au laser appliqué pendant au moins deux ans. Tous les participants ont reçu 30 séances d’OHB pour le traitement des ulcères du pied diabétique. Des examens ophtalmologiques et des scans OCT ont été réalisés avant le traitement, après les dixième, vingtième et trentième séances, et dix jours après la fin du traitement. Bien qu’aucune progression ou régression du stade PDR n’ait été observée dans aucun groupe, l’OHB a entraîné un épaississement de la macula sur le SD-OCT chez les patients atteints de NPDR. En outre, un amincissement de la couche choroïdienne a été observé, ce qui pourrait indiquer l’effet vasoconstricteur de l’OHB sur la choroïde. Les résultats de cette étude appuient l’hypothèse de Kiryu et Ogura49 selon laquelle l’oxygénation directe de la rétine réduit la fuite rétinienne par vasoconstriction.
En revanche, une étude menée par Gün et coll.50 n’a révélé aucun effet aigu sur l’épaisseur du CMT ou de la choroïde chez des patients atteints de NPDR et de diabète de type 2 qui avaient subi une OHB pour traiter des ulcères du pied diabétique. Cependant, leur étude n’a évalué que l’effet immédiat de l’OHB sur les épaisseurs maculaire et choroïdienne, et la divergence avec les résultats d’autres études peut être attribuée au fait que les mesures ont été prises avant et après la première séance de traitement, sans tenir compte de l’effet cumulatif de la thérapie.
La pathogenèse de la RD implique diverses voies inflammatoires, telles que la régulation des chimiokines et des cytokines. Le VEGF joue un rôle crucial dans le développement des lésions vasculaires dans la RD et favorise l’angiogenèse pathologique et la perméabilité vasculaire. En outre, la gravité de la RD est fortement corrélée à la concentration intraoculaire de VEGF51
Des études menées sur des modèles animaux ont démontré que l’OHB augmente la production de VEGF pour faciliter l’angiogenèse, qui est nécessaire à la cicatrisation des plaies52, 53. Cela pourrait expliquer en partie l’efficacité de l’OHB de soutien dans le traitement des ulcères chroniques du pied diabétique54, 55. D’après ces données, l’OHB pourrait contribuer à la détérioration du diabète en raison d’une augmentation du VEGF. Cependant, à notre connaissance, aucune étude n’a confirmé une augmentation de la sécrétion de VEGF dans le corps vitré à la suite d’une OHB. En outre, aucune étude n’a été menée sur l’exacerbation de la RD après l’OHB, à l’exception de deux rapports de cas d’hémorragie vitréenne56, 57
Dans l’un de ces cas, le patient avait des antécédents de PDR dans les deux yeux. Les lésions actives de l’œil gauche ont été traitées par photocoagulation panrétinienne, mais une hémorragie vitréenne s’est produite dans l’œil droit à la suite d’une vitrectomie. Après huit séances d’OHB pour traiter un ulcère chronique du pied, une hémorragie du vitré est survenue dans l’œil gauche56. Dans l’autre cas, un patient ayant des antécédents de RD bilatérale traitée quelques années auparavant par photocoagulation panrétinienne a reçu de l’OHB comme traitement d’appoint des ulcères du pied diabétique57
Une opération de phacoémulsification avec insertion d’une lentille intraoculaire a été réalisée 3 mois et 1 an avant l’OHB, respectivement, pour l’œil gauche et l’œil droit. L’examen ophtalmologique effectué avant la première séance d’OHB a révélé une RDNP. La fundoscopie effectuée après la cinquième séance d’OHB a révélé une hémorragie prérétinienne dans l’œil gauche. Une détérioration des changements prolifératifs a été observée dans les deux yeux après 12 séances d’OHB. Cependant, l’effet de la chirurgie de la cataracte et de la vitrectomie doit être pris en compte chez ce patient de 34 ans57
Occlusion de l’artère rétinienne centrale
Le traitement efficace de l’ORC est particulièrement intéressant en raison de l’apparition aiguë de la perte de vision, de la morbidité fonctionnelle importante et de la relative intraitabilité. En améliorant l’apport d’oxygène au tissu rétinien ischémique, l’OHB peut théoriquement servir de traitement aigu de l’ORC visant à réduire le plus possible la perte de vision avant la recanalisation58, 59. Pendant l’OHB, l’augmentation de la pression partielle d’oxygène a des effets marqués sur le système vasculaire ophtalmique, provoquant une vasoconstriction réversible dans les artérioles et les veinules de la rétine60. Malgré cette réponse vasculaire, la rétine peut rester correctement oxygénée en raison de l’augmentation considérable de l’oxygène plasmatique dans la choriocapillaire pendant le traitement61. Par conséquent, la vascularisation choroïdienne hyperoxygénée peut répondre à la totalité de la demande en oxygène de la rétine, des études animales montrant une oxygénation adéquate malgré l’occlusion de l’artère rétinienne62, 63
Par conséquent, la présence d’une circulation choroïdienne intacte est essentielle pour que l’OHB parvienne à inverser avec succès la perte de vision64
Le délai entre l’apparition des symptômes et le début de l’OHB et les observations du fond d’œil, notamment la présence d’une tache rouge cerise, la modification de l’épaisseur maculaire et le degré de désorganisation des couches internes de la rétine, apparaissent comme des marqueurs cliniques permettant de prédire la réponse à l’OHB40
La reconnaissance généralisée de l’ORC en tant que pathologie émergente, nécessitant souvent l’administration rapide de plusieurs lignes de traitement, a permis de réduire le délai d’acheminement de l’OHB. De nombreux rapports de cas récents ont attribué leur succès à l’administration rapide de l’OHB dès l’apparition de l’ORC65-67. Étant donné que les lésions irréversibles commencent après une heure et demie d’ischémie rétinienne, les meilleurs résultats ont été documentés lors de l’application de l’OHB dans les deux heures qui suivent l’apparition des symptômes.
Hadanny et coll. ont proposé que l’utilisation d’une tache rouge cerise visible comme indicateur physiologique d’une efficacité réduite de l’OHB soit plus prédictive que le délai d’apparition de l’ORC68. D’autres prédicteurs négatifs de la réussite de l’OHB sont l’architecture rétinienne pathologique et l’épaississement maculaire, qui sont tous deux des signes directs de la gravité et de la progression de l’ischémie69

La présence de collatéraux ciliorétiniens est un indicateur physiologique positif de la réussite de l’OHB70.
En 2001, une étude rétrospective portant sur 35 patients traités par OHB et 37 témoins appariés a mis en évidence une amélioration de l’acuité visuelle chez 82 % des patients du groupe hyperbare, contre seulement 29,7 % dans le groupe non traité. Les améliorations moyennes mesurées par l’échelle de Snellen étaient respectivement de 0,1957 et de 0,045771=.[22] Ces résultats concordent avec ceux d’études de cas antérieures montrant une amélioration de l’acuité visuelle chez les patients atteints d’ORC après l’OHB72, 73
Cependant, un essai clinique réalisé en 2000 sur l’OHB chez des patients atteints d’ORC un jour après l’apparition des symptômes n’a révélé aucune différence significative sur le plan de la vision entre le groupe ayant reçu l’OHB et le groupe témoin ayant bénéficié d’un traitement standard comprenant un massage oculaire, une paracentèse et de l’acétazolamide par voie intraveineuse51. Des études récentes ont fait état de résultats cliniques prometteurs, bon nombre d’entre elles indiquant une restauration quasi complète ou complète de l’acuité visuelle après l’OHB75
Autres affections vasculaires
Une occlusion isolée de l’artère ciliorétinienne traitée par vingt séances d’OHB (120 minutes, 2ATA) et, dans un autre cas, combinée à une occlusion non ischémique de la veine centrale de la rétine secondaire à l’altitude (2 heures quotidiennes d’OHB à 2,5 ATA pendant 11 jours) ont également montré une bonne amélioration de la vision76, 77
Chez les patients souffrant d’une obstruction de la veine rétinienne, l’OHB a amélioré le pronostic visuel, et chez les patients souffrant d’une obstruction de la veine rétinienne associée à un œdème maculaire cystoïde, l’OHB a amélioré l’œdème maculaire et l’acuité visuelle78, 79
Un œdème maculaire cystoïde résistant à d’autres modalités thérapeutiques a répondu à l’OHB et amélioré l’acuité visuelle80
Plusieurs séances d’OHB ont été associées à une amélioration de la fonction visuelle et de l’apparence de la rétine chez des patients atteints de rétinopathie de Purtscher81
L’OHB précoce a été utilisée pour traiter la cécité bilatérale pendant l’hémodialyse82
L’amincissement, la fonte ou la nécrose sclérale peuvent résulter de l’utilisation de l’irradiation bêta ou de la mitomycine C pour prévenir les récidives chez les patients atteints de ptérygion83. L’OHB a donné des résultats prometteurs chez ces patients, en augmentant le flux sanguin épiscléral et l’épaisseur sclérale84. L’hyperoxie et l’induction de l’angiogenèse et de la prolifération des fibroblastes semblent être à l’origine des bienfaits de l’OHB dans ces scénarios83
La mucormycose est une affection rare, mais grave chez les patients immunodéprimés, qui peut toucher l’orbite. Le traitement de cette affection consiste en l’administration intraveineuse d’amphotéricine B et le débridement des tissus nécrosés. Néanmoins, le taux de mortalité est élevé. L’OHB pourrait constituer un traitement complémentaire pour ces patients. L’OHB a une activité antifongique directe en augmentant la production de radicaux libres à base d’oxygène. En outre, elle possède plusieurs propriétés antimicrobiennes indirectes, comme l’inversion de l’acidose lactique favorisant la croissance, le rétablissement de la phagocytose et l’augmentation du burst oxydatif par les leucocytes polymorphonucléaires. Enfin, elle renforce l’action antifongique de l’amphotéricine B85
Price et Steves ont été les premiers à utiliser l’OHB chez un patient atteint de mucormycose rhinocérébrale qui n’avait pas répondu au traitement médical et avait refusé l’intervention chirurgicale86. Plus tard, d’autres ont rapporté que l’amphotéricine B et l’intervention chirurgicale avec l’OHB donnaient de meilleurs résultats87-89. Dans une revue détaillée des cas de mucormycose rhino-orbitaire-cérébrale, Yohai et coll. ont constaté que l’OHB avait un effet favorable sur le pronostic90
Œdème cornéen et ischémie du segment antérieur
De bonnes raisons physiologiques peuvent expliquer pourquoi l’OHB peut avoir des effets bénéfiques sur certaines maladies oculaires. L’œdème cornéen d’étiologies diverses et l’ischémie du segment antérieur, en particulier lorsqu’ils sont associés à la drépanocytose, semblent être une indication appropriée de l’OHB91, 92. Bien que ses résultats n’aient pas été cliniquement prouvés, l’administration transcornéenne d’oxygène a été suggérée pour le traitement de la nécrose du segment antérieur et de la rubéose iridienne93
Vitréorétinopathie proliférative due à la drépanocytose
Il a été démontré que la vitréorétinopathie proliférative due à la drépanocytose pouvait également bénéficier de l’OHB94
La théorie vasculaire du glaucome semble être une justification scientifique de l’application de l’OHB. En ce sens, certaines études ont fait état d’une amélioration du champ visuel sans modification significative de la pression intraoculaire chez des patients atteints de glaucome95, 96. Inversement, une autre étude a associé l’OHB à une diminution de la pression intraoculaire97. D’autres études sont nécessaires pour déterminer le rôle de l’OHB dans le glaucome.
L’OHB a donné des résultats contradictoires dans la neuropathie optique radique. Dans une étude, le traitement administré dans les 72 premières heures de la perte de vision a permis d’améliorer l’acuité visuelle jusqu’au niveau de base. En revanche, l’OHB administrée entre la deuxième et la sixième semaine de la perte de vision n’a pas amélioré l’acuité visuelle98. À l’inverse, l’acuité visuelle s’est améliorée chez un patient ayant reçu une OHB pour une neuropathie optique radio-induite pendant 17 semaines après l’apparition de la neuropathie optique99. Cependant, dans une revue de Levy et Miller, aucun effet bénéfique n’a été démontré pour les cas de neuropathie optique radio-induite100
L’OHB a permis une amélioration significative de l’acuité visuelle et du champ visuel chez deux patients atteints de neuropathie optique ischémique antérieure non artéritique101. Cependant, Arnold et coll. ont montré dans un essai clinique contrôlé que l’OHB n’était pas efficace pour le traitement de la neuropathie optique ischémique antérieure non artéritique, ce qui a été confirmé plus tard par Mathews dans une revue102, 103
Rétinite pigmentaire
La mauvaise circulation sanguine est une composante bien connue de la rétinite pigmentaire83. L’OHB chez les patients atteints de rétinite pigmentaire a amélioré l’œdème maculaire et l’acuité visuelle104. Elle a également amélioré les réponses de l’électrorétinogramme et le métabolisme des cellules photoréceptrices de la rétine105
Néovascularisation choroïdienne
Malerbi et coll.106 ont évalué l’effet de l’OHB sur les NV choroïdiennes. Dans leur étude, sept patients ont reçu 10 séances quotidiennes de 120 minutes d’OHB. Après les séances, cinq patients ont reçu des injections intravitréennes de bevacizumab. La période de suivi moyenne a été de 150 jours.
1. HBO Indications—Undersea & Hyperbaric Medical Society. Disponible en ligne: https://www.uhms.org/resources/ hbo-indications.html# .
2. UHMS Position Statement: Low-Pressure Fabric
Hyperbaric Chambers Title: Low-Pressure Fabric
Hyperbaric Chambers. 2017. Disponible en ligne: https:// www.uhms.org/images/Position-Statements/UHMS_ Position_Statement_LP_chambers_revised.pdf.
3. Edwards, M.L. Hyperbaric Oxygen Therapy. Part 1 : History and Principles. J. Vet. Emergy Crit. Care 2010, 20, 284–288
4. Dejours, P.; Dejours, S. The Effects of Barometric Pressure According to Paul Bert: The Question Today. Int. J. Sports Med. 1992, 13, S1–S5.
5. Hedley-Whyte, J. Pulmonary Oxygen Toxicity: Investigation and Mentoring. Ulst. Med. J. 2008, 77, 39–42.
6. Jones, M.W.; Wyatt, H.A. Hyperbaric, Physics; StatPearls Publishing: Treasure Island, FL, USA, 2019.
7. Moon, R.E.; Camporesi, E.M. Hyperbaric Oxygen Therapy: From the Nineteenth to the Twenty-First Century. Respir. Care Clin. N. Am. 1999, 5, 1–5.
8. Mathieu, D.; Marroni, A.; Kot, J. Tenth European Consensus Conference on Hyperbaric Medicine: Recommendations for Accepted and Non-Accepted Clinical Indications and Practice of Hyperbaric Oxygen Treatment. Diving Hyperb. Med. 2017, 47, 24–31.
9. Trayhurn, P. Oxygen—The Forgotten Nutrient. J. Nutr. Sci. 2017, 6, e47.
10. Martin, W.F.; Garg, S.; Zimorski, V. Endosymbiotic Theories for Eukaryote Origin. Philos. Trans. R. Soc. B Biol. Sci. 2015, 370, 20140330.
11. Trayhurn, P. Oxygen—A Critical, but Overlooked, Nutrient. Front. Nutr. 2019, 6, 10.
12. Ortega MA, Fraile-Martinez O, García-Montero C, Callejón-Peláez E, Sáez MA, Álvarez-Mon MA, GarcíaHonduvilla N, Monserrat J, Álvarez-Mon M, Bujan J, Canals ML. A General Overview on the Hyperbaric Oxygen Therapy: Applications, Mechanisms and Translational Opportunities. Medicina (Kaunas). 2021 Aug 24;57(9):864. doi: 10.3390/medicina57090864. PMID: 34577787; PMCID: PMC8465921. ou https://www.mdpi.com/1648-9144/57/9/864
13. Hayreh, S.S. Central Retinal Artery Occlusion. Indian J. Ophthalmol. 2018, 66, 1684–1694. 104, Hanley, M.E.; Cooper, J.S. Hyperbaric, Central Retinal Artery Occlusion; StatPearls Publishing: Treasure Island, FL, USA, 2018.
14. Bağlı, B.S.; Çevik, S.G.; Çevik, M.T. Effect of Hyperbaric Oxygen Treatment in Central Retinal Artery Occlusion. Undersea Hyperb. Med. 2018, 45, 421–425.
15. Olson, E.A.; Lentz, K. Central Retinal Artery Occlusion : A Literature Review and the Rationale for Hyperbaric Oxygen Therapy. Mol. Med. 2016, 113, 53–57.
À la fin du suivi, la surface et le diamètre des NVC ont diminué chez cinq patients, sont restés inchangés chez un patient et ont augmenté chez un autre. Les auteurs ont suggéré que l’OHB, en monothérapie ou en association avec des agents anti-VEGF intravitréens, pourrait constituer une option thérapeutique pour les patients atteints de NVC active, en retardant potentiellement sa progression. Toutefois, en raison du petit nombre de participants à l’étude, de la courte période de suivi, de l’absence d’un groupe témoin et de l’inclusion des seuls participants présentant des caractéristiques pronostiques défavorables au départ, les données restent peu convaincantes.
16. Kim, S.H.; Cha, Y.S.; Lee, Y.; Kim, H.; Yoon, I.N. Successful Treatment of Central Retinal Artery Occlusion Using Hyperbaric Oxygen Therapy. Clin. Exp. Emerg. Med. 2018, 5, 278–281.
17. Youn, T.S.; Lavin, P.; Patrylo, M.; Schindler, J.; Kirshner, H.; Greer, D.M.; Schrag, M. Current Treatment of Central Retinal Artery Occlusion: A National Survey. J. Neurol. 2018, 265, 330–335.
18. https://upload.wikimedia.org/wikipedia/commons/f/fa/ HyperBaric_Oxygen_Therapy_Chamber_2008.jpg
19. Bagli, B.S.; Çevik, S.G.; Çevik, M.T. Effect of hyperbaric oxygen treatment in central retinal artery occlusion. Undersea Hyperb. Med. 2018, 45, 421–425.
20. Di Vincenzo, H.; Kauert, A.; Martiano, D.; Chiabo, J.; Di Vincenzo, D.; Sozonoff, I.; Baillif, S.; Martel, A. Efficacy and safety of a standardized hyperbaric oxygen therapy protocol for retinal artery occlusion. Undersea Hyperb. Med. 2022, 49, 495–505.
21. Wang, R.; Xu, J.; Xie, J.; Kang, Z.; Sun, X.; Chen, N.; Liu, L.; Xu, J. Hyperbaric oxygen preconditioning promotes survival of retinal ganglion cells in a rat model of optic nerve crush. J. Neurotrauma 2010, 27, 763–770.
22. Dollery, C.T.; Bulpitt, C.J.; Kohner, E.M. Oxygen supply to the retina from the retinal and choroidal circulations at normal and increased arterial oxygen tensions. Investig. Ophthalmol. 1969, 8, 588–594.
23. Butler, F.K. Jr.; Hagan, C.; Murphy-Lavoie, H. Hyperbaric oxygen therapy and the eye. Undersea Hyperb. Med. 2008, 35, 333–387.
24. Sayin, O.; Altinkaynak, H. The effects of hyperbaric oxygen therapy on retinal layers in healthy eyes. Undersea Hyperb. Med. 2022, 49, 485–494.
25. Scanlon, P.H.; Nevill, C.R.; Stratton, I.M.; Maruti, S.S.; MassóGonzález, E.L.; Sivaprasad, S.; Bailey, C.; Ehrlich, M.; Chong, V. Prevalence and incidence of diabetic retinopathy (DR) in the UK population of Gloucestershire. Acta Ophthalmol. 2022, 100, e560–e570.
26. Schmidt, I.; Walter, P.; Siekmann, U.; Plange, N.; Koutsonas, A.; Mazinani, B.E.; Kuerten, D. Development of visual acuity under hyperbaric oxygen treatment (HBO) in non arteritic retinal branch artery occlusion. Graefes Arch. Clin. Exp. Ophthalmol. 2020, 258, 303–310.
27. Sellman, A.; Katzman, P.; Andreasson, S.; Lõndahl, M. Long-term effects of hyperbaric oxygen therapy on visual acuity and retinopathy. Undersea Hyperb. Med. 2020, 47, 423–430
28. Shroff, D.; Kothari, A.; Gupta, P.; Sahni, T.K.; Narain, S. Hyperbaric oxygen therapy combined with immunosuppression for acute macular neuroretinopathy in systemic lupus erythematosus. Ocul. Immunol. Inflamm. 2023, 31, 355–361.
29. Wong, T.Y.; Sun, J.; Kawasaki, R.; Ruamviboonsuk, P.; Gupta, N.; Lansingh, V.C.; Maia, M.; Mathenge, W.; Moreker, S.; Muqit, M.M.K.; et coll. Guidelines on diabetic eye care: The international council of ophthalmology recommendations for screening, follow-up, referral, and treatment based on resource settings. Ophthalmology 2018, 125, 1608–1622.
30. Pakola, S.J.; Grunwald, J.E. Effects of oxygen and carbon dioxide on human retinal circulation. Investig. Ophthalmol. Vis. Sci. 1993, 34, 2866–2870.
31. Al-Rawahi, A. Role of hyperbaric oxygen therapy on microvascular diabetic complications and metabolic profile among patients with type 2 diabetes mellitus. Oman Med. J. 2020, 35, e129.
32. Flores, R.; Carneiro, Â.; Neri, G.; Fradinho, A.C.; Quenderra, B.; Barata, M.J.; Tenreiro, S.; Seabra, M.C. Choroidal vascular impairment in intermediate age-related macular degeneration. Diagnostics 2022, 12, 1290.
33. Sidorczuk, P.; Pieklarz, B.; Konopinska, J.; Saeed, E.; Mariak, Z.; Dmuchowska, D. Foveal avascular zone does not correspond to choroidal characteristics in patients with diabetic retinopathy: A Singlesingle-Center center cross-sectional analysis. Diabetes Metab. Syndr. Obes. 2021, 14, 2893–2903.
34. Stoica, S.I.; Bleotu, C.; Ciobanu, V.; Ionescu, A.M.; Albadi, I.; Onose, G.; Munteanu, C. Considerations about hypoxic changes in neuraxis tissue injuries and recovery. Biomedicines 2022, 10, 481.
35. Çevik, S.G.; Bağlı, B.S. Change in the foveal avascular zone and macular capillary network density after hyperbaric oxygen therapy in healthy retina. J. Ophthalmic Vis. Res. 2021, 16, 393–399.
36. Tukenmez Dikmen, N.; Akyol, U.C.; Comerter, D.; Sadik, M.T.; Demir, N.; Sumen, S.G.; Sonmez, M. The effect of hyperbaric oxygen therapy on retina, choroidal thickness, and choroidal vascularity index. Photodiagn Photodyn. Ther. 2022, 38, 102854.
37. https://www.mdpi.com/2077-0383/13/1/29#:~:text=It%20 has%20promising%20effects%20in,these%20 conditions%20by%20regulatory%20authorities
38. Dumitru R. The hyperbaric method in the treatment of diabetic retinopathy, an alternative to laser therapy ? Oftalmologia. 1993;37(1):12-16.
39. Chang Y-H, Chen P-L, Tai M-C, Chen C-H, Lu D-W, Chen J-T. Hyperbaric oxygen therapy ameliorates the blood–retinal barrier breakdown in diabetic retinopathy. Clinical & Experimental Ophthalmology. 2006;34(6): 584-589.
40. Averous K, Erginay A, Timsit J, Haouchine B, Gaudric A, Massin P. Resolution of diabetic macular oedema following high altitude exercise. Acta Ophthalmol Scand. 2006;84(6):830-831.
41. Ogura Y, Kiryu J, Takahashi K, Honda Y. [Visual improvement in diabetic macular edema by hyperbaric oxygen treatment]. Nippon Ganka Gakkai Zasshi. 1988;92(9):1456-1460.
42. Krott R, Heller R, Aisenbrey S, Bartz-Schmidt KU. Adjunctive hyperbaric oxygenation in macular edema of vascular origin. Undersea Hyperb Med. 2000;27(4): 195-204.
43. Maalej A, Khallouli A, Choura R, Ben Sassi R, Rannen R, Gharsallah H. The effects of hyperbaric oxygen therapy on diabetic retinopathy: A preliminary study. J Fr Ophtalmol. 2020;43(2):133-138.
44. Chang, Y.H.; Chen, P.L.; Tai, M.C.; Chen, C.H.; Lu, D.W.; Chen, J.T. Hyperbaric oxygen therapy ameliorates the blood-retinal barrier breakdown in diabetic retinopathy. Clin. Exp. Ophthalmol. 2006, 34, 584–589.
45. Ogura, Y.; Kiryu, J.; Takahashi, K.; Honda, Y. Visual improvement in diabetic macular edema by hyperbaric oxygen treatment. Nippon. Ganka Gakkai Zasshi 1988, 92, 1456–1460.
46. Pfoff, D.S.; Thom, S.R. Preliminary report on the effect of hyperbaric oxygen on cystoid macular edema. J. Cataract. Refract. Surg. 1987, 13, 136–140.
47. Maalej, A.; Khallouli, A.; Choura, R.; Ben Sassi, R.; Rannen, R.; Gharsallah, H. The effects of hyperbaric oxygen therapy on diabetic retinopathy: A preliminary study. J. Fr. Ophtalmol. 2020, 43, 133–138.
48. Kaldırım, H.; Yazgan, S.; Ceylan, B.; Atalay, K. The effect of hyperbaric oxygen therapy on retinal thickness and progression of retinopathy in patients with Type 2 diabetes: A prospective cohort study. Cutan. Ocul. Toxicol. 2019, 38, 233–239.
49. Kiryu, J.; Ogura, Y. Hyperbaric oxygen treatment for macular edema in retinal vein occlusion: Relation to severity of retinal leakage. Ophthalmologica 1996, 210, 168–170.
50. Gün, R.D.; Gümüş, T.; Kardaş, A.S.Y.; Kardaş, G. Acute effect of hyperbaric oxygen therapy on macular and choroidal thickness in patients with type 2 diabetes and diabetic foot ulcers: Optical coherence tomography based study. Photodiagn Photodyn. Ther. 2022, 39, 102926.
51. Aiello, L.P.; Avery, R.L.; Arrigg, P.G.; Keyt, B.A.; Jampel, H.D.; Shah, S.T.; Pasquale, L.R.; Thieme, H.; Iwamoto, M.A.; Park, J.E. Vascular endothelial growth factor in ocular fluid of patients with diabetic retinopathy and other retinal disorders. N. Engl. J. Med. 1994, 331, 1480–1487
52. Hopf, H.W.; Gibson, J.J.; Angeles, A.P.; Constant, J.S.; Feng, J.J.; Rollins, M.D.; Zamirul Hussain, M.; Hunt, T.K. Hyperoxia and angiogenesis. Wound Repair. Regen. 2005, 13, 558–564
53. Sheikh, A.Y.; Gibson, J.J.; Rollins, M.D.; Hopf, H.W.; Hussain, Z.; Hunt, T.K. Effect of hyperoxia on vascular endothelial growth factor levels in a wound model. Arch. Surg. 2000, 135, 1293–1297.
54. Liu, R.; Li, L.; Yang, M.; Boden, G.; Yang, G. Systematic review of the effectiveness of hyperbaric oxygenation therapy in the management of chronic diabetic foot ulcers. Mayo Clin. Proc. 2013, 88, 166–175.
55. Stoekenbroek, R.M.; Santema, T.B.; Legemate, D.A.; Ubbink, D.T.; van den Brink, A.; Koelemay, M.J. Hyperbaric oxygen for the treatment of diabetic foot ulcers: A systematic review. Eur. J. Vasc. Endovasc. Surg. 2014, 47, 647–655.
56. McCartney, P.J.; McCartney, P.W. Vitreous haemorrhage after hyberbaric oxygen therapy. Eye 1994, 8, 705–706.
57. Tran, V.; Smart, D. Proliferative retinopathy during hyperbaric oxygen treatment. Diving Hyperb. Med. 2017, 47, 203.
58. https://eyewiki.org/Hyperbaric_Oxygen_Therapy
59. Kim SH, Cha YS, Lee Y, Kim H, Yoon IN. Successful treatment of central retinal artery occlusion using hyperbaric oxygen therapy. Clin Exp Emerg Med. 2018;5(4):278-281.
60. Cvetkovic M, Jensen P, Jansen E. Diameter variations of retinal blood vessels during and after treatment with hyperbaric oxygen. The British journal of ophthalmology. 2004;88:771-775.
61. Butler FK, Jr. Hagan C, Murphy-Lavoie H. Hyperbaric oxygen therapy and the eye. Undersea Hyperb Med. 2008;35(5):333-387.
62. Landers MB, 3rd. Retinal oxygenation via the choroidal circulation. Trans Am Ophthalmol Soc. 1978;76:528-556.
63. Lin L, Chen T, Wald K, Tooley A, Lisman R, Chiu E. Hyperbaric Oxygen Therapy in Ophthalmic Practice: An Expert Opinion. Expert Review of Ophthalmology. 2020;15.
64. Patyal S. Hyperbaric Chamber and Its Ophthalmic Applications. Delhi Journal of Ophthalmology. 2017;28:43-47.
65. Bagli BS, Çevik SG, Çevik MT. Effect of hyperbaric oxygen treatment in central retinal artery occlusion. Undersea Hyperb Med. 2018;45(4):421-425.
66. Weymouth W, Pedersen C. Central Retinal Artery Occlusion Associated with Carotid Artery Occlusion. Clin Pract Cases Emerg Med. 2019;3(3):233-236.
67. Johnson DR, Cooper JS. Retinal Artery and Vein Occlusions Successfully Treated with Hyperbaric Oxygen. Clin Pract Cases Emerg Med. 2019;3(4):338-340.
68. Hadanny A, Maliar A, Fishlev G, et coll. Reversibility of retinal ischemia due to central retinal artery occlusion by hyperbaric oxygen. Clin Ophthalmol. 2017;11:115-125.
69. Yilmaz H, Durukan AH. Disorganization of the retinal inner layers as a prognostic factor in eyes with central retinal artery occlusion. Int J Ophthalmol. 2019;12(6):990-995.
70. Snyder K, Yazdanyar A, Mahajan A, Yiu G. Association Between the Cilioretinal Artery and Choroidal Neovascularization in Age-Related Macular Degeneration: A Secondary Analysis From the Age-Related Eye Disease Study. JAMA Ophthalmol. 2018;136(9):1008-1014.
71. Beiran I, Goldenberg I, Adir Y, Tamir A, Shupak A, Miller B. Early hyperbaric oxygen therapy for retinal artery occlusion. Eur J Ophthalmol. 2001;11(4):345-350.
72. Takeuchi M, Morita K, Nakatsuka H, et coll. [A case of central retinal artery occlusion after anterior posterior fusion of the lumbar spine]. Masui. 2001;50(8):899-901.
73. Beiran I, Reissman P, Scharf J, Nahum Z, Miller B. Hyperbaric oxygenation combined with nifedipine treatment for recent-onset retinal artery occlusion. Eur J Ophthalmol. 1993;3(2):89-94.
74. Aisenbrey S, Krott R, Heller R, Krauss D, Rössler G, Heimann K. [Hyperbaric oxygen therapy in retinal artery occlusion]. Ophthalmologe. 2000;97(7):461-467.
75. Masters TC, Westgard BC, Hendriksen SM, et coll. Case series of hyperbaric oxygen therapy for central retinal artery occlusion. Retin Cases Brief Rep. 2019.
76. Akil H. Hyperbaric Oxygen Therapy in an Isolated Cilioretinal Artery Occlusion: A Case Report. Advances in Ophthalmology & Visual System. 2015;2.
77. Gokce G, Metin S, Erdem U, et coll. Late hyperbaric oxygen treatment of cilioretinal artery occlusion with nonischemic central retinal vein occlusion secondary to high altitude. High Alt Med Biol. 2014;15(1):84-88.
78. Krott R, Heller R, Aisenbrey S, Bartz-Schmidt KU. Adjunctive hyperbaric oxygenation in macular edema of vascular origin. Undersea Hyperb Med. 2000;27(4): 195-204.
79. Kiryu J, Ogura Y. Hyperbaric oxygen treatment for macular edema in retinal vein occlusion: relation to severity of retinal leakage. Ophthalmologica. 1996;210(3):168-170.
80. Yamada H, Yamada E, Hackett SF, Ozaki H, Okamoto N, Campochiaro PA. Hyperoxia causes decreased expression of vascular endothelial growth factor and endothelial cell apoptosis in adult retina. J Cell Physiol. 1999;179(2):149156.
81. Lin YC, Yang CM, Lin CL. Hyperbaric oxygen treatment in Purtscher's retinopathy induced by chest injury. J Chin Med Assoc. 2006;69(9):444-448.
82. Keynan Y, Yanir Y, Shupak A, Yanir Y. Hyperbaric therapy for bilateral visual loss during hemodialysis. Clinical and experimental nephrology. 2006;10:82-84.
83. Oguz H, Sobaci G. The use of hyperbaric oxygen therapy in ophthalmology. Surv Ophthalmol. 2008;53(2):112-120.
84. Bayer A, Mutiu FM, Sobaci G. Hyperbaric oxygen therapy for mitomycin C-induced scleral necrosis. Ophthalmic Surg Lasers. 2001;32(6):490-493.
85. Patyal S. Hyperbaric Chamber and Its Ophthalmic Applications. Delhi Journal of Ophthalmology. 2017;28:43-47.
86. Price JC, Stevens DL. Hyperbaric oxygen in the treatment of rhinocerebral mucormycosis. Laryngoscope. 1980;90 (5 Pt 1):737-747.
87. Bell S, Mahoney L. Mucormycosis: a case study. Crit Care Nurse. 2000;20 (1):18-23.
88. Ferguson BJ, Mitchell TG, Moon R, Camporesi EM, Farmer J. Adjunctive hyperbaric oxygen for treatment of rhinocerebral mucormycosis. Rev Infect Dis. 1988;10 (3):551-559.
89. Kajs-Wyllie M. Hyperbaric oxygen therapy for rhinocerebral fungal infection. J Neurosci Nurs. 1995;27(3):174-181.
90. Yohai RA, Bullock JD, Aziz AA, Markert RJ. Survival factors in rhino-orbital-cerebral mucormycosis. Surv Ophthalmol. 1994;39(1):3-22.
91. de Smet MD, Carruthers J, Lepawsky M. Anterior segment ischemia treated with hyperbaric oxygen. Can J Ophthalmol. 1987;22(7):381-383.
92. Prockop LD, Grasso RJ. Ameliorating effects of hyperbaric oxygenation on experimental allergic encephalomyelitis. Brain Res Bull. 1978;3 (3):221-225.
93. Jampol LM, Orlin C, Cohen SB, Zanetti C, Lehman E, Goldberg MF. Hyperbaric and Transcorneal Delivery of Oxygen to the Rabbit and Monkey Anterior Segment. Archives of Ophthalmology. 1988;106(6):825-829.
94. Freilich DB, Seelenfreund MH. Long-term follow-up of scleral buckling procedures with sickle cell disease and retinal detachment treated with the use of hyperbaric oxygen. Mod Probl Ophthalmol. 1977;18:368-372.
95. Bojić L, Kovacević H, Andrić D, Romanović D, Petri NM. Hyperbaric oxygen dose of choice in the treatment of glaucoma. Arh Hig Rada Toksikol. 1993;44(3):239-247.
96. Bojić L, Racic G, Gosović S, Kovacević H. The effect of hyperbaric oxygen breathing on the visual field in glaucoma. Acta Ophthalmol (Copenh). 1993;71(3):315-319.
97. Gallin-Cohen PF, Podos SM, Yablonski ME. Oxygen lowers intraocular pressure. Invest Ophthalmol Vis Sci. 1980;19(1):43-48.
98. Guy J, Schatz NJ. Hyperbaric oxygen in the treatment of radiation-induced optic neuropathy. Ophthalmology. 1986;93(8):1083-1088.
99. Borruat FX, Schatz NJ, Glaser JS, Feun LG, Matos L. Visual recovery from radiation-induced optic neuropathy. The role of hyperbaric oxygen therapy. J Clin Neuroophthalmol. 1993;13(2):98-101.
100. Levy RL, Miller NR. Hyperbaric oxygen therapy for radiation-induced optic neuropathy. Ann Acad Med Singap. 2006;35(3):151-157.
101. Bojić L, Ivanisević M, Gosović G. Hyperbaric oxygen therapy in two patients with non-arteritic anterior optic neuropathy who did not respond to prednisone. Undersea Hyperb Med. 2002;29(2):86-92.
102. Arnold AC, Hepler RS, Lieber M, Alexander JM. Hyperbaric oxygen therapy for nonarteritic anterior ischemic optic neuropathy. Am J Ophthalmol. 1996;122(4):535-541.
103. Mathews MK. Nonarteritic anterior ischemic optic neuropathy. Curr Opin Ophthalmol. 2005;16(6):341-345.
104. Skogstad M, Bast-Pettersen R, Tynes T, Bjørnsen D, Aaserud O. [Treatment with hyperbaric oxygen. Illustrated by the treatment of a patient with retinitis pigmentosa]. Tidsskr Nor Laegeforen. 1994;114(21):2480-2483.
105. Vingolo EM, Pelaia P, Forte R, Rocco M, Giusti C, Rispoli E. Does hyperbaric oxygen (HBO) delivery rescue retinal photoreceptors in retinitis pigmentosa ? Doc Ophthalmol. 1998;97 (1):33-39.
106.Malerbi, F.K.; Novais, E.A.; Emmerson, B.; Bonomo, P.P.; Pereira, A.J.; Lottenberg, C.L.; Maia, A. Hyperbaric oxygen therapy for choroidal neovascularization: A pilot study. Undersea Hyperb. Med. 2015, 42, 125–131.



Outre les médicaments conventionnels pour traiter le glaucome, il existe de plus en plus d’options de traitement : la trabéculoplastie, les MIGS et MIBS, la médication soutenue et les implants (endoprothèses).
La trabéculoplastie sélective au laser et la chirurgie incisionnelle permettent de contrôler la PIO à long terme. La trabéculoplastie est un traitement de première intention. La chirurgie incisionnelle est généralement réservée aux patients pour lesquels les autres interventions de contrôle de la PIO ont échoué.
Les procédures MIGS ou « chirurgie micro-invasive du glaucome » constituent un groupe d’interventions chirurgicales qui partagent cinq caractéristiques1 :
Profil de sécurité élevé : Par rapport aux chirurgies incisionnelles traditionnelles, les MIGS présentent un risque beaucoup plus faible de complications graves telles que l’hypotonie, les épanchements choroïdiens ou les hémorragies choroïdiennes.
Perturbation minimale de l’anatomie normale : Les MIGS permettent d’améliorer les mécanismes physiologiques d’écoulement en évitant les altérations majeures de l’anatomie oculaire normale.
Approche ab interno : Les MIGS sont généralement réalisés ab interno au moyen d’une plaie cornéenne claire traditionnelle avec une visualisation directe de la cible anatomique.
Efficacité : Les MIGS doivent offrir un effet significatif de réduction de la PIO. Le niveau de réduction de la PIO est souvent inférieur à celui de la chirurgie filtrante traditionnelle, mais il doit être d’au moins 20 %. Par ailleurs, les patients qui ne bénéficient pas d’une baisse de la PIO doivent obtenir une réduction d’au moins un médicament.
Facilité d’utilisation pour les patients et les médecins : les MIGS devraient permettre un rétablissement rapide avec un minimum de temps d’arrêt supplémentaire pour les patients. Ils doivent également être facilement incorporés dans la chirurgie traditionnelle de phacoémulsification.
Une approche chirurgicale dite ab interno, c’est-à-dire avec un abord chirurgical par l’intérieur de l’œil, peu traumatique2
La voie ab externo(abord externe) requiert une incision de la conjonctive, une dissection plus ou moins importante des structures périoculaires et la création d’un volet scléral afin d’accéder à la chambre antérieure alors que la voie ab interno (abord interne) nécessite une incisioncornéenne3
Trabéculotomie assistée par microcathéter ab interno ou ab externo pour le glaucome congénital primaire avec cornée claire
Importance : Il s’agit de la première comparaison complète entre l’approche ab interno et l’approche ab externo pour la trabéculotomie assistée par microcathéter dans le glaucome congénital primaire avec cornée claire4
Contexte : La trabéculotomie assistée par microcathéter ab externo est considérée comme l’approche de référence pour le glaucome congénital primaire. La nouvelle approche ab interno serait intuitivement similaire à l’approche ab externo pour la trabéculotomie assistée par microcathéter dans les yeux à cornée claire; cependant, il n’y a pas encore de preuves.
Conception : Comparaison non contemporaine de séries de cas rétrospectives.
Participants : Cinquante-huit et cinquante-sept yeux consécutifs atteints de glaucome congénital primaire et ayant une cornée claire ont subi une trabéculotomie assistée par microcathéter ab interno et ab externo, respectivement.
Méthodes : Comparaison rétrospective des résultats cliniques.
Principaux critères d’évaluation : Le succès chirurgical a été défini comme une pression intraoculaire postopératoire de ≤ 21 mmHg avec une réduction d’au moins 30 % par rapport à la PIO préopératoire, avec ou sans utilisation de médicaments antiglaucomateux (succès qualifié et complet, respectivement).
Résultats : Le taux de succès qualifié (87,9 % vs 82,2 %, P = 0,40) et le taux de succès complet (81,0 % vs 73,3 %, P = 0,32) étaient comparables entre les groupes. Les complications étaient minimes et comparables. Une trabéculotomie de moins de 360° (P = 0,009) et un nombre plus élevé d’interventions chirurgicales antérieures (P = 0,03) étaient tous deux associés à de moins bons résultats chirurgicaux. Conclusions et pertinence : L’approche ab interno donne de bons résultats comparables à l’approche ab externo pour la trabéculotomie assistée par microcathéter dans les yeux atteints de glaucome congénital primaire avec une cornée claire. Elle doit être considérée comme le choix initial chez ces patients, car elle permet d’épargner la conjonctive. La réussite de la trabéculotomie avec l’une ou l’autre technique lors de la première tentative est essentielle au succès global et souligne la nécessité de la maîtriser avant de la pratiquer de manière indépendante.
Il existe aussi des chirurgies micro-invasives qui forment des chirurgies filtrantes MIBS (Micro invasive BlebSurgery) (Preserflo, XEN 45 et 63, SPNP, canaloplastie)5. Elles sont sous-conjonctivales et sont moins invasives, plus contrôlées, la récupération visuelle plus rapide après la chirurgie, et crée une bulle diffuse6
Contrairement à l’autre dispositif de cette catégorie, le drain XEN, habituellement inséré ab interno (depuis un abord cornéen de la chambre antérieure), la mise en place du Preserflo se fait par un abord externe, après incision conjonctivale limbique et application sous-ténonienne de mitomycine7
L’administration prolongée de médicaments offre la possibilité d’améliorer l’adhésion au traitement et d’en prolonger la durée en utilisant une voie d’administration qui n’est pas dépendante du patient. Un implant de bimatoprost est disponible depuis 2020 et des données concernant un implant de travoprost inséré chirurgicalement ont été soumises à la FDA en 2023.
L’implant de bimatoprost a été le premier traitement à libération prolongée approuvé par la FDA pour réduire la PIO chez les patients atteints d’OAG ou d’HTO8,9. Les implants biodégradables intracaméraux, conçus pour libérer le bimatoprost pendant 3 à 4 mois, ont été examinés dans les études ARTEMIS-1 et ARTEMIS-2 de phase 3 d’une durée de 20 mois10,11. Les patients atteints d’OAG ou d’OHT dans les deux yeux ont été répartis au hasard pour recevoir un implant de bimatoprost de 10 ou 15 μg administré le jour 1, la semaine 16 et la semaine 32 ou des gouttes oculaires de timolol administrées deux fois par jour10,11. La procédure d’implantation pouvait être effectuée dans un centre de chirurgie ambulatoire ou dans un cabinet, à la discrétion de l’investigateur.
Après préparation de l’œil avec un antibiotique et un anesthésique topiques, l’implant est injecté par voie intracamérulaire à l’aide de l’applicateur prérempli breveté (Figure 1)11. Les critères d’évaluation primaires étaient la PIO et le changement de la PIO entre le début de l’étude et la semaine 12.
Figure 1. Système d’injection de l’implant Bimatoprost

Les deux doses de l’implant de bimatoprost étaient non inférieures au timolol à 12 semaines10,11. Parmi les patients des études ARTEMIS-1 et ARTEMIS-2 ayant reçu la dose de 10 μg, 84,3 % et 77,5 %, respectivement, n’ont pas eu besoin d’un traitement de secours pour abaisser la PIO au bout de 52 semaines. Bien que le dernier implant ait été administré à la semaine 32, environ 70 % des patients n’ont pas eu besoin d’un traitement de secours un an après la troisième implantation10,11. Cette observation paradoxale suggère qu’il est peu probable que la présence continue du médicament en soit la cause, car le bimatoprost est complètement libéré au bout de 3 à 4 mois. Une théorie plausible suggère que les caractéristiques du bimatoprost délivré par l’implant peuvent avoir un effet durable sur le remodelage tissulaire des voies d’écoulement aqueux induit par la métalloprotéinase matricielle11,12
Au cours des études ARTEMIS, la taille des implants visibles par rapport à leur taille initiale a été estimée à l’aide de la gonioscopie13. Parmi les 372 patientes ayant reçu l’implant de 10 μg, la biodégradation a varié à chaque point dans le temps47. Les implants ont souvent augmenté jusqu’à 200 % de leur taille initiale au cours de la phase précoce de biodégradation (2 à 28 semaines). À 12 semaines, plus d’un tiers des implants étaient 101 % à 150 % (27,1 %) ou 151 % à > 200 % (11,0 %) plus grands que leur taille initiale (Figure 2)47. La biodégradation s’est également produite pendant cet intervalle, 50,7 % des implants étant estimés ≤ 75 % et 33,0 % étaient ≤ 50 % de leur taille initiale à 28 semaines. Une biodégradation de 0 à ≤ 25 % de la taille initiale a été rapportée pour 12,3 % des implants à 28 semaines. La biodégradation s’est accélérée entre les semaines 31 et 52, 82,1 % des implants étant absents ou ≤ 25 % de leur taille initiale à la semaine 5212. La biodégradation lente a permis la présence de 3 implants simultanés dans certains yeux13
Figure 2. Distribution de la taille des implants en fonction du temps écoulé après l’administration

Les patients ont reçu un implant de bimatoprost de 10 μg au jour 1 dans les études ARTEMIS. Lors de l’examen gonioscopique des visites de suivi, la taille de l’implant a été estimée et classée en fonction du pourcentage de la taille initiale. Les résultats présentés sont basés sur les valeurs observées (n = 230 à la semaine 2). Source : Weinreb RN, et coll.12 Accès libre sous licence Creative Commons BY.
Les effets indésirables sur la cornée étaient plus fréquents dans le groupe recevant l’implant à dose plus élevée et après des administrations répétées11,12. Compte tenu de la durée prolongée inattendue du contrôle de la PIO après la dernière implantation, des études en cours évaluent la sécurité et l’efficacité de l’administration en cas de besoin afin de mieux comprendre la biodégradation de l’implant et le moment idéal de la réimplantation13
Un implant expérimental en titane libérant du travoprost est inséré chirurgicalement dans le réseau trabéculaire et fixé à l’aide d’un ancragescléral14,15. La procédure consiste à pratiquer une incision de 2,2 mm et à remplir la chambre antérieure d’un viscoélastique cohésif. Une formulation brevetée de travoprost a une durée de vie ciblée de 6 à 12 mois. Le dispositif peut être remplacé en toute sécurité par un nouveau dispositif après 4 à 5 ans. Dans une étude de phase 2 b, 70 %, 68 % et 46 %, respectivement, des patients recevant un implant à libération rapide, un implant à libération lente et faisant partie des groupes de contrôle au timolol, avaient une PIO bien contrôlée à 36 mois, en utilisant le même nombre ou moins de médicaments topiques qu’au moment de la sélection15
Deux essais pivots parallèles de phase 3 ont examiné la sécurité et l’efficacité des implants en titane à élution lente et rapide par rapport au timolol16. Les données relatives aux implants à élution lente (n = 383) et aux témoins sous timolol (n = 386) ont montré que les implants n’étaient pas inférieurs au timolol16 pour ce qui est de l’abaissement de la PIO à 3 mois. À 12 mois, 93 % des patients ayant reçu l’implant et 67 % des patients ayant reçu le timolol étaient bien contrôlés avec le même nombre ou moins de traitements topiques réduisant la PIO par rapport à la situation de départ16. La plupart (81 %) des patients ayant reçu l’implant n’utilisaient pas de médicaments topiques à 12 mois16. Un profil de sécurité très favorable a été observé. Les données de la phase 3 ont été soumises à la FDA en février 2023, accompagnées de données de sécurité supplémentaires provenant d’un essai d’échange dans lequel le dispositif d’origine a été retiré chirurgicalement et un second dispositif a été implanté17
La FDA donne son feu vert à un implant destiné à traiter l’hypertension oculaire et le glaucome (décembre 2023)
Un seul implant de travoprost s’est avéré non inférieur au timolol en collyre, avec une bonne sécurité18
L’implant est conçu pour fournir un traitement de longue durée pour « toute la gamme de sévérité de la maladie du glaucome », selon une déclaration de la Société. L’implant libère l’analogue de prostaglandine travoprost, qui est déjà approuvé pour les deux affections oculaires18
« Avec la nouvelle génération de solutions pharmaceutiques procédurales pour le glaucome telles que l’iDose TR, nous disposons désormais d’un nouvel outil qui permettra de faire face à l’ancienne pratique standard consistant à se fier aux gouttes topiques, qui sont connues pour provoquer des effets secondaires désagréables et présenter une myriade de défis tels que l’adhésion au traitement, les schémas posologiques complexes et la difficulté de l’auto-administration », a déclaré John Berdahl, MD, de Vance Thompson Vision, à Sioux Falls, dans le Dakota du Sud, dans le communiqué de Glaukos. « Les données cliniques suggèrent qu’iDose TR est non seulement efficace avec un profil de sécurité favorable, mais qu’il a le potentiel de soulager les patients du fardeau des gouttes ophtalmiques prescrites pendant une période prolongée ».

La FDA a approuvé l’implant intracaméral de travoprost (iDose TR) pour le traitement de l’hypertension oculaire et du glaucome, a annoncé le développeur du dispositif Glaukos18
L’autorisation a été principalement étayée par deux essais randomisés de phase III qui ont démontré la non-infériorité de l’implant par rapport au timolol en collyre. Les patients randomisés pour recevoir l’implant ont présenté une diminution de la pression intraoculaire (PIO) entre le début de l’étude (moyenne de 24 mm Hg) et 90 jours : de 6,6 à 8,5 mm Hg dans un essai et de 6,7 à 8,4 mm Hg dans le second. Le collyre timolol a permis des réductions de 6,6-7,7 mm Hg et de 6,8-7,2 mm Hg dans les essais.
Lors d’une présentation à la réunion de l’American Society of Cataract and Refractive Surgery, M. Berdahl a déclaré que 90 % du groupe ayant reçu l’implant avaient une PIO bien contrôlée à 12 mois, contre 67 % du groupe ayant reçu le timolol. Le dispositif présentait un profil de sécurité favorable, notamment de faibles taux d’hyperémie conjonctivale, aucune perte de cellules endothéliales cornéennes, aucun événement indésirable cornéen grave et aucun événement indésirable d’atrophie de la graisse périorbitaire. L’implant a pu être remplacé sans qu’une perte significative de cellules endothéliales n’ait été constatée.
Selon la déclaration de la société, une seule administration de l’implant a permis de maintenir le contrôle de la PIO pendant une période pouvant aller jusqu’à 36 mois. La société a l’intention de commencer à vendre l’implant au cours du premier trimestre 2024 à un coût d’acquisition en gros estimé à 13 950 $ (!) par implant.
Il y a d’abord les procédures de base19 :
Thérapie au laser : La trabéculoplastie au laser est une option si le patient ne supporte pas les gouttes oculaires. Elle peut également être utilisée si les médicaments n’ont pas ralenti la progression de la maladie. On peut également recommander une chirurgie au laser avant d’utiliser des gouttes oculaires. On utilise un petit laser pour améliorer le drainage du tissu situé à l’angle où l’iris et la cornée se rencontrent. Il peut s’écouler quelques semaines avant que l’effet de cette procédure ne soit pleinement visible.
Chirurgie filtrante : Il s’agit d’une intervention chirurgicale appelée trabéculectomie. Le chirurgien crée une ouverture dans la sclérotique. L’opération crée un autre espace pour que le liquide s’écoule de l’œil.
La trabéculoplastie sélective au laser est une option de traitement de première intention du glaucome selon plusieurs lignes directrices de pratique clinique, y compris le modèle de pratique préférée 2020 de l’American Academy of Ophthalmology pour le glaucome primaire à angle ouvert20. Cependant, la TSL est rarement utilisée en tant que traitement de première intention dans la pratique clinique. Dans une base de données administratives sur la santé portant sur 18 161 patients atteints de glaucome et ayant entamé un traitement, 3,5 % ont subi une trabéculectomie et 0,4 % une trabéculoplastie en tant que traitement de première intention.
L’étude LiGHT, d’une durée de 36 mois, a réparti de manière aléatoire des patients non traités, nouvellement diagnostiqués et atteints de GPAO ou d’HTO, entre la TSL (n = 356) et un traitement topique par gouttes oculaires (n = 362)21 Après 36 mois, les scores de qualité de vie liée à la santé étaient similaires entre les groupes, et 74,2 % des patients ayant reçu la TSL n’ont pas eu besoin de gouttes oculaires pour maintenir la PIO cible21. La proportion plus importante de patients n’ayant pas besoin de gouttes, comparée à celle fréquemment observée dans d’autres études sur la TSL, serait liée au fait que les patients de l’étude LiGHT étaient naïfs de traitement et souffraient d’un glaucome nouvellement diagnostiqué. Les auteurs ont conclu que la TSL devrait être proposée comme traitement de première intention du glaucome, offrant une alternative rentable aux gouttes ophtalmiques quotidiennes21
Un suivi plus long en pratique clinique a été rapporté dans une étude rétrospective qui a examiné les résultats à 5 ans après la TSL dans 51 yeux de 39 patients54. Une intervention chirurgicale ultérieure a été effectuée dans 49 % des yeux après une moyenne de 33,6 ± 20,0 mois22 Le nombre moyen de médicaments contre le glaucome a augmenté de façon significative à 5 ans par rapport à l’utilisation avant la TSL. La progression de l’écart moyen du champ visuel et l’écart type du schéma ont augmenté de façon significative, avec un amincissement substantiel de la couche de fibres nerveuses rétiniennes du quadrant inférieur tel qu’évalué par la tomographie par cohérence optique22
La chirurgie incisionnelle du glaucome, y compris la trabéculectomie et les dérivations aqueuses, est traditionnellement utilisée pour traiter le glaucome réfractaire au contrôle médical de la PIO20. Les dérivations aqueuses sont généralement réservées aux patients chez qui la trabéculectomie a échoué ou est considérée comme ayant peu de chances de réussir. La chirurgie mini-invasive du glaucome comprend un groupe d’interventions réalisées par une approche ab interno avec un traumatisme minimal du tissu oculaire. Certaines des procédures mini-invasives approuvées par la FDA nécessitent une chirurgie de la cataracte concomitante.
Le principe de la thérapie, quelle que soit la modalité, est d’appliquer la quantité minimale de traitement nécessaire pour obtenir la thérapie maximale souhaitée avec un minimum d’effets indésirables. Comme l’ont prouvé de nombreuses études, le traitement a un effet dose-réponse.
Dans l’étude de Nagar et coll.23, le traitement TSL à 90° a produit des taux de réussite plus faibles que le traitement TSL à 180 ou 360°; les taux de réussite plus élevés avec le traitement TSLà 360° par rapport au traitement TSL à 180° n’ont pas atteint le niveau de signification statistique; la douleur oculaire, mais non l’inflammation de la chambre antérieure ou le taux de pics de PIO, étaient plus élevés dans les yeux recevant un traitement TSL à 360° par rapport à un traitement TSLà 90°.
Chen et coll.24 ont mené un essai prospectif randomisé pour comparer deux schémas de TSL :TSL avec 25 spots laser sur 90°du trabeculum (TM) et SLT avec 50 spots laser sur 180° du TM chez 64 sujets présentant un OAG non contrôlé malgré 2 ou 3 médicaments abaissant la PIO dans un essai prospectif. 1, 4 et 7 mois après le traitement, la réduction moyenne de la PIO (environ 5-6 mm Hg) et le taux d’échec nécessitant un retraitement ou une chirurgie incisionnelle (environ 38 % à 4 mois et 45 % à 7 mois) étaient identiques dans les deux groupes. Aucun événement indésirable n’a été rapporté dans les deux groupes.
Song et coll.25 ont réalisé une étude rétrospective des dossiers de traitements TSL; 94 yeux de 94 patients ont été inclus. La majorité (83/92, 90 %) a subi une TSL de 180°. Un suivi de six mois a été effectué. L’échec de la TSL a été défini de deux façons : (1) diminution de la PIO de 3 mm Hg (première définition), ou (2) diminution de la PIO de 20 % (deuxième définition), lors de deux visites successives 4 semaines après la TSL. Selon la première définition, 64 yeux au total (68 %) ont échoué. Selon la deuxième définition, 70 yeux au total (75 %) ont échoué. À la fin de l’étude (14,5 mois), les taux d’échec étaient de 86 et 92 % pour la définition 1 et 2 respectivement, et les taux d’échec globaux de 68 à 74 %.
Prasad et coll.26 ont effectué une étude rétrospective des dossiers des patients afin de déterminer et de comparer l’effet d’un traitement TSL à 180° et à 360° en tant que thérapie primaire sur la fluctuation de la pression intraoculaire entre les visites, et ce, chez des patients souffrant d’hypertension oculaire et de glaucome primaire à angle ouvert ayant reçu uneTSL en tant que thérapie primaire sans aucune intervention médicale ou chirurgicale subséquente et qui ont été suivis pendant une période de 2 ans. Quarante et un yeux ont été traités par TSL, 19 yeux dans le groupe 180° et 22 yeux dans le groupe 360°. La réduction moyenne de la PIO à 2 ans était de 28 % dans le groupe 180° et de 35 % dans le groupe TSL 360°. Après la TSL, le groupe TSL 360° présentait une fluctuation de la PIO plus faible que le groupe TSL 180° au cours de la période de suivi allant du 6e au 24e mois. Cette étude suggère que la TSL à 360° est plus efficace pour obtenir des fluctuations de PIO plus faibles que le traitement par TSL à 180°.
Ayala et coll.27 ont effectué une étude rétrospective des dossiers des yeux ayant subi une TSL. La mesure de résultat primaire était le délai d’échec après le traitement par TSL, 120 yeux de 120 patients ont été identifiés. Le délai moyen d’échec après la TSL était de 18 mois. Le taux de réussite après 12 mois était de 62 %, après 24 mois de 34 %, après 36 mois de 28 % et après 48 mois de 24 %. Les effets à long terme de la TSL, lorsque les yeux ont été traités à plus de 90°, semblent faibles. Ils recommandent de traiter les patients à plus de 180°.
Les chirurgies minimalement invasives pour le glaucome sont de plus en plus nombreuses et de nouvelles procédures seront constamment créées. Les MIGS sont vraiment un sujet chaud et les chirurgiens n’auront qu’à bien se tenir !
Nous avons vu précédemment qu’il y a deux approches chirurgicales : une approche par l’intérieur de l’œil dite ab interno (abord interne), c’est-à-dire avec un abord chirurgical par l’intérieur de l’œil, peu traumatique2, et la voie ab externo (abord externe) qui requiert une incision de la conjonctive, une dissection plus ou moins importante des structures périoculaires et la création d’un volet scléral afin d’accéder à la chambre antérieure3
Chaque approche chirurgicale va utiliser trois voies différentes de l’œil : la sous-conjonctive, le canal de Schlemm et la voie suprachoroïdienne.
On place souvent l’implant Xen dans la procédure ab interno mais il peut aussi être posé selon la procédure ab externo
Trois modèles de Xen ont été initialement conçus28, avec des diamètres de lumière interne de 45, 63 et 140 μm pour différents niveaux de contrôle de la PIO. Le plus petit, XEN45, a été approuvé par la FDA en 2016 et est ci-après appelé Xen29. La longueur du tube de 6 mm est adaptée au passage de la CA, à travers le réseau trabéculaire et la sclérotique, et dans l’espace sous-conjonctival à une distance optimale du limbe30. Le diamètre externe du Xen est de 150 μm et le diamètre interne de 45 μm. L’implantation du Xen est réalisée à l’aide d’un inserteur stérilisé à une main contenant une aiguille 27G préchargée d’une endoprothèse en gélatine31
L’endoprothèse en gel Xen (Allergan inc., CA, É.-U.) est un tube flexible hydrophile29 de 6 mm avec une lumière de 45 microns. L’implant est composé de gélatine dérivée de collagène porcin réticulée avec du glutaraldéhyde30, qui est non inflammatoire32 et provoque une réponse extraoculaire fibrotique ou vasculaire minimale au matériau de l’implant33. Le Xen diminue la PIO en créant une dérivation permanente de la chambre antérieure (CA) vers l’espace sous-conjonctival à travers un canals cléral29. Le dispositif s’hydrate dans les 1 à 2 minutes suivant le contact avec l’humeur aqueuse, se plie et se conforme aux tissus30 Cette flexibilité atténue de nombreux problèmes liés aux matériaux synthétiques tels que la migration, l’érosion et les lésions de l’endothélium cornéen32
La conception de l’endoprothèse en gel Xen repose sur les principes de la dynamique des fluides laminaires. L’équation de Hagen-Poiseuille a été utilisée pour calculer les dimensions internes requises d’un tube qui (1) empêcherait l’hypotonie à une production moyenne d’humeur aqueuse de 2-3 μl/min et (2) fournirait un plancher de PIO à l’état stable d’environ 6-8 mm Hg. En effet, la résistance au flux primaire du tube lui-même est conçue pour prévenir l’hypotonie33,34,38


La conjonctive nasale supérieure est marquée 2,5 à 3,0 mm après le limbe. De la mitomycine C (MMC) est injectée en peropératoire en sous-conjonctival afin de réduire la formation de tissu cicatriciel postopératoire. Des incisions cornéennes claires (principales et latérales) sont créées et la chambre antérieure est remplie d’un viscoélastique cohésif. L’aiguille est insérée par l’incision cornéenne principale et dirigée à travers la chambre antérieure (CA) vers le quadrant supra-nasal. Un goniolens peut être utilisé pour évaluer le positionnement dans l’angle, l’idéal étant d’entrer juste au-dessus du réseau trabéculaire pour éviter les saignements et rester à l’écart de l’iris et de l’endothélium. L’aiguille est avancée à travers la sclérotique dans l’espace sous-conjonctival, tandis que l’œil est stabilisé à l’aide d’un second instrument dans l’incision de l’orifice latéral. Une fois que le biseau est clairement visualisé sortant de la sclérotique dans l’espace sous-conjonctival, l’endoprothèseen gel est libérée et l’injecteur est retiré de l’œil. Environ 1 mm de l’implant reste dans la CA, 3 mm traversent la paroi sclérale et 2 mm émergent sous la conjonctive. Le viscoélastique est ensuite éliminé de la chambre antérieure par lavage, ce qui crée un saignement précoce et confirme la perméabilité du dispositif.
La pose ab externo peut être réalisée avec ou sans dissection conjonctivale. Dans la première technique, une approche ab externo fermée, la conjonctive est déplacée vers l’avant et l’aiguille perce la sclérotique à 2,5 mm du limbe et traverse la sclérotique avant de pénétrer dans la CA, où l’endoprothèse est ensuite libérée. La MMC est injectée par voie sous-conjonctivale avant ou après l’implantation.
Si la conjonctive est ouverte, l’endoprothèse est déployée à 2,5 mm du limbe et la MMC peut être appliquée soit par des éponges imbibées, soit par injection sous-conjonctivale. Après confirmation de la mise en place du dispositif, la conjonctive et la couche de Tenon sont suturées de manière étanche.
Dans les deux techniques ab externo, la mise en place dans la chambre antérieure est confirmée par visualisation gonioscopique, et l’endoprothèse peut être délicatement repositionnée à l’aide d’une pince de ligature coudée si l’endoprothèse est trop courte ou trop longue dans la chambre antérieure. Ce repositionnement de l’endoprothèse peut être effectué à travers la conjonctive, si une technique fermée est employée.
Par rapport à la mise en place ab interno, la mise en place ab externo évite la nécessité d’une injection de viscoélastique et permet un positionnement plus précis du dispositif35 Cependant, de nombreuses études ont démontré que l’implantation par l’approche ab externo pouvait réduire le taux d’aiguilletage à 11,8 %37-40
Profil d’efficacité et de sécurité avec le dispositif Xen
Le Xen a été introduit relativement récemment et les résultats à long terme n’ont donc pas encore été publiés. Des études avec un suivi d’un an ont montré qu’il était efficace pour abaisser la PIO de manière significative et réduire le nombre de médicaments hypotenseurs utilisés, avec un minimum de complications ou d’effets secondaires graves30. La plupart des études documentent une réduction de la PIO de > 29 % (supérieure à la réduction démontrée par la phacoémulsification isolée chez les patients atteints de glaucome primaire à angle ouvert) et une réduction significative du nombre de médicaments pour abaisser la PIO.
Dans la méta-analyse mentionnée ci-dessus de Chen et coll., la différence moyenne de PIO avant et après le Xen était de -7,80 (-8,21, -7,38; p < 0,00001) et de -8,35 (-9,82, -6,88; p < 0,00001) lorsqu’elle était combinée à la phacoémulsification. Le nombre moyen de gouttes a diminué de -1,97 (-2,19, -1,75; p < 0,00001) lorsque le xen a été effectué seul, et de -1,86 (-2,11, -1,60; p < 0,00001) lorsqu’il a été combiné à la phacoémulsification41 Grover et coll. ont évalué l’effet d’abaissement de la PIO et la sécurité de l’endoprothèseen gel de Xen chez des patients atteints de glaucome réfractaire (échec d’un filtrage ou d’une procédure cycloablative et/ou PIO non contrôlée par un traitement médical maximalement toléré)42. Chez 76,3 % des patients, on a observé une réduction ≥ 20 % de la PIO avec un nombre de médicaments identique ou inférieur. La consommation moyenne (SD) de médicaments est passée de 3,5 (1) au départ à 1,7 (1,5) après 12 mois de suivi. La probabilité de réussite à 12 mois était de 75 % (analyse de Kaplan-Meier). La récupération visuelle après l’opération a été rapide, la plupart des patients n’ayant pas changé de vision ou ayant amélioré leur BCVA. Cette étude démontre clairement l’efficacité et le bon profil de sécurité de l’endoprothèse en gel de Xen dans le glaucome réfractaire.
Dans Galal et coll., 13 yeux atteints de glaucome primaire à angle ouvert ont subi une implantation du dispositif Xen avec de la mitomycine C (MMC) sous-conjonctivale43. Un succès complet (réduction de la PIO ≥ 20 % par rapport à la ligne de base préopératoire à 1 an sans aucun médicament contre le glaucome) a été obtenu chez 41,7 % des patients, tandis que le taux de succès qualifié (réduction de la PIO de ≥ 20 % à 1 an avec des médicaments) était de 66,7 %. La réduction de la PIO à 12 mois était de 16 ± 4 à 12 ± 3 mm Hg (p ≤ 0,01) et la réduction des médicaments à 12 mois était de 1,9 ± 1 à 0,3 ± 0,49 (P = 0,003).
Dans un essai prospectif non randomisé réalisé par De Gregorio et coll., 41 yeux de 33 patients ont subi une procédure d’endoprothèseen gel Xen combinée à une chirurgie de la cataracte44. Les résultats de cette étude ont montré que l’implantXEN45 était statistiquement efficace pour réduire la PIO et les médicaments après 12 mois. Le taux de succès complet (≤ 18 mmHg sans médicaments) après 12 mois a été atteint dans 80,4 % (33 yeux sur 41) et un succès qualifié (≤ 18 mmHg avec médicaments) dans 97,5 % (40 yeux sur 41). La réduction de la PIO à 12 mois était de 22,5 ± 3,7 à 13,1 ± 2,4 mmHg (p < 0,05) et la réduction des médicaments à 12 mois était de 2,5 ± 0,9 à 0,4 ± 0,8 (p < 0,05).
Dans le cadre d’un essai prospectif, multicentrique et non randomisé, Reitsamer et coll. ont fait état d’un suivi à 24 mois de 174 yeux (79,8 % des 218 yeux initialement inscrits)45. Parmi eux, 65,8 % ont obtenu un succès complet, défini comme une réduction ≥ 20 % de la PIO sans intervention chirurgicale secondaire. 48,4 % ont obtenu une réduction ≥ 30 % de la PIO sans intervention chirurgicale secondaire. 41,1 % des yeux ont subi au moins une piqûre. Cette étude comprenait à la fois des implantations du dispositif X en autonomes et des implantations du dispositif X en combinées à une phacoémulsification, et les résultats étaient similaires pour ces deux groupes de traitement. Dans une étude rétrospective multicentrique réalisée par le même groupe, l’efficacité et la sécurité à trois ans de l’implantation ab interno ont été évaluées. Les résultats ont montré que la PIO moyenne est passée de 20,7 mm Hg avec 2,5 médicaments au départ à 13,9 mm Hg avec 1,1 médicament. Les résultats semblaient comparables lorsque l’implantation était réalisée avec ou sans pseudoémulsification. Cependant, 7,1 % des yeux ont présenté des complications préopératoires, 14,6 % ont subi 46 événements indésirables postopératoires et 12,3 % ont nécessité une intervention chirurgicale secondaire46
Dans une étude prospective multicentrique, Lenzhofer et coll. ont rapporté les résultats à 4 ans de 64 yeux ayant reçu la micro-endoprothèse XEN63 Gel pour le traitement d’un glaucome à angle ouvert non contrôlé47. La PIO de base moyenne avec un traitement médical optimal avant l’implantation du Xen était de 22,5 ± 4,2 mmHg (n = 34, p < 0,001). Quatre ans après l’implantation du Xen, la PIO moyenne était de 13,4 ± 3,1 mmHg, soit une diminution de 40 % par rapport à la ligne de base. 25 % (12/53) des yeux ont obtenu un succès chirurgical complet après 4 ans et 53 % (28/53) ont obtenu un succès qualifié. 53,1 % des yeux ont subi un traitement par aiguilles. La généralisation des résultats est limitée, car la MMC n’a pas été utilisée et le dispositif étudié est plus long que le XEN45 approuvé par la FDA.
Les premières études comparant les résultats des techniques ab interno et ab externo font état de profils de sécurité et d’efficacité similaires, y compris d’incidences similaires de révision de saignée et de chirurgie secondaire48 L’approche ab externo semble être privilégiée dans la littérature en raison de ses taux légèrement plus élevés de réduction de la PIO et des médicaments contre le glaucome. Des études de cohortes rétrospectives multicentriques récentes ont révélé un pourcentage significativement plus élevé de réduction de la PIO à 12 mois dans le groupe conjonctival ouvert ab externo par rapport au groupe conjonctival fermé ab interno (43,1 % contre 24,8 %, respectivement; P = 0,02). Les taux d’aiguillage postopératoire étaient également plus élevés dans le groupe ab externo que dans le groupe ab interno (36,1 % contre 11,8 %, P = 0,001)49
On peut exercer un pontage du réseau trabéculaire par la pose d’une endoprothèse.
Le réseau trabéculaire étant considéré à l’origine comme le principal site de résistance à l’écoulement de l’humeur aqueuse, le fait de contourner cette structure et de diriger le flux aqueux de la chambre antérieure directement dans le canal de Schlemm semblait être une approche raisonnable50, 51. Il existe actuellement plusieurs dispositifs MIGS pour le canal de Schlemm : l’iStent®, l’iStent inject®, l’iStent inject® W et l’Hydrus® Microstent. Ils sont tous insérés par une approche ab interno, sous vue gonioscopique. Nous discuterons de plus de la trabéculotomie transluminale assistée par gonioscopie (GATT) et des procédures OMNI. L’iStent de première génération (Glaukos Corporation, Californie, États-Unis) est un dispositif en titane recouvert d’héparine, en forme de « L », qui, par une incision ab interno et à l’aide d’un inserteur préchargé, est placé à travers le réseau trabéculaire dans le canal de Schlemm. La partie canalaire de l’iStent, conçue pour s’insérer dans le canal de Schlemm, est un demi-tuyau ouvert qui contient une face convexe incurvée reposant sur la paroi interne du canal. Perpendiculairement à cette partie, il y a un petit « tuba » tubulaire orienté vers la chambre antérieure, qui sert de conduit pour que l’eau contourne la paroi interne du canal de Schlemm et le réseau trabéculaire, augmentant ainsi le débit52, 53, 54. En général, l’implantation de l’iStent est associée à un bon profil de sécurité, la complication la plus fréquente étant un hyphéma transitoire. La malposition et l’obstruction de l’endoprothèse peuvent également se produire, ce qui est souvent résolu par une intervention au laser ou, en dernier ressort, par le retrait et le remplacement de l’implant. Aucun rapport n’a encore fait état de complications graves telles que l’épanchement choroïdien, l’hypotonie persistante, la formation de bulles ou l’endophtalmie55. En outre, il a été prouvé que la mise en place de plusieurs iStent dans le même œil avait un effet additif sur la baisse de la PIO.
C’est pourquoi un iStent de deuxième génération a été mis au point, appelé iStent inject (Glaukos Corporation, Californie, États-Unis).

L’iStent® de première génération, montrant sa pointe autotrempante qui est insérée dans le canal de Schlemm par une technique de glissement latéral, ses arcs de rétention qui aident à maintenir le dispositif en position, et sa lumière qui fait face à la chambre antérieure; image reproduite avec l’aimable autorisation de Glaukos Corporation.
L’iStent inject est plus petit et de forme conique, également en titane recouvert d’héparine55. Contrairement à l’iStent précédent, ce dispositif est administré par auto-injection, ce qui permet d’introduire jusqu’à deux dispositifs dans le canal de Schlemm à l’aide d’un seul injecteur. Cela permet au chirurgien d’injecter deux iStents tout en ne pénétrant qu’une seule fois dans l’œil, réduisant ainsi la durée de l’intervention et le risque d’effets indésirables.
Plus récemment, une nouvelle version de l’iStent inject de deuxième génération, l’iStent inject W, a été mise au point, avec une large collerette à sa base pour optimiser la visualisation et la mise en place de l’endoprothèse. Le diamètre de la collerette est passé de 230 à 360 microns. Ce dispositif a reçu l’approbation de la FDA en 202058

L’iStent inject® de deuxième génération, montrant sa tête contenant quatre orifices latéraux et conçue pour s’insérer dans le canal de Schlemm, et sa collerette avec une lumière d’entrée qui fait face à la chambre antérieure, comme illustré dans la figure de droite56, 57; images reproduites avec l’aimable autorisation de Glaukos Corporation.

L’iStent inject® W, avec son diamètre de bride plus grand que celui de la version précédente iStent inject®58; image reproduite avec l’aimable autorisation de Glaukos Corporation.
La micro-endoprothèse Hydrus (Ivantis, inc. Californie, États-Unis) est un implant en forme d’échafaudage inséré ab interno dans le canal de Schlemm pour maintenir le canal ouvert, améliorant ainsi l’écoulement trabéculaire59 Il est flexible par nature et se compose de nitinol, un alliage de nickel et de titane biocompatible. Il est ouvert postérieurement sur toute sa longueur et possède trois fenêtres ouvertes sur sa surface antérieure. Grâce à ce dispositif, le canal de Schlemm peut être dilaté jusqu’à quatre ou cinq fois la section naturelle du canal et sur un quart de sa longueur, ce qui permet de cibler plusieurs canaux collecteurs. Cependant, l’implantation de ce dispositif est également plus difficile que celle d’autres dispositifs MIGS pour le canal de Schlemm52,53. L’implant Hydrus est généralement sûr et les complications sont peu fréquentes. Comme pour toutes les autres approches ab interno, la complication la plus fréquemment rapportée est un hyphéma transitoire54,55 Une étude comparant lamicro-endoprothèse Hydrus à deux implants iStent inject a révélé que, bien que les résultats de PIO et le profil de sécurité soient similaires entre les deux dispositifs, l’implantation de la micro-endoprothèse Hydrus a plus souvent réduit le besoin de médicaments postopératoires contre le glaucome. Cependant, d’autres études sont nécessaires pour valider ces résultats et prouver l’efficacité de ces implants60

Microstent Hydrus®, montrant ses trois fenêtres ouvertes le long de sa surface antérieure et sa mise en place dans l’œil (figure de droite)53, 61; images reproduite savec l’aimable autorisation d’Ivantis inc.
Le PRESERFLO MicroShunt (Santen, Osaka, Japon), anciennement connu sous le nom de InnFocus MicroShunt, est un tube flexible fabriqué à partir d’un matériau hautement biocompatible et bioinerte appelé poly (styrène-bloc-isobutylène-bloc-styrène), ou SIBS. À mi-chemin de la micro dérivation se trouve une ailette de 1,1 mm d’envergure qui repose dans une poche peu profonde de la sclérotique, ce qui empêche la migration du dispositif dans la chambre antérieure et contribue à réduire au maximum les fuites aqueuses autour du tube53, 61, 6. Le matériau SIBS à partir duquel cet implant est fabriqué est biostable et sa nature inerte provoque une inflammation et une formation de tissu cicatriciel minimales. Des études initiales sur des yeux de lapin comparant la réponse des tissus aux tubes SIBS et aux tubes en silicone ont indiqué que le caoutchouc de silicone stimule l’inflammation et favorise le développement d’une capsule fibrotique autour du dispositif qui devient rapidement non fonctionnel, tandis que les tubes SIBS ont démontré une encapsulation minimale avec un écoulement aqueux continu après 1 an53, 62
L’inflammation sous-conjonctivale induite par le silicone a été rapportée dans d’autres études63. Les résultats d’un essai clinique récemment achevé évaluant la sécurité et l’efficacité du MicroShunt PRESERFLO indiquent que le dispositif est capable de réduire de manière significative la PIO chez les patients atteints de glaucome léger à sévère, et de maintenir des niveaux de PIO sains à long terme. Les complications associées à ce dispositif sont généralement transitoires et spontanément résolutives, et comprennent une hypotonie précoce, une chambre antérieure peu profonde, un épanchement choroïdien et un hyphéma. Aucun cas d’infection, de migration, d’érosion ou d’autres complications graves liées à la prothèse n’a été signalé à ce jour64,65

Le MicroShunt PRESERFLOMC montrant ses dimensions (mm) et son emplacement dans l’œil61
Le MicroShunt PRESERFLO semble plus performant que les autres dispositifs MIGS. Dans une étude récente comparant l’endoprothèse en gel XEN et le PRESERFLO MicroShunt, où la même concentration de MMC a été appliquée (0,2 mg/ml), il a été rapporté une réduction de la PIO de 28,1 % et 39,8 % à 2 ans de suivi pour les deux dispositifs, respectivement66. Cela peut indiquer que le MicroShunt PRESERFLO est plus efficace pour réduire la PIO que le dispositif XEN. Cette constatation peut être associée au taux élevé d’encapsulation des saignées qui est fréquemment rapporté avec ce dernier dispositif66, 67 Le taux plus faible d’encapsulation des blebs avec le MicroShunt PRESERFLO peut être dû à la biocompatibilité du matériau SIBS, qui a été conçu spécifiquement pour être non dégradable, ultra-pur et donc non inflammatoire, générant ainsi moins de fibrose tissulaire68. Néanmoins, des données plus solides provenant d’essais cliniques à long terme sont nécessaires pour déterminer l’efficacité et la sécurité relatives de ces dispositifs.
Bien qu’ils soient peut-être plus efficaces pour abaisser la PIO, les dispositifs MIGS sous-conjonctivaux, en tant que procédures de formation de bulles, comportent des risques de complications liées aux bulles. Indépendamment de leur petit diamètre luminal, qui offre une résistance accrue pour empêcher la surfiltration, certains cas d’hypotonie précoce ont encore été signalés. Dans les dispositifs MIGS du canal de Schlemm, le risque d’hypotonie est considérablement réduit, car la PIO postopératoire ne peut pas descendre en dessous de la pression veineuse épisclérale. C’est le principal avantage des dispositifs MIGS du canal de Schlemm69. Cependant, pour la même raison, les dispositifs du canal de Schlemm doivent être évités dans les yeux glaucomateux avec une pression veineuse épisclérale élevée, car ils donnent des résultats décevants en termes de réduction de la PIO70
En outre, si la PIO diminue en dessous de la pression veineuse épisclérale, il existe un risque élevé de reflux sanguin dans la chambre antérieure, provoquant un hyphéma, qui représente la complication postopératoire la plus courante après les procédures du canal de Schlemm69, 71. Une autre limitation importante des dispositifs MIGS du canal de Schlemm et surtout suprachoroïdiens est le fait qu’une cicatrisation excessive peut se produire dans la région d’implantation, ce qui peut (et c’est souvent le cas) conduire à une obstruction du dispositif.
Il en résulte une augmentation de la PIO et un besoin potentiel d’interventions supplémentaires. L’une des raisons importantes du taux élevé d’échec résultant d’une fibrose excessive dans ces dispositifs est qu’il n’existe actuellement aucune approche permettant d’appliquer des agents antifibrotiques en toute sécurité sur le site d’implantation sans risque de toxicité intraoculaire30, 72. L’obstruction du dispositif est une limitation importante pour tous les dispositifs MIGS, surtout en raison du petit diamètre de leur lumière. Bien qu’elles présentent l’avantage de réduire le risque d’hypotonie, les petites lumières risquent d’être obstruées par de la fibrine, des pigments iriens, du sang, du vitré et/ou des fragments de cristallin.
C. GATT (trabéculotomie transluminale assistée par gonioscopie)
L’histoire de la trabéculotomie
L’idée qu’une trabéculotomie puisse entraîner une baisse de la PIO est apparue pour la première fois dans les années 1950, lorsque Morgan Grant, MD, a émis l’hypothèse que 75 % de la résistance à l’écoulement aqueux était inhérente au réseau trabéculaire et qu’elle pouvait être éliminée en créant une ouverture entre la chambre antérieure et le canal de Schlemm1. Bien des années plus tard, travaillant avec une technologie plus sophistiquée, David Epstein, MD, a refait ces études et a découvert que la résistance produite par le réseau trabéculaire était en fait de l’ordre de 60 pour cent73 Malgré la différence dans les chiffres, la conclusion était claire : la majorité de la résistance à l’écoulement aqueux en cas de POAG est causée par le réseau trabéculaire (c’est également souvent le cas dans les glaucomes secondaires). L’utilisation d’une trabéculotomie pour rétablir le flux dans le système de drainage naturel du patient était une excellente idée; les solutions chirurgicales précédentes impliquaient la création d’une voie d’écoulement entièrement différente par le biais d’options telles que la trabéculectomie ou une dérivation tubulaire (ces options n’impliquent pas du tout le système de drainage naturel du patient. De plus, la dérivation de l’eau loin du système de drainage naturel peut contribuer à l’altération de la capacité d’écoulement de l’œil).
L’un des pionniers de ce type d’approche est Redmond Smith, MD, qui a publié sa première description de la technique ab externo de trabéculotomie à l’aide d’un filament de nylon en 196974. Au départ, sa version de la procédure a suscité beaucoup d’intérêt, car elle était très prometteuse pour abaisser la pression intraoculaire, en particulier dans le cas du glaucome congénital primaire et du glaucome juvénile à angle ouvert. L’idée qu’une trabéculotomie puisse potentiellement éliminer 75 % de la résistance à l’écoulement était très séduisante, de sorte que de nombreux chirurgiens étaient impatients de l’essayer chez leurs patients atteints de GPAO.
Toutefois, cette approche présentait plusieurs inconvénients et limitations qui ont entraîné une baisse de sa popularité :
Elle prend beaucoup de temps. Même dans les meilleures mains, cette procédure prend de 30 à 60 minutes ou plus.
Elle viole la conjonctive. La réalisation d’une trabéculotomie ab externo nécessite une grande dissection conjonctivale, un grand lambeau scléral et plusieurs sutures sclérales. Les chirurgiens ne voulaient pas violer la conjonctive supérieure et la sclérotique, car cela aurait réduit les chances d’efficacité de toute intervention chirurgicale ultérieure.
La chute de pression n’était pas aussi importante que celle obtenue avec une trabéculectomie ou une dérivation tubulaire. En particulier lorsque la trabéculectomie a été réalisée avec de la mitomycine C, elle a produit une chute de pression plus importante que la trabéculotomie ab externo
La trabéculotomie utilisait des trabéculotomes métalliques pour ouvrir le canal. En raison des limites associées à cette approche, ils n’ouvraient que les parties nasale et temporale supérieures du réseau. Des études anatomiques ont révélé que la majeure partie de l’écoulement dans l’œil se produit dans la partie inféronasale74. Ainsi, non seulement une grande partie du réseau trabéculaire n’était pas ouverte, mais les sections ouvertes n’étaient pas aussi efficaces pour le drainage.
L’impact de ce phénomène sur l’efficacité de la procédure a été confirmé par une étude publiée en 2012, dans laquelle les yeux traités par une trabéculotomie à 360 degrés créée à l’aide d’une suture en nylon sous un rabat scléral (25 yeux atteints de POAG et 18 yeux atteints de glaucome secondaire à angle ouvert) ont été comparés rétrospectivement à 16 yeux atteints de POAG et 19 yeux atteints de SOAG traités à l’aide de trabéculotomes en métal75. À 12 mois, le taux de réussite des patients atteints de POAG était de 84 % avec les sutures contre 31 % avec le trabéculotome; il était de 89 % contre 50 % dans le groupe SOAG. Cela démontre le pouvoir comparatif de l’ouverture de 360 degrés du réseau trabéculaire plutôt que, disons, de 120 à 180 degrés. Plus l’angle est ouvert, plus la diminution de la pression est importante (nous observons la même tendance dans les autres chirurgies MIGS actuellement disponibles).
Les avantages de la GATT
Au fil du temps, des variantes de la procédure de trabéculotomie ont été développées. Il y a environ sept ans, le Dr Fellman a eu l’idée de la GATT. Comme nous l’avons déjà mentionné, les méthodes antérieures de réalisation des trabéculotomies étaient ab externo, nécessitant la création d’un lambeau scléral, avec tous les problèmes qui y sont associés. Certaines versions récentes utilisaient également un cathéter, ce qui présente également quelques inconvénients. La procédure ab interno GATT a éliminé bon nombre de ces inconvénients tout en conservant les avantages et le taux de réussite remarquablement bon qu’offre une trabéculotomie complète à 360 degrés.
Pour réaliser une GATT, nous commençons par pratiquer une goniotomie dans le quadrant nasal. Nous canalisons ensuite le canal avec une suture en Prolene 5-0 qui a été émoussée à l’aide d’un cautère à basse température, ce qui lui permet de contourner l’angle plus facilement. Nous faisons passer la suture dans le canal à 360 degrés, récupérons l’extrémité et tirons ensuite la boucle dans la chambre antérieure (voir l’exemple ci-dessus). Le résultat est que nous avons traité 360 degrés de l’angle avec seulement deux petites paracentèses. Cela laisse une tablette trabéculaire.
En règle générale, le régime postopératoire vise principalement à maîtriser l’inflammation. Les patients reçoivent des stéroïdes et des antibiotiques quatre à six fois par jour pendant la première semaine. Si nous constatons une réponse aux stéroïdes et que la PIO est de 17 mm Hg ou plus, nous ajoutons de la pilocarpine la nuit et un bêtabloquant; si elle est de 22 mm Hg ou plus, nous demandons au patient d’utiliser de la pilocarpine deux fois par jour pendant toute la période de suivi. Après une semaine, nous arrêtons les antibiotiques, mais nous maintenons le patient sous stéroïdes jusqu’à ce que l’œil soit calme; ensuite, nous diminuons les stéroïdes.
Parfois, nous maintenons nos patients sous Pred Forte une fois par jour, et éventuellement sous pilocarpine la nuit, pendant trois à six mois, juste pour inhiber théoriquement toute cicatrisation potentielle dans l’angle. (L’objectif de l’opération n’est pas de débarrasser le patient de toutes les gouttes; le but est de réduire la dépendance aux médicaments et d’abaisser la pression). Nous demandons également au patient de prendre des précautions contre l’hyphéma, principalement en gardant la tête du lit surélevée, jusqu’à ce que l’hyphéma ait disparu.
Les avantages de la GATT sont les suivants :
Elle est beaucoup plus sûre et moins invasive que la trabéculotomieab externo; elle ne nécessite que la réalisation de deux petites paracentèses.
Elle rétablit le flux dans le système de drainage naturel de l’œil.
Elle prend beaucoup moins de temps que la trabéculotomieab externo
Elle ne viole pas la conjonctive et ne limite donc pas les options chirurgicales futures.
Elle est rentable et peut être réalisée avec une suture à 4 $ (Prolene 5-0).
Elle est très sûre, avec peu de complications. Celles qui surviennent tendent à se résorber d’elles mêmes avec des conséquences minimes.
Nos données indiquent qu’elle est très efficace.
En ce qui concerne les limitations, il est toujours vrai qu’une procédure telle que la trabéculectomie peut permettre d’obtenir une PIO très basse, de l’ordre de 10 mm Hg, ce qui n’est probablement pas le cas avec une GATT. Cependant, l’une des raisons pour lesquelles les procédures MIGS sont devenues populaires est que les chirurgiens ont compris que tous les patients n’ont pas besoin d’une pression aussi basse.
La GATT est donc une forme de trabéculotomie ab interno qui a été initialement décrite par Grover et coll. en 2014. Sous visualisation directe avec une lentille de gonioscopie, une goniotomie est pratiquée dans le réseau trabéculaire nasal qui sert de point d’entrée au microcathéteri Track (EllexiScience, Fremont, CA). Le microcathéter a un diamètre de 250 microns et son extrémité distale est éclairée pour permettre la visualisation pendant la progression du cathéter dans le canal de Schlemm. Une technique modifiée a également été décrite, utilisant une suture en nylon 4-0 à la place du microcathéter. Des pinces microchirurgicales sont utilisées pour faire avancer le microcathéter ou la suture dans le canal de Schlemm sur 360 degrés. Une fois qu’il a traversé tout le canal, l’extrémité distale du cathéter est saisie et l’extrémité proximale est rétractée hors de l’œil, cisaillant le réseau trabéculaire pour créer une trabéculotomie à 360 degrés.
La GATT peut être pratiquée sur des patients adultes ou pédiatriques atteints de glaucome à angle ouvert et dont la cornée est claire. Elle peut être réalisée seule ou en combinaison avec une opération de la cataracte. Les patients peuvent être phaques, pseudophaques ou aphaques.
Dans leur étude initiale, Grover et coll. ont rapporté les résultats à 6 et 12 mois d’une GATT réalisée chez des patients adultes atteints de glaucome à angle ouvert, soit en association avec une phacoémulsification, soit en tant qu’intervention autonome. Quatre-vingt-cinq yeux de quatre-vingt-cinq patients ont été inclus dans l’étude : 57 patients atteints de glaucome primaire à angle ouvert ont montré une diminution moyenne de la PIO de 11,1 ± 6,1 mm Hg et les patients ont eu besoin de 1,1 goutte de moins un an après l’opération77. Pour les 28 patients atteints d’autres formes de glaucome à angle ouvert, la PIO a diminué en moyenne de 19,9 ± 10,2 mm Hg et les patients ont eu besoin de 1,9 médicament de moins pour réduire la PIO un an après l’opération77. Le traitement a échoué chez 8/85 patients (9 %) en raison de la nécessité d’une intervention chirurgicale ultérieure sur le glaucome. La complication la plus fréquente était un hyphéma transitoire signalé chez 30 % des patients une semaine après l’opération, qui s’est résorbé un mois plus tard. Depuis la publication initiale, Grover et ses collègues ont rapporté l’utilisation réussie de la technique GATT dans le glaucome congénital primaire, le glaucome juvénile à angle ouvert et même dans des yeux ayant déjà subi une chirurgie incisionnelle du glaucome78,79. Ces premiers résultats représentent une technique prometteuse, épargnant la conjonctive, qui peut être utilisée en conjonction avec la chirurgie de la cataracte ou indépendamment de cette dernière.

a) GATT 180° contre 360°
Des preuves de plus en plus nombreuses suggèrent qu’un traitement à 360° du réseau trabéculaire (RT) ou du canal de Schlemm (CS) n’est peut-être pas nécessaire pour maximiser l’effet et obtenir un succès chirurgical80-83 Les hypothèses les plus courantes sont un effet de seuil dose-réponse potentiel au-delà de 120-180° du RT84 et un drainage non uniforme le long de la circonférence de 360° du RT, ce qui entraîne une efficacité accrue avec le traitement de segments spécifiques du RT et une contribution moindre à l’effet avec le traitement d’autres zones (dans les yeux sains, un écoulement actif segmentaire se produit principalement dans les quadrants nasaux et inférieurs)84,85. Alors que les taux de réussite sont similaires avec la trabéculotomie à 360° et à 180°, les taux et la gravité des complications, en particulier l’hyphéma, peuvent être plus élevés avec le clivage à 360° du toit du cristallin81-86. Par conséquent, d’après ce qui précède, les auteurs ont tendance à effectuer des procédures d’hémi-GATT (décollement du toit de 180° du CS) en routine. L’exécution d’une Gatt 180 peut également laisser les 180° restants pour une intervention future si nécessaire.
b) GATT inférieure contre GATT supérieure
Il n’existe pas beaucoup de preuves comparant les procédures hémi-GATT supérieures et inférieures. Waldner et coll. ont montré des tendances récurrentes d’un ratio de risque d’échec plus faible et d’une meilleure réduction de la PIO avec la réalisation d’une hémi-GATT inférieure plutôt que supérieure, bien qu’aucune différence statistiquement significative n’ait été trouvée87
Ceci est cohérent avec les études anatomiques invitro et invivo précédentes, montrant un écoulement segmentaire84,88. D’autres études sont nécessaires pour mieux évaluer ce sujet. Il est probable que la distribution des canaux collecteurs varie d’un individu à l’autre. Idéalement, on pourrait déterminer si un individu a une dominance supérieure ou inférieure dans la distribution de ses canaux collecteurs et, par la suite, l’hémi-GATT serait effectuée dans la région correspondante (ce point est encore discuté par les experts du glaucome). Nous avons décrit cette variabilité en réalisant une veinographie préopératoire.
Efficacité et sécurité de la procédure GATT dans le glaucome à angle ouvert, résultats à
Objectif : Le but de l’étude était d’évaluer rétrospectivement l’efficacité et la sécurité de la GATT pendant une période d’observation de 6 mois89
Sous visualisation gonioscopique, une trabéculotomie nasale est réalisée et une suture au Prolene ou le cathéter iTrack est avancé sur les 360° du canal de Schlemm. L’extrémité distale est saisie tandis que l’extrémité proximale est rétractée, cisaillant ainsi le canal de Schlemm.
https://eyewiki.aao.org/File:GATT_ figure_6.jpg
Matériel et méthodes : Le groupe étudié était composé de 69 patients atteints de glaucome à angle ouvert et traités par GATT en tant que procédure unique ou en combinaison avec une chirurgie de la cataracte. Les patients ont été évalués 1 jour, 10 jours, 1 mois, 3 mois et 6 mois après l’opération par un examen ophtalmologique standard comprenant le champ visuel, la PIO et la BCVA. Le nombre de médicaments pris quotidiennement et les complications éventuelles ont été vérifiés. Deux critères de réussite ont été établis (S1 : diminution de la PIO de 30 % et S2 : PIO inférieure à 18 mm Hg).
Résultats : Avant l’opération, la PIO moyenne était de 26,94 mm Hg et a diminué de manière significative après la GATT pour atteindre 15,59 mm Hg à 6M. La BCVA n’était pas significativement différente entre les visites. Le MD moyen n’a pas changé de manière significative au cours de la période d’observation de 6 mois (-8,20 dB vs -8,16 dB, P = 0,9824), tout comme le champ visuel moyen (64,31 % vs 63,05 %, P = 0,8571). Une diminution de 30 % de la PIO lors de la visite à 6 mois a été obtenue chez 95,6 % des patients, et 37,7 % ont eu besoin de médicaments pour stabiliser la PIO. Une PIO inférieure à 18 mm Hg à 6 mois a été obtenue chez 91,3 % des patients étudiés après la procédure GATT, et chez 58,0 % d’entre eux, sans médicaments supplémentaires. Le nombre moyen de médicaments reçus quotidiennement a diminué de manière significative à 6M par rapport aux résultats préopératoires (2,59 à l’inclusion vs 0,76 à 6M, P = 0,0004). La complication la plus fréquente après l’opération était l’hyphéma, qui s’est résolu spontanément dans les 10 jours.
1. Saheb H and Ahmed I. Micro-invasive glaucoma surgery: current perspectives and future directions. Current Opinions Ophthalmol. 2012; 23(2) 96-104.
2. https://www.associationfranceglaucome.fr/le-traitementchirurgical-du-glaucome-en-2020/
3. https://www.has-sante.fr/upload/docs/application/ pdf/2013-07/rapport_micro-stent_de_pontage_ trabeculaire_2013-07-26_14-43-59_961.pdf
4. Shi Y, Wang H, Oatts J, Cao K, Xin C, Liang X, Tian J, Han Y, Wang N. Ab interno vs ab externomicrocatheter-assistedtrabeculotomy for primarycongenitalglaucomawithclearcornea. Clin Exp Ophthalmol. 2020 Dec;48(9):1201-1209. doi: 10.1111/ ceo.13868. Epub 2020 Oct 27. PMID: 33058409; PMCID: PMC7756548.
5. https://ophtalmologie.umontreal.ca/recherche/activitesde-recherche/nouvelles-chirurgies-micro-invasives-migsen-glaucome/
6. https://www.sfo-online.fr/sites/www.sfo-online.fr/files/ medias/documents/1-Controverses-en-chirurgie-duglaucome.pdf :
7. https://www.sfo.asso.fr/revue-presse/revue-de-la-pressede-novembre-2023 :
8. Aref A. Durysta (bimatoprost implant). December 25, 2022. Accessed June 22, 2023. https://eyewiki.aao.org/ Durysta_(Bimatoprost_Implant)
9. Bimatoprost intracameral implant. Info-médicament. Allergan; 2020.
10. Bacharach J, Tatham A, Ferguson G, et coll.Phase 3, randomized, 20-month study of the efficacy and safety of bimatoprost implant in patients with open-angle glaucoma and ocular hypertension (ARTEMIS 2). Drugs. 2021;81(17):2017-2033.
11. Medeiros FA, Walters TR, Kolko M, et coll.Phase 3, randomized, 20-month study of bimatoprost implant in open-angle glaucoma and ocular hypertension (ARTEMIS 1). Ophthalmology. 2020;127(12):1627-1641.
12. Healio. FDA accepts iDose TR new drug application. May 6, 2023. Accessed June 27, 2023. https://www.healio. com/news/ophthalmology/20230506/fda-accepts-idosetr-new-drug-application
Conclusion : L’observation à 6 mois a montré que la GATT est une technique chirurgicale mini-invasive pour le glaucome qui permet une diminution efficace et sûre de la PIO.

La trabéculotomie transluminale assistée par gonioscopie (GATT) peut être réalisée de différentes manières. On voit ici une insertion de suture vers la droite à l’aide d’un instrument spécialisé, le TRAB360, qui vise 180° à la fois; il est ensuite tourné dans l’autre sens et la procédure est répétée. Images reproduites avec l’aimable autorisation de Sight Sciences, inc. Menlo Park, CA, États-Unis90
À suivre…
13. Chamard C, Larrieu S, Baudouin C, Bron A, Villain M, Daien V. Preservative-free versus preserved glaucoma eye drops and occurrence of glaucoma surgery. a retrospective study based on the French national health insurance information system, 2008-2016. Acta Ophthalmol. 2020;98(7):e876-e881.
14. Belamkar A, Harris A, Zukerman R, et coll. Sustained release glaucoma therapies: novel modalities for overcoming key treatment barriers associated with topical medications. Ann Med. 2022;54(1):343-358.
15. Gedde SJ, Vinod K, Wright MM, et coll. Primary Open-Angle Glaucoma Preferred Practice Pattern. Ophthalmology. 2021;128(1):P71-P150.
16. Gazzard G, Konstantakopoulou E, Garway-Heath D, et coll. Selective laser trabeculoplasty versus eye drops for first-line treatment of ocular hypertension and glaucoma (LiGHT): a multicentre randomised controlled trial. Lancet. 2019;393(10180):1505-1516.
17. Swain DL, Eliassi-Rad B. Five-year outcomes of selective laser trabeculoplasty: a retrospective study. Front Med (Lausanne). 2022;9:1039195.
18. https://www.medpagetoday.com/ophthalmology/ generalophthalmology/107874 ?xid=nl_mpt_DHE_202312-14&eun = g1029186d0r&utm_source=Sailthru&utm_ medium=email&utm_campaign = Daily%20Headlines%20 Evening%202023-12-14&utm_term=NL_Daily_DHE_dualgmail-definition
19. https://www.mayoclinic.org/diseases-conditions/ glaucoma/diagnosis-treatment/drc-20372846:
20. McIlraith I, Strasfeld M, Colev G, Hutnik CM. Selective laser trabeculoplasty as initial and adjunctive treatment for open-angle glaucoma. J Glaucoma. 2006 Apr;15(2): 124–130.
21. Damji KF, Shah KC, Rock WJ, Bains HS, Hodge WG. Selective laser trabeculoplasty V Argon laser trabeculoplasty: A prospective randomised clinical trial. Br J Ophthalmol. 1999 Jun;83(6):718–722.
22. Juzych MS, Chopra V, Banitt MR, Hughes BA, Kim C, Goulas MT, Shin DH. Comparison of long-term outcomes of selective laser trabeculoplasty versus argon laser trabeculoplasty in open-angle glaucoma. Ophthalmology. 2004 Oct;111(10):1853–1859.
23. Nagar M, Ogunyomade A, O’Brart DP, Howes F, Marshall J. A randomized prospective study comparing selective laser trabeculoplasty with latanoprost for the control of intraocular pressure in ocular hypertension and open angle glaucoma. Br J Ophthalmol. 2005 Nov;89(11):1413–1417.
24. Chen E, Golchin S, Blomdahl S. A comparison between 90 degrees and 180 degrees selective laser trabeculoplasty. J Glaucoma. 2004 Feb;13(1):62–65.
25. Song J, Lee PP, Epstein DL, Stinnett SS, Herndon LW Jr, Asrani SG, Allingham RR, Challa P. High failure rate associated with 180 degrees selective laser trabeculoplasty. J Glaucoma. 2005 Oct;14(5):400–408.
26. Prasad N, Murthy S, Dagianis JJ, Latina MA. A comparison of the intervisit intraocular pressure fluctuation after 180 and 360 degrees of selective laser trabeculoplasty (SLT) as a primary therapy in primary open angle glaucoma and ocular hypertension. J Glaucoma. 2009 Feb;18(2):157–160.
27. Ayala M, Chen E. Long-term outcomes of selective laser trabeculoplasty (SLT) treatment. Open Ophthalmol J. 2011;5:32–34.
28. Green W, Lind JT, Sheybani A. Review of the Xen Gel Stent and InnFocusMicroShunt. Curr OpinOphthalmol. 2018;29(2):162-170. doi:10.1097/ICU.0000000000000462
29. De Gregorio A, Pedrotti E, Stevan G, Bertoncello A, Morselli S. XEN glaucoma treatment system in the management of refractory glaucomas: a short review on trial data and potential role in clinical practice. Clin Ophthalmol. 2018;12:773-782. Published 2018 Apr 30. doi:10.2147/OPTH.S146919
30. Chaudhary A, Salinas L, Guidotti J, Mermoud A, Mansouri K. XEN Gel Implant: a new surgical approach in glaucoma. Expert Rev Med Devices. 2018;15(1):47-59. doi:10.1080/17434440.2018.1419060
31. Fea AM, Durr GM, Marolo P, Malinverni L, Economou MA, Ahmed I. XEN® Gel Stent: A Comprehensive Review on Its Use as a Treatment Option for Refractory Glaucoma. Clin Ophthalmol. 2020;14:1805-1832. Published 2020 Jun 30. doi:10.2147/OPTH.S178348
32. American Academy of Ophthalmology. FDA approves Xen gel stent for gl.aucoma. https://www.aao.org/headline/ fda-approves-xen-gel-stent-glaucoma. Accessed May 20, 2018.
33. Green W, Lind JT, Sheybani A. Review of the Xen Gel Stent and InnFocusMicroShunt. CurrOpinOphthalmol. 2018;29(2):162-170. doi:10.1097/ICU.0000000000000462
34. Sheybani A, Reitsamer H, Ahmed IIK. Fluid dynamics of a novel micro-fistula implant for the surgical treatment of glaucoma. Invest Ophthalmol Vis Sci. 2015;56:4789–4795.
35. Fea AM, Durr GM, Marolo P, Malinverni L, Economou MA, Ahmed I. XEN® Gel Stent: A Comprehensive Review on Its Use as a Treatment Option for Refractory Glaucoma. Clin Ophthalmol. 2020;14:1805-1832. Published 2020 Jun 30. doi:10.2147/OPTH.S178348
36. Tan NE, Tracer N, Terraciano A, Parikh HA, Panarelli JF, Radcliffe NM. Comparison of safety and efficacy between Ab interno and Ab externo approaches to XEN gel stent placement. Clin Ophthalmol. (2021) 15:299– 305. doi: 10.2147/OPTH.S292007
37. Ucar F, Cetinkaya S. Xen implantation in patients with primary open-angle glaucoma: comparison of two different techniques. Int Ophthalmol. (2020) 40:2487–94. doi: 10.1007/s10792-020-01427-z
38. Do A, McGlumphy E, Shukla A, Dangda S, Schuman JS, Boland MV, et coll. Comparison of clinical outcomes with open versus closed conjunctiva implantation of the XEN45 gel stent. Ophthalmol Glaucoma. (2021) 4:343– 9. doi: 10.1016/j.ogla.2020.12.003
39. Dangda S, Radell JE, Mavrommatis MA, Lee R, Do A, Sidoti PA, et coll. Open conjunctival approach for sub-tenon’s xen gel stent placement and bleb morphology by anterior segment optical coherence tomography. J Glaucoma. (2021) 30:988–95. doi: 10.1097/ IJG.0000000000001929
40. Kong YXG, Chung IY, Ang GS. Outcomes of XEN45 gel stent using posterior small incision sub-tenon ab interno insertion (semi-open) technique. Eye. (2021). doi: 10.1038/ s41433-021-01635-6
41. Chen X-z, Liang Z-q, Yang K-y, Lv K, Ma Y, Li M-y and Wu H-j (2022) The Outcomes of XEN Gel Stent Implantation: A Systematic Review and Meta-Analysis. Front. Med. 9:804847. doi: 10.3389/fmed.2022.804847
42. Grover DS, Flynn WJ, Bashford KP, et coll.Performance and Safety of a New Ab interno Gelatin Stent in Refractory Glaucoma at 12 Months. Am J Ophthalmol. 2017;183:25-36. doi:10.1016/j.ajo.2017.07.023
43. Galal A, Bilgic A, Eltanamly R, Osman A. XEN Glaucoma Implant with Mitomycin C 1-Year Follow-Up: Result and Complications. J Ophthalmol. 2017;2017:5457246. doi:10.1155/2017/5457246
44. De Gregorio A, Pedrotti E, Russo L, Morselli S. Minimally invasive combined glaucoma and cataract surgery: clinical results of the smallest ab interno gel stent. Int Ophthalmol. 2018;38(3):1129-1134. doi:10.1007/s10792-017-0571-x
45. Reitsamer H, Sng C, Vera V, et coll.Two-year results of a multicenter study of the ab interno gelatin implant in medically uncontrolled primary open-angle glaucoma. Graefes Arch Clin ExpOphthalmol. 2019;257(5):983-996. doi:10.1007/s00417-019-04251-z
46. Reitsamer H, Vera V, Ruben S, Au L, Vila-Arteaga J, Teus M, Lenzhofer M, Shirlaw A, Bai Z, Balaram M, Stalmans I. Three-year effectiveness and safety of the XEN gel stent as a solo procedure or in combination with phacoemulsification in open-angle glaucoma: a multicentre study. Acta Ophthalmol. 2022 Feb;100(1):e233-e245.
47. Lenzhofer M, Kersten-Gomez I, Sheybani A, et coll. Fouryear results of a minimally invasive transscleral glaucoma gel stent implantation in a prospective multi-centre study. Clin ExpOphthalmol. 2019;47(5):581-587. doi:10.1111/ ceo.13463
48. Tan NE, Tracer N, Terraciano A, Parikh HA, Panarelli JF, Radcliffe NM. Comparison of Safety and Efficacy Between Ab interno and Ab externo Approaches to XEN Gel Stent Placement. Clin Ophthalmol. 2021;15:299-305. doi:10.2147/ OPTH.S292007
49. Do A, McGlumphy E, Shukla A, Dangda S, Schuman JS, Boland MV, Yohannan J, Panarelli JF, Craven ER. Comparison of Clinical Outcomes with Open Versus Closed Conjunctiva Implantation of the XEN45 Gel Stent. Ophthalmol Glaucoma. 2020 Dec 13:S25894196(20)30321-5. doi: 10.1016/j.ogla.2020.12.003.
50. Johnson M. “What controls aqueous humour outflow resistance ?”. Exp Eye Res. 2006;82:545–57.
51. Dick HB, Schultz T, Gerste RD. Miniaturization in glaucoma monitoring and treatment: a review of new technologies that require a minimal surgical approach. Ophthalmol Ther. 2019;8:19–30.
52. Lee RMH, Bouremel Y, Eames I, Brocchini S, Khaw PT. Translating minimally invasive glaucoma surgery devices. Clin TranslSci. 2020;13:14–25.
53. Shaarawy TM, Moschos MM, Sherwood MB. New glaucoma surgical alternatives. In: Shaarawy TM, Sherwood MB, Hitchings RA, Crowston JG, editors. Glaucoma. 2nd ed. London, England, UK: Elsevier/Saunders; 2015. p. 1188–201.
54. Chen DZ, Sng CCA. Safety and efficacy of microinvasive glaucoma surgery. J Ophthalmol. 2017;2017:3182935.
55. Kaplowitz K, Schuman JS, Loewen NA. Techniques and outcomes of minimally invasive trabecular ablation and bypass surgery. Br J Ophthalmol. 2014;98:579–85.
56. Schehlein EM, Kaleem MA, Swamy R, Saeedi OJ. Microinvasive glaucoma surgery: an evidence-based assessment. Expert RevOphthalmol. 2017;12:331–43.
57. Glaukos. iStentSurgery | Glaukos. 2020. https://www. glaukos.com/healthcare-professionals/istent-inject/
58. Glaukos. Glaukos—iStent inject® W. 2021. https://www. glaukos.com/en-uk/healthcare-professionals/istentinject-w/.
59. Samet S, Ong JA, Ahmed IIK. Hydrus microstent implantation for surgical management of glaucoma: a review of design, efficacy and safety. Eye Vis. 2019;6:32.
60. Ahmed IIK, Fea A, Au L, Ang RE, Harasymowycz P, Jampel HD, et coll.A prospective randomized trial comparing Hydrus and iStent microinvasive glaucoma surgery implants for standalone treatment of openangle glaucoma: the COMPARE study. Ophthalmology. 2020;127:52–61.
61. Sadruddin O, Pinchuk L, Angeles R, Palmberg P. Ab externo implantation of the MicroShunt, a poly (styreneblock-isobutylene-block-styrene) surgical device for the treatment of primary open-angle glaucoma: a review. Eye Vis. 2019;6:36.
62. Pinchuk L, Riss I, Batlle JF, Beckers HJM, Stalmans I. An ab-externo minimally invasive aqueous shunt comprised of a novel biomaterial. In: Samples JR, Ahmed IIK, editors. New concepts in glaucoma surgery series—Vol. 1. Amsterdam, The Netherlands: Kugler Publications; 2020. p. 181–93.
63. Gedde SJ, Panarelli JF, Banitt MR, Lee RK. Evidencedbased comparison of aqueous shunts. Curr OpinOphthalmol. 2013;24:87–95.
64. Green W, Lind JT, Sheybani A. Review of the Xen Gel Stent and InnFocusMicroShunt. Curr Opin
65. Beckers HJM, Pinchuk L. Minimally invasive glaucoma surgery with a new ab-externo subconjunctival bypass— current status and review of literature. Eur Ophthalmic Rev. 2019;13:27–30.
66. Scheres LMJ, Kujovic-Aleksov S, Ramdas WD, de Crom RMPC, Roelofs LCG, Berendschot TTJM, et coll. XEN® Gel Stent compared to PRESERFLOTMMicroShunt implantation for primary open-angle glaucoma: two-year results. Acta Ophthalmol. 2020. https://doi.org/10.1111/ aos.14602.
67. Schlenker MB, Gulamhusein H, Conrad-Hengerer I, Somers A, Lenzhofer M, Stalmans I, et coll. Efficacy, safety, and risk factors for failure of standalone ab interno gelatin microstent implantation versus standalone trabeculectomy. Ophthalmology. 2017;124:1579–88.
68. Pinchuk L, Riss I, Batlle JF, Kato YP, Martin JB, Arrieta E, et coll.The development of a micro-shunt made from poly (styrene-block-isobutylene-block-styrene) to treat glaucoma. J Biomed Mater Res Part B Appl Biomater. 2017;105:211–21.
69. Pillunat LE, Erb C, Jünemann AGM, Kimmich F. Microinvasive glaucoma surgery (MIGS): a review of surgical procedures using stents. Clin Ophthalmol. 2017;11:1583–1600.
70. Ittoop SM, Seibold LK, Kahook MY. Current opinion in ophthalmology: novel glaucoma devices in the pipeline. Curr OpinOphthalmol. 2019;30:117–24.
71. Fingeret M, Dickerson JE. The role of minimally invasive glaucoma surgery devices in the management of glaucoma. Optom Vis Sci. 2018;95:155–62.
72. Bettin P, Di Matteo F. Glaucoma: present challenges and future trends. OphthalmicRes. 2013;50:197–208. Ophthalmol. 2018;29:162–70.
73. Rosenquist R, Epstein D, Melamed S, Johnson M, Grant WM. Outflow resistance of enucleated human eyes at two different perfusion pressures and different extents of trabeculotomy. Current Eye Research 1989;8:1233-1240.
74. Dvorak-Theobald G. Further studies on the canal of Schlemm: its anastomoses and anatomic relations. Am J Ophthalmol 1955; 39:65–89.
75. Chin S, Nitta T, Shinmei Y, Aoyagi M, Nitta A, Ohno S, Ishida S, Yoshida K. Reduction of intraocular pressure using a modified 360-degree suture trabeculotomy technique in primary and secondary open-angle glaucoma: A pilot study. J Glaucoma 2012; 21:6:401-7.
76. https://eyewiki.org/Gonioscopy-Assisted_Transluminal_ Trabeculotomy_(GATT)_-_a_glaucoma_surgery
77. Smith, O.U.et coll. Twenty-Four-Month Outcome of Gonioscopy-Assisted Transluminal Trabeculotomy (GATT) in Eyes With Prior Corneal Transplant Surgery. J Glaucoma, 2022. 31(1): p. 54-59.
78. Belkin, A.et coll. Gonioscopy-assisted transluminal trabeculotomy is an effective surgical treatment for uveitic glaucoma. Br J Ophthalmol, 2023. 107(5): p. 690-697.
79. Sharkawi, E.et coll. Outcomes of gonioscopy-assisted transluminal trabeculotomy in pseudoexfoliative glaucoma: 24-month follow-up. Br J Ophthalmol, 2021. 105(7): p. 977-982.
80. Alemu, B. Trabeculectomy: complications and success in IOP control. Ethiop Med J, 1997. 35(1): p. 1-11.
81. Alwitry, A.et coll. Early bleb leak after trabeculectomy and prognosis for bleb failure. Eye (Lond), 2009. 23(4): p. 858-63.
82. Ahmed, II, MIGS and the FDA: What's in a Name ? Ophthalmology, 2015. 122(9): p. 1737-9.
83. Fellman, R.L.et coll. American Glaucoma Society Position Paper: Microinvasive Glaucoma Surgery. Ophthalmol Glaucoma, 2020. 3(1): p. 1-6.
84. Smith, R. Nylon filament trabeculotomy. Comparison with the results of conventional drainage operations in glaucoma simplex. Trans Ophthalmol Soc N Z, 1969. 21: p. 15-26.
85. Chin, S.et coll. Reduction of intraocular pressure using a modified 360-degree suture trabeculotomy technique in primary and secondary open-angle glaucoma: a pilot study. J Glaucoma, 2012. 21(6): p. 401-7.
86. Grover, D.S.et coll. Gonioscopy-assisted transluminal trabeculotomy, ab interno trabeculotomy: technique report and preliminary results. Ophthalmology, 2014. 121(4): p. 855-61.
87. Grover, D.S.et coll. Outcomes of Gonioscopy-assisted Transluminal Trabeculotomy (GATT) in Eyes With Prior Incisional Glaucoma Surgery. J Glaucoma, 2017. 26(1): p. 41-45.
88. Grover, D.S.et coll. Gonioscopy-assisted Transluminal Trabeculotomy: An Ab interno Circumferential Trabeculotomy: 24 Months Follow-up. J Glaucoma, 2018. 27(5): p. 393-401.
89. https://www.ncbi.nlm.nih.gov/pmc/articles/PMC9914959/ 90. https://www.researchgate.net/figure/Gonioscopyassisted-transluminal-trabeculotomy-GATT-can-beperformed-in-many-ways_fig5_334454551



La pinguécula est une surélévation blanc jaunâtre située au niveau de la conjonctive bulbaire. Elle n’a aucune tendance à empiéter sur la cornée. Cependant, elle peut provoquer des imperfections esthétiques ou une irritation en cas d’élévation due à l’inflammation et, bien que ce soit rarement nécessaire, elle peut être facilement enlevée et ne récidivera habituellement pas1
Le ptérygion est une excroissance charnue et triangulaire de la conjonctive bulbaire, qui ne se produit qu’aux méridiens de 3 et 9 heures de chaque œil, habituellement non simultanément. Le ptérygion peut s’étendre et déformer la cornée, induire un astigmatisme et modifier la puissance de réfraction de l’œil. Les symptômes peuvent comprendre des signes fonctionnels comme la sensation de corps étranger et parfois une baisse de l’acuité visuelle. Le ptérygion est plus fréquent dans les climats ensoleillés, chauds et secs1
D’abord, la pinguécula…
La pinguécula est une lésion relativement fréquente, non maligne, de la conjonctive bulbaire interpalpébrale, de couleur jaune-blanc, qui n’atteint pas la cornée et représente une dégénérescence élastique du collagène sous-épithélial avec du tissu conjonctif hyalinisé2,3. Ces lésions charnues sont typiquement bilatérales et adjacentes au limbe de la conjonctive bulbaire nasale, bien qu’elles puissent également être présentes au niveau temporal.
On pense que les pinguéculas résultent des effets des irritants environnementaux tels que le vent et la poussière et sont associés à l’exposition aux UV et au vieillissement, mais les preuves de l’association entre l’exposition aux UV et les pinguéculas restent limitées4
[On pense que les ptérygions et les pinguéculas apparaissent plus fréquemment du côté nasal parce que la lumière qui passe médialement à travers la cornée se concentre sur la zone du limbe nasal, tandis que l’ombre du nez réduit l’intensité de la lumière transmise à la zone du limbe temporal]3
Facteurs de risque : Exposition à la lumière UV, vent, poussière, mode de vie en plein air et proximité de l’équateur, âge, sexe masculin, tabagisme, travail en plein air, diabète5
Le diagnostic est généralement établi cliniquement à l’aide d’une biomicroscopie à la lampe à fente. L’excroissance classique est surélevée, de couleur jaune-blanc, située dans la fissure interpalpébrale et plus fréquente au niveau nasal qu’au niveau temporal. La lésion peut être très vascularisée et injectée ou associée à des érosions épithéliales ponctuées ou à un dellen (amincissement de la cornée adjacente dû à la dessiccation)5
Une biopsie avec confirmation histopathologique n’est généralement pas nécessaire, mais elle peut être indiquée dans les cas atypiques où le diagnostic reste incertain. L’épaisseur de la lésion peut être vérifiée par TCO du segment antérieur.
La lubrification à l’aide de larmes artificielles et de pommade peut aider à soulager l’irritation de la surface oculaire. L’excision n’est indiquée que lorsque les pinguéculas sont inacceptables d’un point de vue esthétique, lorsqu’elles deviennent chroniquement enflammées ou lorsqu’elles interfèrent avec le port de lentilles de contact. L’utilisation à long terme d’une thérapie stéroïdienne topique doit être découragée en raison de ses effets secondaires indésirables, mais elle peut être utilisée judicieusement chez les patients souffrant de pinguéculas enflammées, appelées « pinguéculites ». Il a également été démontré que l’indométhicine topique réduisait les symptômes de l’inflammation6
La photocoagulation au laser et l’excision chirurgicale des pinguéculas ont toutes deux été utilisées avec succès, avec des résultats esthétiques similaires7
Une étude portant sur 30 patients a montré que l’excision chirurgicale des pinguéculas symptomatiques avec une autogreffe conjonctivale fixée avec de la colle de fibrine améliorait non seulement l’esthétisme, mais aussi le syndrome de l’œil sec8

Ce fichier est placé sous la licence Creative Commons Attribution-Share Alike 2.5 Generic.

Pinguécula9
Ce fichier est placé sous la licence Creative Commons Attribution-Share Alike 3.0 Unported.
Le ptérygion
Le ptérygion, ou œil de surfeur, est une affection conjonctivale dégénérative fibrovasculaire courante associée à une exposition chronique aux rayons ultraviolets (UV). Le terme ptérygion est dérivé du mot grec « pterygion », qui signifie « aile », ce qui reflète l’aspect caractéristique de cette affection : une lésion centripète surélevée, en forme d’aile ou de triangle, qui se développe à partir de la conjonctive sur la cornée. Le ptérygion est généralement bilatéral et se trouve sur la face nasale de l’œil, mais il peut aussi être présent sur la face temporale10
La prévalence du ptérygion est en moyenne de 12 % dans le monde, mais les chiffres varient considérablement, de 1,3 % à 53 %11-13. Divers facteurs de risque, tels que la démographie et l’environnement, jouent un rôle dans l’écart entre les prévalences rapportées, les chiffres étant plus élevés chez les personnes plus âgées vivant dans des régions équatoriales ensoleillées et poussiéreuses, ou chez les personnes exerçant des activités de plein air11
Bien que la physiopathologie soit complexe et mal comprise, il existe depuis longtemps une association entre l’exposition prolongée aux rayons UV (lumière du soleil) et la formation de ptérygion14. Les rayons ultraviolets jouent un rôle essentiel dans l’initiation et la promotion de la formation de ptérygion par l’intermédiaire de plusieurs mécanismes, notamment l’inflammation, l’activation des fibroblastes, le remodelage de la matrice extracellulaire, l’angiogenèse et l’invasion tissulaire. Des facteurs génétiques et des infections virales ont également été associés à la physiopathologie du ptérygion15,16
L’inflammation est un élément central de la physiopathologie du ptérygion. L’exposition chronique aux UV provoque un stress oxydatif sur l’ADN des cellules conjonctivales, ce qui déclenche une cascade inflammatoire dans la conjonctive, caractérisée par la libération de cytokines et de chimiokines pro-inflammatoires17,18. Les médiateurs inflammatoires stimulent la libération de facteurs de croissance, tels que le facteur de croissance de l’endothélium vasculaire (VEGF) et le facteur de croissance des fibroblastes (FGF), dans le tissu du ptérygion19
L’angiogenèse, ou la formation de nouveaux vaisseaux sanguins, est favorisée par le VEGF, et ces nouveaux vaisseaux sanguins fournissent de l’oxygène et des nutriments au ptérygion en développement et donnent l’aspect caractéristique de l’œil rouge souvent associé à la condition20
L’expression du FGF dans les tissus conjonctivaux stimule l’activation des fibroblastes. Ces cellules normalement quiescentes se transforment en myofibroblastes, très contractiles et capables de synthétiser et de déposer des composants de la matrice extracellulaire tels que le collagène et la fibronectine19. Les myofibroblastes contribuent à la nature fibrotique du tissu du ptérygion19
Une autre conséquence de l’inflammation chronique est la surexpression des métalloprotéinases matricielles (MMP), qui entraîne le remodelage de la matrice extracellulaire (MEC) de la conjonctive21. Le clivage des protéines structurelles de la MEC (collagène, fibronectine et protéoglycanes) par les MMP entraîne la dégradation et le remodelage du tissu conjonctival. La présence de MMP dans le tissu du ptérygion contribue à l’invasion tissulaire. En dégradant la membrane basale de la cornée et les fibres de collagène, les MMP créent des voies d’infiltration et d’invasion de la cornée par le tissu du ptérygion18. Il s’agit d’une étape critique dans la progression du ptérygion, car elle permet à la lésion d’empiéter davantage sur la cornée, ce qui affecte la vision. Si le rayonnement UV reste un facteur de risque important, des facteurs génétiques et moléculaires contribuent également au développement du ptérygion. La recherche a identifié des polymorphismes génétiques et des altérations moléculaires spécifiques associés à une susceptibilité accrue au ptérygion22. Ces facteurs peuvent moduler la réponse individuelle au rayonnement UV et à l’inflammation, ce qui met encore plus en évidence la relation entre la génétique et les facteurs environnementaux dans la pathophysiologie de l’affection.
Récemment, des infections virales telles que l’herpès simplex (HSV) et le papillome humain (HPV) ont été trouvées dans des échantillons de tissu de ptérygion23,24 Le rôle des virus dans la pathophysiologie de la progression du ptérygion est controversé, mais des recherches plus approfondies pourraient conduire à des options de médicaments antiviraux pour le traitement du ptérygion

Le ptérygion est composé de plusieurs segments26 :
Les taches de Fuchs (minuscules taches grises qui se dispersent près de la tête du ptérygion).
Ligne de Stocker (ligne brunâtre composée de dépôts de fer).
Capuchon (partie fibreuse et non vasculaire du ptérygion).
Tête (sommet du ptérygion, typiquement surélevé et très vasculaire).
Corps (partie charnue surélevée, congestionnée par des vaisseaux tortueux).
Bord supérieur (bord supérieur de la partie triangulaire ou en forme d’aile du ptérygion).
Bord inférieur (bord inférieur de la partie triangulaire ou en forme d’aile du ptérygion).
Les diagnostics différentiels du ptérygion sont les suivants27 :
1. Corps étranger conjonctival : Le corps étranger conjonctival est reconnaissable à l’examen de l’œil à la lampe à fente, le patient se plaignant d’une sensation de corps étranger et d’un larmoiement de la surface de l’œil. Le corps étranger conjonctival peut être retiré à l’aide d’une aiguille stérile jetable.
2. Phlyctène : Peut apparaître n’importe où sur la conjonctive. Elle se présente sous la forme d’un sommet surélevé et se colore à la fluorescéine. La phlyctène est due à une réaction hypersensible à un allergène endogène. Elle est généralement associée à Mycobacterium tuberculosis.
3. Sclérite nodulaire : La sclérite nodulaire est associée à une douleur intense. L’inflammation sclérale correspond à un nodule distinct dans la sclérite nodulaire.
4. Dermoïde limbique : Le dermoïde limbique est une masse jaune pâle. La localisation la plus fréquente est le limbe temporal inférieur. Il peut toucher la conjonctive et la cornée.
5. Mélanome malin conjonctival : Le mélanome malin conjonctival est une tumeur maligne rare de la conjonctive. Il se présente sous la forme d’une lésion pigmentée surélevée associée à un vaisseau d’alimentation.
6. Kyste d’inclusion épithéliale conjonctivale : Le kyste d’inclusion épithélial conjonctival est une tuméfaction kystique remplie de liquide clair. Les patients sont généralement asymptomatiques.
7. Néoplasie malpighienne de la surface oculaire : La néoplasie malpighienne de la surface oculaire est une tumeur maligne fréquente de la surface oculaire. Les patients se plaignent d’une rougeur et d’une sensation de corps étranger. Ils se présentent généralement dans la conjonctive interpalpébrale. Elles s’approchent progressivement du limbe. Elle est généralement associée à un vaisseau sentinelle.
8. Nævus conjonctival : Le nævus conjonctival est une lésion bénigne de la conjonctive. Il s’agit de lésions pigmentées plates.

Début de ptérygion28
Ce fichier est placé sous la licence Creative Commons Attribution-Share Alike 4.0 International.
Bien que le ptérygion ait des conséquences potentiellement importantes sur la vision et l’inconfort oculaire, le diagnostic précis de cette affection est parfois négligé. En raison de sa présentation variable, le diagnostic peut être difficile, mais il est nécessaire pour la prise de décision clinique. Il est utile que les praticiens des soins oculaires intègrent l’évaluation diagnostique du ptérygion dans leur évaluation clinique habituelle, en particulier pour ceux qui travaillent dans des communautés présentant des facteurs de risque élevés. Le fait de vivre près de l’équateur, dans un environnement chaud et poussiéreux, d’avoir un âge avancé, d’être un homme et de passer de nombreuses heures au soleil constituent tous des facteurs de risque de formation de ptérygion11
Grades du ptérygion basés sur la morphologie29
Grade Caractéristiques cliniques
1 Vaisseaux épiscléraux clairement visibles sous un ptérygion atrophié.
2 Tout ptérygion qui montre des caractéristiques entre grades 1 et 3.
3 Les vaisseaux épiscléraux ne sont pas clairement visibles, car le ptérygion est charnu.
Une anamnèse approfondie permettra d’élucider l’exposition aux facteurs de risque et de déterminer si le patient présente des symptômes associés au ptérygion, tels qu’une irritation oculaire, une rougeur, une limitation des mouvements oculaires ou un astigmatisme induit entraînant une vision floue (uniquement dans les cas avancés où la tumeur a envahi la cornée de manière significative)25 L’examen à la lampe à fente reste la pierre angulaire du diagnostic du ptérygion, car il s’agit d’un instrument auquel tous les praticiens des soins oculaires ont accès. La ligne de Stoker est un dépôt de fer dans la cornée superficielle à la tête du ptérygion et peut également être visualisée à l’aide d’une lampe à fente30
La tomographie par cohérence optique du segment antérieur (AS-OCT) est de plus en plus utilisée pour évaluer et suivre la progression du ptérygion, car elle fournit plus de détails qu’une évaluation à la lampe à fente18. Des méthodes automatisées utilisant des images du segment antérieur et des programmes informatiques sont également en cours de développement à des fins de dépistage dans les zones rurales afin d’améliorer la capacité de diagnostic dans les régions mal desservies19. Le ptérygion peut induire un astigmatisme et une surface cornéenne irrégulière, affectant l’acuité visuelle (AV).
La mesure de l’acuité visuelle, de la réfraction et de la topographie est nécessaire pour surveiller l’effet du ptérygion, surtout s’il a envahi la cornée.
Le ptérygion peut être décrit comme ayant une tête (la partie qui pousse vers la cornée), un corps (la zone qui joint la tête et la base) et une base (la partie la plus large du ptérygion, qui se trouve au-dessus de la conjonctive bulbaire). Le ptérygion peut être classé une fois que le diagnostic a été établi sur la base de l’évaluation ci-dessus. Le classement du ptérygion est généralement basé sur ses caractéristiques cliniques, notamment sa taille, sa vascularisation et l’atteinte de la cornée. Quelques systèmes de classification ont été proposés dans la littérature pour les ptérygions primaires et récurrents29-35. Différentes échelles de classification sont nécessaires, car certains ptérygions récurrents n’ont pas de vaisseaux épiscléraux, ce qui est une caractéristique de certains systèmes de classification pour les ptérygions primaires.

Grand ptérygion primaire envahissant la pupille (axe visuel)36
Ce fichier est placé sous la licence Creative Commons Attribution-Share Alike 4.0 International.
Grades du ptérygion basés sur l’étendue sur la cornée37
Grade Caractéristiques cliniques
1 0 mm à 2 mm du limbe
2 2 mm à 4 mm du limbe
3 Plus de 4 mm du limbe
Excision du ptérygion
On utilise souvent un bloqueur de nerfs pour l’excision du ptérygion. L’anesthésie rétrobulbaire est généralement la plus confortable pour le patient, car elle permet un bon contrôle de la douleur pendant l’intervention. Il faut veiller à ne pas endommager le tissu cornéen sous-jacent ou à ne pas enlever le stroma lorsqu’on retire le ptérygion de la surface de l’œil38
Il faut d’abord inciser le limbe à l’endroit où le ptérygion commence à empiéter sur la cornée. Le couper ensuite et le décoller de la surface de la cornée à l’aide d’une dissection émoussée. Une fois le ptérygion retiré, nous polissons souvent la cornée à l’aide d’une fraise diamantée. Une fois la cornée réparée, nous nous intéressons à la sclérotique et à la conjonctive.
Il faut dégager la conjonctive de la capsule de Tenon. Retirer toute la capsule de Tenon à l’endroit où se trouvait le ptérygion.
Une fois que le tissu cicatriciel est retiré de la face nasale de la cornée et du globe, on doit décider ce qu’on va mettre dans l’espace où se trouvait le tissu cicatriciel. Il existe plusieurs options :
Option 1 : Ne rien faire. On pourrait simplement laisser la zone nue et elle se ré-épithélialisera d’elle même. Toutefois, cette option présente le risque de récidive le plus élevé et induit le plus d’inconfort pour le patient, mais elle est possible.
Option 2 : Recouvrir la zone avec un matériau biologique. La membrane amniotique, qui peut être placée et collée ou suturée sur la zone du défaut, est une méthode très efficace. On peut préférer utiliser la colle, car elle est rapide et simple. La membrane amniotique améliore le confort des patients et contribue à la cicatrisation des tissus. Cependant, elle n’est pas aussi efficace que la troisième option pour décourager les récidives.
Option 3 : Autogreffe conjonctivale par rotation. Cette méthode n’est peut-être pas nécessaire dans tous les cas, mais elle est la moins susceptible d’entraîner une récidive. C’est aussi la technique qu’on devrait pratiquer le plus souvent.
Pour réaliser une autogreffe conjonctivale par rotation, il faut d’abord mesurer le défaut épithélial conjonctival et la quantité de sclérotique nue à couvrir. Ensuite, prélever la conjonctive à environ 90 degrés ou 3 à 4 heures d’horloge du site réséqué, généralement dans le globe supérieur, à l’aide de ciseaux de Wescott. Disséquer la conjonctive de la capsule de Tenon sous-jacente jusqu’à ce qu’elle corresponde à la surface du ptérygion. Créer un lambeau pédiculé et le faire pivoter vers le bas pour couvrir la zone. Coller ou suturer le lambeau au lit avec du vicryl8-0. Si vous utilisez de la colle, essayez d’en mettre le moins possible. En postopératoire, prescrire des gouttes d’antibiotiques topiques tels qu’unefluoroquinolone q.i.d. pendant une semaine, et des gouttes de stéroïdes tels que l’acétate de prednisolone q.i.d., en diminuant progressivement sur une période de un à trois mois.
En ce qui concerne la stabilité du greffon, le collage et la suture apportent la plus grande tranquillité d’esprit. Une troisième technique, le coagulum sanguin autologue in situ, fonctionnera également si on n’a pas accès à de la colle et qu’on dispose de 10 minutes supplémentaires pour maintenir la pression sur le site. Le saignement naturel de la patiente dans la région coagulera et ancrera la membrane amniotique; cependant, on ne peut être aussi sûr qu’avec la colle ou la suture que le tissu sera toujours adhérent après un jour ou une semaine. En outre, la colle et le fil de suture coûtent cher, mais ce qui coûte le plus cher, c’est le temps passé dans la salle d’opération, maintenir un tissu avec ses doigts pendant 10 minutes est assez onéreux.
La récidive est la complication postopératoire la plus grave de l’excision du ptérygion. En outre, il faut se préoccuper de la cicatrisation. L’incision de l’œil génère du tissu cicatriciel et il faut donc veiller à ne pas se retrouver avec un enchevêtrement de fibres. C’est tout à fait possible, surtout en cas d’interventions multiples.
Les autres complications possibles sont la fonte sclérale due à l’utilisation de la mitomycine C, la fibrose, en particulier autour du muscle extraoculaire à cet endroit, l’infection, qui est rare, et l’inconfort de la surface oculaire, qui peut durer des semaines, voire des mois. En général, les stéroïdes aident à soulager l’inconfort, mais nous encourageons également l’utilisation de gouttes lubrifiantes. Garder ces complications à l’esprit lors de l’élaboration de la stratégie chirurgicale.
Le ptérygion : Techniques et choix chirurgicaux
On sait que le ptérygion existe depuis plus de 3 000 ans39 Les anciens Égyptiens et Grecs appliquaient des potions composées de divers produits chimiques sur la surface oculaire pour tenter d’éradiquer la lésion. La première documentation d’une excision chirurgicale date d’environ 500 à 1 000 ans avant J. C. (par Susruta), semblable à l’excision de la sclérotique nue d’aujourd’hui. Elle était suivie de l’application d’une pommade pour prévenir les récidives1. Le concept de récidive après l’ablation d’un ptérygion nous est connu depuis longtemps. Malgré les progrès de l’instrumentation chirurgicale, des microscopes, des matériaux de suture et des médicaments, ainsi que des techniques développées, étudiées et testées en recherche clinique dans le monde entier, la récidive du ptérygion est toujours un sujet de préoccupation plusieurs millénaires plus tard. La « technique idéale » présentant le moins de risques de récidive et le meilleur profil d’effets secondaires n’a toujours pas été trouvée.
Phathanthurarux et Chantaren2 ont mené une enquête en Thaïlande et examiné les perspectives et les pratiques des ophtalmologistes dans leur pays. Ils ont entrepris d’identifier les principaux obstacles, d’explorer la pratique idéale et d’étudier les facteurs sous-jacents à ces pratiques. Dans leur questionnaire, auquel ont répondu plus de 400 personnes, les méthodes les plus pratiquées étaient la technique de la sclérotique nue et l’autogreffe conjonctivale dans les cas de ptérygions primaires et récurrents. Dans les deux types de ptérygions, la majorité des personnes interrogées ont indiqué qu’elles n’envisageraient pas de traitement adjuvant, ce qui a été attribué aux préoccupations concernant les complications potentielles et au manque général d’expérience avec les techniques chirurgicales.
Phathanthurarux et Chantaren ont également souligné les problèmes liés au manque d’accessibilité ou de disponibilité des membranes amniotiques et au coût relativement élevé de la colle de fibrine (ce qui est pertinent dans le contexte des économies ou des pratiques moins riches de la région Asie-Pacifique). Dans leur enquête, la récurrence du ptérygion était la complication postopératoire tardive la plus fréquente, signalée par plus des trois quarts des personnes interrogées. Bien que l’étude n’ait pas mesuré directement les taux de récidive réels, le nombre élevé de personnes interrogées confrontées à une récidive était conforme aux rapports antérieurs faisant état de taux de récidive élevés similaires attendus lors de l’excision primaire du ptérygion avec des techniques de sclérose nue3
Au cours des derniers millénaires, les ophtalmologistes ont cherché la méthode idéale pour traiter les ptérygies primaires et récurrentes. Les techniques les plus couramment employées comprennent les diverses greffes conjonctivales avec ou sans tissu limbique4-6, fixées avec des sutures absorbables ou non, de la colle de fibrine ou même du sang ou de la fibrine autologue7,8. La bêta-irradiation est rarement ou jamais pratiquée de nos jours, alors que les antimétabolites tels que la mitomycine C (MMC) et le 5 fluorouracile ont gagné en popularité par rapport à d’autres. Divers modes d’application ont été utilisés, soit en intra-opératoire sous forme de dose unique, soit en postopératoire sous forme d’injections ou de gouttes sous-conjonctivales, en adoptant des concentrations et des durées de traitement différentes.
La MMC utilisée en association avec des greffes de tissus dans des études randomisées et contrôlées réduirait les récidives de ptérygion9. Cependant, les inquiétudes concernant les complications potentielles, notamment le retard de cicatrisation conjonctivale, la scléromalacie et la sclérite nécrosante, peuvent tenir certains chirurgiens à l’écart.
Outre la nature du ptérygion, d’autres facteurs importants dans la détermination du traitement adjuvant sont l’expérience du chirurgien, le temps opératoire disponible, la nécessité de préserver la conjonctive normale ou la disponibilité limitée des tissus. Ces facteurs sont particulièrement importants pour les patients souffrant de ptérygion récurrent et ceux dont le glaucome est mal contrôlé, qui peuvent nécessiter des procédures de drainage ultérieures.
La membrane amniotique a été utilisée comme alternative à la conjonctive en tant que matériau de greffe, agissant comme un substrat de greffe. Des études antérieures sur l’utilisation de la membrane amniotique pour le ptérygion primaire ont fait état d’un taux de récidive élevé, supérieur à 60 %10, tandis que des études ultérieures ont donné des taux de récidive plus acceptables, compris entre 13,8 % et 18,6 % 6 à 12 mois après l’excision du ptérygion primaire11,12 Clearfield et coll. ont analysé systématiquement 20 essais contrôlés randomisés portant sur plus de 1 900 yeux et ont conclu que la membrane amniotique était inférieure à l’autogreffe conjonctivale pour prévenir la récidive du ptérygion13. Cependant, l’ajout de MMC peropératoire en combinaison avec la membrane amniotique a amélioré le taux de récidive à 5,8 % pour une période de suivi moyenne de 17 mois14
Le MMC est un antimétabolite qui inhibe la prolifération et la migration des cellules du ptérygion15,16. Ce médicament a été largement étudié commeadjuvant dans la chirurgie du ptérygion, avec des rapports antérieurs sur la fonte sclérale allant de 3 % à 19 %9. Ce taux pourrait être considérablement réduit, avec des taux de récurrence acceptables,en appliquant un protocole standard défini, et ce, même sans greffe conjonctivale simultanée16. En plus de préserver la conjonctive saine environnante, l’opération est également plus courte que dans les situations où le prélèvement d’un greffon conjonctival est nécessaire, en particulier si on utilise des sutures pour fixer les greffons au lieu de la colle de fibrine et entre les mains de chirurgiens moins expérimentés ou d’apprentis chirurgiens.
L’administration sous-conjonctivale d’un facteur de croissance endothélial vasculaire (anti-VEGF) comme adjuvant dans la chirurgie du ptérygion a été évaluée dans une poignée de méta-analyses avec des conclusions contradictoires17,18. Malgré l’innocuité globalement raisonnable du bévacizumab, des essais cliniques mieux conçus évaluant l’efficacité de l’anti-VEGF sont justifiés. En outre, le coût relativement élevé de l’anti-VEGF peut être un facteur prohibitif dans les économies ou les pratiques moins riches.

Une stratégie récente dans la chirurgie du ptérygion consisterait à utiliser une mini-transplantation épithéliale limbique simple (mini-SLET). La technique initiale de SLET a été développée pour traiter l’insuffisance unilatérale de cellules souches limbiques;19 une adaptation de cette technique a été appliquée à d’autres affections de la surface oculaire telles que la néoplasie malpighienne de la surface oculaire et le ptérygion. Quelques études publiées ont évalué l’utilisation de la mini-SLET ou de la SLET dans la chirurgie du ptérygion avec des résultats prometteurs20-22 Des données supplémentaires provenant d’études plus importantes et, de préférence, d’essais contrôlés sont nécessaires pour pouvoir évaluer les mérites de cette technique.
En conclusion, il n’existe pas encore de panacée dans le traitement du ptérygion. Les remarques de Phathanthurarux et Chantaren soulignent l’importance pour les chirurgiens d’apprécier les complications potentielles de chaque modalité de traitement et la nécessité d’acquérir une expérience approfondie des différentes approches. Ce n’est qu’à ce moment-là que l’on pourra mener une discussion avec le patient et décider d’un plan de traitement approprié pour cette personne en particulier. Cette démarche peut être facilitée par une amélioration de l’éducation et de la formation, peut-être par une meilleure conception des programmes d’études et/ou des cours de chirurgie locaux ou régionaux, afin de diffuser les connaissances et l’expérience dans les domaines qui en ont le plus besoin.
1. Murube J. Pterygium: evolution of medical and surgical treatments. Ocul Surf 2008; 6:155–161.
2. Phathanthurarux S, Chantaren P. A survey of surgical techniques in Pterygium, Thailand 2016. Asia Pac J Ophthalmol (Phila) 2019; 8:476–480.
3. Sanchez-Thorin JC, Rocha G, Yelin JB. Meta-analysis on the recurrence rates after bare sclera resection with and without mitomycin C use and conjunctival autograft placement in surgery for primary pterygium. Br J Ophthalmol 1998; 82:661–665.
4. Young AL. The use of conjunctival rotational autograft in the management of Pterygium. Asia Pac J Ophthalmol (Phila) 2013; 2:209–210.
5. Young AL, Ho M, Jhanji V, Cheng LL. Ten-year results of a randomized controlled trial comparing 0.02% mitomycin C and limbal conjunctival autograft in pterygium surgery. Ophthalmology 2013; 120:2390–2395.
6. Young AL, Cao D, Chu WK, et al. The evolving story of pterygium. Cornea 2018; 37: suppl 1: S55–S57.
7. Uy HS, Reyes JM, Flores JD, Lim-Bon-Siong R. Comparison of fibrin glue and sutures for attaching conjunctival autografts after pterygium excision. Ophthalmology 2005; 112:667–671.
8. Misra S, Craig JP, McGhee CN, Patel DV. A prospective study of pterygium excision and conjunctival autograft with human fibrin tissue adhesive: effects on vision, refraction, and corneal topography. Asia Pac J Ophthalmol (Phila) 2014; 3:202–206.
9. Kaufman SC, Jacobs DS, Lee WB, et al. Options and adjuvants in surgery for pterygium: a report by the American Academy of Ophthalmology. Ophthalmology 2013; 120:201–208.
10. Essex RW, Snibson GR, Daniell M, Tole DM. Amniotic membrane grafting in the surgical management of primary pterygium. Clin Exp Ophthalmol 2004; 32:501–504.
11. Marsit N, Gafud N, Kafou I, et al. Safety and efficacy of human amniotic membrane in primary pterygium surgery. Cell Tissue Bank 2016; 17:407–412.
Une nouvelle approche émerge pour la chirurgie du ptérygion
Sutures et colle
Sutures : Les autogreffes conjonctivales utilisant des sutures sont « l’étalon-or », a déclaré Lawrence W. Hirst, MBBS40 L’avantage est que les greffes sont stables et que le taux de récidive (environ 15 %) correspond à la référence, a déclaré le Dr Hirst, directeur du Queensland Eye Institute à South Brisbane, en Australie. Quant au résultat esthétique, il est « acceptable, mais pas merveilleux », a-t-il ajouté.
En revanche, l’opération elle-même peut durer de 30 à 40 minutes, selon le Dr Hirst, et les problèmes liés aux sutures comprennent l’inconfort postopératoire, l’inflammation chronique et la formation de granulomes.
Colle de fibrine : Les ophtalmologistes utilisent la fibrine pour diverses interventions chirurgicales, notamment pour la greffe de cornée lamellaire et la fermeture de perforations cornéennes.
12. Toker E, Eraslan M. Recurrence after primary pterygium excision: amniotic membrane transplantation with fibrin glue versus conjunctival autograft with fibrin glue. Curr Eye Res 2016; 41:1–8.
13. Clearfield E, Hawkins BS, Kuo IC. Conjunctival autograft versus amniotic membrane transplantation for treatment of pterygium: findings from a cochrane systematic review. Am J Ophthalmol 2017; 182:8–17.
14. Rosen R. Amniotic membrane grafts to reduce pterygium recurrence. Cornea 2018; 37:189–193.
15. Cao D, Chu WK, Ng TK, et al. Cellular proliferation and migration of human pterygium cells: mitomycin versus small-molecule inhibitors. Cornea 2018; 37:760–766.
16. Lam DS, Wong AK, Fan DS, et al. Intraoperative mitomycin C to prevent recurrence of pterygium after excision: a 30-month follow-up study. Ophthalmology 1998; 105:901–904. discussion 4-5.
17. Hu Q, Qiao Y, Nie X, et al. Bevacizumab in the treatment of pterygium: a meta-analysis. Cornea 2014; 33:154–160.
18. Zeng W, Liu Z, Dai H, et al. Anti-fibrotic, anti-VEGF or radiotherapy treatments as adjuvants for pterygium excision: a systematic review and network meta-analysis. BMC Ophthalmol 2017; 17:211.
19. Sangwan VS, Basu S, MacNeil S, Balasubramanian D. Simple limbal epithelial transplantation (SLET): a novel surgical technique for the treatment of unilateral limbal stem cell deficiency. Br J Ophthalmol 2012; 96:931–934.
20. Boutin T, Mednick Z, Zhou TE, et al. Simple limbal epithelial transplantation to treat recurring kissing pterygium. Can J Ophthalmol 2019; 54:e54–e57.
21. Hernandez-Bogantes E, Amescua G, Navas A, et al. Minor ipsilateral simple limbal epithelial transplantation (mini-SLET) for pterygium treatment. Br J Ophthalmol 2015; 99:1598–1600.
22. Mednick Z, Boutin T, Einan-Lifshitz A, et al. Simple limbal epithelial transplantation for recurrent pterygium: a case series. Am J Ophthalmol Case Rep 2018; 12:5–8.
Plus récemment, l’utilisation de la colle de fibrine pour les autogreffes conjonctivales sans suture a fait des progrès significatifs. « La colle est plus rapide et plus simple, et elle fonctionne la plupart du temps », a déclaré le Dr Hirst. La durée de l’intervention chirurgicale est d’environ la moitié de celle de l’approche traditionnelle avec suture, et les patients signalent moins de douleurs et d’inconfort postopératoires.
Cependant, la colle elle-même est plus chère que les sutures, et il peut être difficile de se la procurer dans certains pays. Et comme la colle de fibrine est un produit dérivé du sang, elle comporte un risque potentiel de transmission de maladies virales et de maladies à prions. Du point de vue du Dr Hirst, le risque de transmission de maladies est toutefois essentiellement théorique. Il y a un certain pourcentage d’échec avec les greffes collées, pas de déhiscence totale, mais des cas où il faut intervenir et réparer quelque chose.
Qu’en est-il de la récidive ? Théoriquement, le taux devrait être plus faible avec la colle de fibrine, étant donné sa capacité à réduire l’inflammation. Néanmoins, le taux semble se situer entre 10 et 15 %, selon le Dr Hirst. Et personne n’a évalué efficacement les résultats esthétiques de la colle.
Avantage : La colle? Dans une méta-analyse publiée l’année dernière, les auteurs affirment que la colle de fibrine est supérieure aux sutures, car la colle entraîne une réduction du risque de récidive sans augmentation apparente du risque de complications.
Avantage : Les sutures? Cependant, une autre approche, développée par le Dr Hirst, a conduit certains chirurgiens à privilégier les sutures. Dans cette technique, l’excision, de 12 à 14 mm sur 13 à 15 mm en moyenne, est nettement plus large que d’habitude et implique une ablation importante de la couche de Tenon. « Je procède à une reconstruction de l’œil pour que les lignes de suture soient cachées », explique le Dr Hirst, qui appelle son intervention « Pterygium Extended Removal Followed by Extended Conjunctival Transplant » ou P.E.R.F.E.C.T. (ablation étendue du ptérygion suivie d’une transplantation conjonctivale étendue).
Sécurité et efficacité de l’ablation élargie du ptérygion suivie d’une transplantation conjonctivale élargie en cas de ptérygion récurrent
Objectif : Étudier la sécurité et l’efficacité de l’ablation étendue du ptérygion suivie d’une greffe conjonctivale étendue en cas de ptérygion récurrent41
Méthodes : Trente-trois yeux de 33 sujets présentant un ptérygion récurrent ont été inclus dans cette étude prospective de série de cas. L’ablation du ptérygion suivie d’une transplantation conjonctivale étendue a été réalisée chez tous les sujets. Un seul chirurgien (WA) a effectué toutes les opérations. Tous les sujets ont été suivis pendant au moins 12 mois et ont été évalués pour la récurrence et les complications.
Résultats : L’âge moyen des participants était de 41,2 ± 10,3 ans (intervalle 22-60), 7 femmes (21,2 %). La durée moyenne du suivi était de 25,64 ± 9,24 mois (intervalle 12-43). L’acuité visuelle à distance corrigée (en notation décimale) s’est améliorée, passant de 0,69 ± 0,22 (intervalle 0,2-1,0) à la présentation à une valeur postopératoire de 0,83 ± 0,2 (intervalle 0,3-1,0) un an après l’opération. Aucune récidive n’a été signalée au cours de la période de suivi. Un gonflement transitoire du greffon a été enregistré dans 14 cas (42,4 %) et s’est résorbé dans tous les cas dès la première semaine. Tous les patients ont présenté une diplopie postopératoire transitoire de degré variable qui s’est complètement résorbée au cours des six premières semaines. Un granulome du site donneur s’est développé dans 4 cas (12,1 %). Une résolution spontanée a été observée dans 3 cas, tandis que dans un cas, une excision chirurgicale a été réalisée 2 mois après l’intervention.
Conclusions : Dans cette étude portant sur des yeux présentant une ptérygie récurrente, l’ablation étendue du ptérygion suivie d’une greffe conjonctivale étendue s’est avérée sûre et efficace, sans récidive et avec des complications postopératoires minimes.
Récidive et complications après 1 000 interventions chirurgicales utilisant l’ablation étendue du ptérygion suivie d’une transplantation conjonctivale étendue
Objectif : Documenter le taux de récurrence et le taux de complication de l’ablation étendue du ptérygion suivie d’une transplantation conjonctivale étendue42
Conception : Étude ouverte et prospective de patients consécutifs ayant subi une ablation du ptérygion suivie d’une greffe conjonctivale étendue.
Participants et témoins : L’étude a inclus 1 000 patients consécutifs ayant subi une chirurgie du ptérygion entre août 2001 et septembre 2009.
Interventions : Tous les patients ont subi une ablation étendue du ptérygion suivie d’une transplantation conjonctivale étendue par l’auteur, avec un suivi d’un an.
Principaux critères de jugement : Taux de récidive et de complications.
Résultats : Un suivi de plus d’un an a été obtenu chez 99 % des patients. Il y a eu une récidive sur les 1 000 interventions chirurgicales (0,1 %) avec des intervalles de confiance à 95 % de 0,003 % à 0,56 % (test exact de Fischer). Sept patients ont dû subir une nouvelle intervention chirurgicale : 3 ont eu des remplacements de greffons, et 1 pour une récidive, un strabisme, un kyste d’inclusion et un granulome. Un patient a perdu 4 lignes de vision à cause d’un ulcère cornéen.
Conclusions : L’ablation étendue du ptérygion suivie d’une greffe conjonctivale étendue permet d’obtenir l’un des taux de récidive les plus faibles rapportés dans la littérature mondiale et un taux de complication acceptable.

N’oubliez pas de nous en informer.
Rendez-vous sur le portail de l’AOQ, aoqnet qc ca
Cliquez sur l’onglet MEMBRES en haut à droite et entrez votre nom d’utilisateur passe de mot votre et
Lors de votre connexion, cliquez ensuite sur le petit onglet bleu en haut à droite où apparaîtra votre nom.
Choisissez Mon Profil pour la mise à jour de votre compte

1. https://www.merckmanuals.com/fr-ca/accueil/ troubles-oculaires/maladies-de-la-conjonctive-et-de-lascl%C3%A8re/pingu%C3%A9cula-et-pt%C3%A9rygion
2. https://www.aao.org/eye-health/diseases/pingueculapterygium
3. Weisenthal, Robert W, Afshari, Natalie A, Bouchard, Charles S, Colby, Kathyrn A, Rootman, David S, Tu, Elmer Y, 2013, External Disease and Cornea, AAO, BCSC, Chapter 12, Depositions and Degenerations.
4. Yam JC, Kwok AK. Ultraviolet light and ocular diseases. Int Ophthalmol. 2013 May : 14(2)187-94
5. Ehlers, J.P, Shah, C.P, The Wills eye manual: office and emergency room diagnosis and treatment of eye disease. Lippincott Williams & Wilkins. 2008: (4.9) 66-67.
6. Frucht-Pery J, Solomon A, Siganos CS, Shvartzenberg T, Richard C, Trinquand C. Treatment of inflamed pterygium and pinguecula with topical indomethacin 0.1% solution. Cornea. 1997 Jan;16(1):42-7
7. Ahn SJ, Shin KH, Kim MK, Wee WR, Kwon JW, One-year outcome of argon laser photocoagulation of pinguecula. Cornea. 2013 Jul;32(7):971-5
8. Jeong J, Rand GM, Kwon T, Kwon JW. The Improvement of Dry Eye Symptoms after Pinguecula Excision and Conjunctival Autograft with Fibrin Glue. J Ophthalmol. 2019;2019:6438157. Published 2019 Jun 9. doi:10.1155/2019/6438157
9. https://en.wikipedia.org/wiki/File:Pterygium.jpg
10. https://www.revieweducationgroup.com/ce/addressingpterygium-in-optometric-practice#:~:text=Addressing%20 pterygium%20involves%20a%20range,follow%2Dup%20 may%20be%20appropriate
11. Rezvan F, Khabazkhoob M, Hooshmand E, et al. Prevalence and risk factors of pterygium: a systematic review and meta-analysis. Surv Ophthalmol. 2018;63(5):719-35.
12. Fotouhi A, Hashemi H, Khabazkhoob M, et al. Prevalence and risk factors of pterygium and pinguecula: the Tehran Eye Study. Eye. 2009;23(5):1125-9.
13. Lin SF, Tsai RK, Tung IC, et al. An epidemiologic study of pterygium in middle-aged and elderly aboriginal populations of the Tao Tribe of Orchid Island in Taiwan. Tzu Chi Med J. 2006;18(4):283-6.
14. Moran DJ, Hollows FC. Pterygium and ultraviolet radiation: a positive correlation. Br J Ophthalmol. 1984;68(5):343-6.
15. Chui J, Di Girolamo N, Wakefield D, et al. The pathogenesis of pterygium: current concepts and their therapeutic implications. Ocul Surf. 2008;6(1):24-43.
16. Shahraki T, Arabi A, Feizi S. Pterygium: an update on pathophysiology, clinical features, and management. Ther Adv Ophthalmol. 2021;13: 25158414211020152.
17. Kau HC, Tsai CC, Lee CF, et al. Increased oxidative DNA damage, 8-hydroxydeoxy-guanosine, in human pterygium. Eye. 2006;20(7):826-31.
18. Di Girolamo N, Chui J, Coroneo MT, et al. Pathogenesis of pterygia: role of cytokines, growth factors, and matrix metalloproteinases. Prog in Retin Eye Res. 2004;23(2): 195-228.
19. Kria L, Ohira A, Amemiya T. Immunohistochemical localization of basic fibroblast growth factor, platelet derived growth factor, transforming growth factor-β and tumor necrosis factor-α in the pterygium. Acta Histochemica. 1996;98(2):195-201.
20. Livezeanu C, Craitoiu MM, Manescu R, et al. Angiogenesis in the pathogenesis of pterygium. Rom J MorpholEmbryol. 2011;52(3):837-44.
21. Dushku N, John MK, Schultz GS, et al. Pterygia pathogenesis: corneal invasion by matrix metalloproteinase expressing altered limbal epithelial basal cells. Arch Ophthalmol. 2001;119(5):695-706.
22. Ang LP, Chua JL, Tan DT. Current concepts and techniques in pterygium treatment. Curr OpinOphthalmol. 2007;18(4):308-13.
23. Chalkia AK, Spandidos DA, Detorakis ET. Viral involvement in the pathogenesis and clinical features of ophthalmic pterygium. Int J Mol Med. 2013;32(3):539-43.
24. Rodrigues FW, Arruda JT, Silva RE, et al. TP53 gene expression, codon 72 polymorphism and human papillomavirus DNA associated with pterygium. Genet Mol Res. 2008;7(4):1251-8.
25. https://en.wikipedia.org/wiki/File:Pterygium_ (from_Michigan_Uni_site,_CC-BY).jpg
26. https://en.wikipedia.org/wiki/Pterygium_(eye) :
27. https://www.ncbi.nlm.nih.gov/books/NBK558965/
28. https://en.wikipedia.org/wiki/File:Pterygium.png
29. Tan DT, Chee SP, Dear KB, et al. Effect of pterygium morphology on pterygium recurrence in a controlled trial comparing conjunctival autografting with bare sclera excision. Arch Ophthalmol. 1997;115(10):1235-40.
30. Hirst LW, Sebban A, Chant D. Pterygium recurrence time. Ophthalmology. 1994;101(4):755-8.
31. Batur M, Seven E, Tekin S, et al. The role of anterior segment optical coherence tomography in the evaluation of the pterygium. PhotodiagnosisPhotodyn Ther. 2023;43:103704.
32. Zaki WM, Daud MM, Abdani SR, et al. Automated pterygium detection method of anterior segment photographed images. Comput Methods Programs Biomed. 2018;154:71-8.
33. Maheshwari S. Pterygium-induced corneal refractive changes. Indian J Ophthalmol. 2007;55(5):383.
34. Prabhasawat P, Barton K, Burkett G, et al. Comparison of conjunctival autografts, amniotic membrane grafts, and primary closure for pterygium excision. Ophthalmology. 1997;104(6):974-85.
35. Liu J, Fu Y, Xu Y, et al. New grading system to improve the surgical outcome of multirecurrent pterygia. Arch Ophthalmol. 2012;130(1):39-49.
36. https://en.wikipedia.org/wiki/File:Large_Pterygium.jpg
37. Verma NI, Garap JA, Maris RO, et al. Intraoperative use of mitomycin C in the treatment of recurrent pterygium. P N G Med J. 1998;41(1):37-42.
38. https://www.reviewofophthalmology.com/article/surgicalapproaches-to-pterygium
39. Young AL, Kam KW. Pterygium: Surgical Techniques and Choices. Asia Pac J Ophthalmol (Phila). 2019 NovDec;8(6):422-423. doi: 10.1097/APO.0000000000000269. PMID: 31789641; PMCID: PMC6903369.https://www.ncbi. nlm.nih.gov/pmc/articles/PMC6903369/
40. https://www.aao.org/eyenet/article/new-approachemerges-pterygium-surgery
41. Allam WA, Alagorie AR, Nasef MH, El-Bakary MA. Safety and efficacy of pterygium extended removal followed by extended conjunctival transplant for recurrent pterygia. Int Ophthalmol. 2022 Jul;42(7):2047-2053. doi: 10.1007/ s10792-021-02199-w. Epub 2022 Jan 3. PMID: 34978650.
42, Hirst LW. Recurrence and complications after 1,000 surgeries using pterygium extended removal followed by extended conjunctival transplant. Ophthalmology. 2012 Nov;119(11):2205-10. doi: 10.1016/j.ophtha.2012.06.021. Epub 2012 Aug 11. PMID: 22892149.


PAR MONSIEUR SAMUEL MAUGARD, M.SC., MBA, M.S.I. CONSULTANT, CRÉATION DE VALEUR
SAMUEL.MAUGARD@MNP.CA
514 861-9724
ET MADAME CAROLE MESSAOUDI, M.SC., ACC ASSOCIÉE, LEADER LIGNE DE SERVICE, CONSULTATION QUÉBEC CAROLE.MESSOUDI@MNP.CA
418 693-3300 POSTE 297
Dans un rapport de 20221, le ministère de l’Emploi et de la Solidarité sociale projetait une pénurie de maind’œuvre jusqu’en 2031; à moins d’un ralentissement économique significatif, le paysage professionnel se trouve à la croisée des chemins. Selon le rapport, pour les années 2022-2031, une dynamique distinctive se dessine : la moitié de la main-d’œuvre proviendra des jeunes actuellement aux études, tandis que 24 % sera issue de la population immigrante à venir. Ces données indiquent un changement majeur dans la composition du marché du travail, avec près de 1,6 million d’emplois à pourvoir au cours de cette période en partie par des individus qui ne sont pas encore entrés sur le marché de l’emploi.

Enfin le rapport révèle que 71 % de ces emplois seront comblés pour remplacer les départs à la retraite, soulignant l’importance croissante de la relève dans un contexte de vieillissement de la main d’œuvre. Cependant, il est également remarquable que 29 % de ces emplois seront attribuables à la création nette de postes, illustrant un marché du travail résilient dans une situation économique actuelle incertaine.
1 Ministère de l’Emploi et de la Solidarité sociale – État d’équilibre de main d’œuvre, 2022
Dans ce paysage professionnel en mutation, un élément clé vient s’ajouter à la dynamique du marché du travail : le rapport de force entre la main-d’œuvre et les employeurs penche en faveur des travailleurs. Cette réalité a été analysée par la Commission des partenaires du marché du travail du Ministère de l’Emploi et de la Solidarité sociale2 en 2020 et démontre l’importance accordée par les employés à des éléments essentiels tels que le salaire et les avantages sociaux, qui demeurent les premiers leviers d’attraction, de rétention, et de mobilisation.
La Commission a démontré également qu’au-delà des aspects financiers, la main-d’œuvre attache une grande importance à la responsabilité sociale, au bilan environnemental et à l’éthique d’un employeur. Ces critères influent sur les choix professionnels des travailleurs, soulignant l’importance croissante de la dimension sociale et éthique dans la culture organisationnelle d’une entreprise.
2 Commission des partenaires du marché du travail – Portrait 360 sur les aspirations de la main-d’œuvre, 2020
Par ailleurs, les attentes en matière d’horaires de travail sont diverses, mais convergent vers la recherche d’un équilibre entre stabilité et flexibilité. Cette dualité reflète la nécessité pour les employeurs d’adopter des politiques qui répondent aux besoins variés de la main-d’œuvre, favorisant ainsi un environnement de travail propice à la productivité et à la satisfaction des employés.
Enfin, la Commission souligne que, même à salaires et avantages sociaux équivalents, la reconnaissance, les possibilités de progression et l’ambiance de travail jouent un rôle déterminant dans la mobilisation des travailleurs.

Ainsi, la construction d’une marque employeur solide et attrayante ne se limite pas aux aspects financiers, mais englobe un éventail de facteurs influençant l’expérience globale des employés au sein de l’entreprise.
Les mutations significatives observées dans le domaine des ressources humaines au cours de la dernière décennie sont étroitement liées à l’évolution du marché du travail que nous avons précédemment exposée.
En ce début de 2024, l’incertitude ambiante teinte toutefois la pénurie de main-d’œuvre, tandis que les salaires ont augmenté en raison de l’inflation, selon le rapport3 du 3e trimestre 2023 de l’Institut de la statistique du Québec. Les postes vacants au Québec indiquent une diminution, probablement due à la situation économique particulière, notamment en lien avec les taux directeurs élevés qui se sont répercutés sur la consommation et les grands projets au Québec en 2023. Par ailleurs, une baisse du taux de postes vacants a été observée dans 11 régions entre le 3e trimestre 2022 et celui de 2023, avec une diminution de plus de deux points dans quatre d’entre elles, à savoir Chaudière-Appalaches (-2,4 points), Capitale-Nationale (-2,3 points), Montérégie (-2,3 points) et Centre-du-Québec (-2,2 points). Malgré ces défis, le secteur des ressources humaines continue de s’adapter à cette réalité, cherchant des solutions pour optimiser le recrutement et la gestion des postes vacants.
Du côté du secteur de l’optométrie, l’initiative du gouvernement Opération main-d’œuvre en cours a pour objectif de résoudre la pénurie de main-d’œuvre dans des domaines prioritaires par l’adoption de mesures ciblées. Bien que ces mesures ne puissent résoudre toutes les problématiques de main d’œuvre, il est crucial de mettre l’accent sur le marketing RH pour attirer les candidats et renforcer la fidélisation des employés actuels.
En cette période charnière de 2024, où les enjeux économiques et les initiatives gouvernementales influent sur le marché de l’emploi, le secteur des ressources humaines s’adapte avec agilité. Les professionnels de ce domaine sont confrontés à un double défi : la pénurie de main-d’œuvre exacerbée par une conjoncture économique complexe et les transformations post-pandémie dans le secteur du travail. Cette dualité crée un contexte exigeant, incitant les acteurs des ressources humaines à repenser leurs stratégies pour attirer, retenir et développer les talents.
Dans ce paysage en mutation, les entreprises sont appelées à adopter des approches novatrices pour relever ces défis. Le recours accru aux technologies émergentes, telles que l’intelligence artificielle dans le processus de recrutement, se profile comme une réponse possible à la nécessité de pourvoir les postes vacants de manière efficace. De plus, la mise en place de formations ciblées et flexibles contribue à développer des compétences adaptées aux besoins changeants du marché.
Cependant, au-delà des solutions techniques, la dimension humaine demeure au cœur des préoccupations. Les entreprises cherchent à entretenir une culture d’entreprise attrayante, axée sur la transparence et l’épanouissement professionnel, afin d’attirer des candidats partageant leurs valeurs. Ce nouvel équilibre entre technologie et humanité se dessine comme un pivot essentiel pour réussir dans un environnement où l’adaptabilité et l’innovation deviennent des maîtres-mots.
Au cœur de cette métamorphose émerge la notion de « marketing RH ». Cette approche repose sur une analyse approfondie de l’offre et de la demande sur le marché de l’emploi. Un marché, qui représente l’offre d’un côté avec l’employeur en tant que produit, et la demande constituée par les candidats et employés en tant que consommateurs de l’autre côté, devient le terrain d’application de stratégies marketing.

Dans cette perspective, les candidats évaluent les employeurs comme des produits, recherchant des critères tels qu’une image de marque forte et distinctive (le packaging), des conditions de travail adaptées à leur réalité (la garantie), un salaire compétitif (le prix), ainsi que des expériences « candidat » et employé positives (les bénéfices du produit).
Cette analogie souligne la nécessité pour les employeurs d’adopter des stratégies de marketing afin de se positionner de manière attrayante pour les candidats et de fidéliser leurs employés. Éviter le décalage entre la réalité vécue par les employés et l’image projetée devient crucial, et c’est là qu’intervient la collaboration entre consultants en RH et en marketing.
Cette collaboration assure une approche globale qui prend en compte à la fois les dimensions externes et internes de l’entreprise. Cette approche vise à façonner une gestion des ressources humaines en harmonie avec les valeurs et le bien-être des employés, tout en établissant une communication en adéquation avec cette réalité par la marque employeur.
Chez MNP nous avons des experts qui pourront vous fournir tous les outils nécessaires afin de vous aider à naviguer à travers ces défis.

dans l’élaboration d’une



Les vices de construction : quand la copropriété donne des maux de tête
La gestion des vices cachés en copropriété peut s’avérer assez complexe, surtout lorsque ces vices affectent les parties communes de l’immeuble et découlent de sa construction. Un récent reportage de l’émission La Facture1 a d’ailleurs exposé la triste réalité que vivent de nombreux propriétaires de condo à Boisbriand dont l’immeuble est affecté d’importantes pourritures en raison d’une mauvaise construction. Quelle est la responsabilité du syndicat dans ces situations et quels sont les recours possibles ?
En présence d’un vice de construction qui affecte les parties communes de l’immeuble, le Code civil du Québec2 octroi au syndicat de copropriété l’intérêt juridique d’agir au nom de l’ensemble des copropriétaires. Le syndicat ayant l’obligation d’assurer la conservation de l’immeuble3, il doit obtenir les expertises et les évaluations nécessaires relativement aux vices constatés et exiger du constructeur que les travaux correctifs nécessaires soient effectués. De plus, selon la loi, une responsabilité sans faute incombe au syndicat, soit celle d’être imputable des dommages causés aux copropriétaires par le vice de construction4, tout en maintenant la possibilité de se retourner contre le constructeur.
Les démarches du syndicat doivent être entreprises par le conseil d’administration et devront débuter par la transmission d’une lettre de dénonciation écrite au constructeur, au plus tard six mois après la découverte des déficiences. Celui-ci pourra dès lors se déplacer sur les lieux pour effectuer ses propres constatations.
Bien que la situation puisse se régler positivement en collaboration des parties, il arrive bien souvent que l’entrepreneur refuse de donner suite aux demandes du syndicat. Également, dans les cas de vices de construction complexes, plusieurs intervenants peuvent se lancer la balle et tenter de se décharger de leurs obligations, une situation qui peut durer des mois, voire des années.
Dans ces cas, le syndicat devra envoyer une mise en demeure au constructeur lui enjoignant d’effectuer les correctifs nécessaires dans un délai imparti. Évidemment, avant de transmettre une telle lettre, le syndicat devra se munir de ses propres expertises et soumissions qui lui permettront de cerner les enjeux et d’évaluer les coûts afférents.
Face à l’inaction des intervenants impliqués, le syndicat pourra alors décider d’entreprendre les travaux. En effet, certaines déficiences peuvent risquer d’entraîner une détérioration de l’immeuble. Pensons par exemple à un défaut d’installation d’une toiture qui coule. En vertu de son obligation d’assurer la conservation et l’entretien de l’immeuble, le syndicat ne peut permettre que l’infiltration perdure pendant de nombreux mois et se doit d’agir.
Dans certains cas, les fonds nécessaires pour effectuer les travaux seront prélevés à même le fonds de prévoyance.
1 Épisode du 28 novembre 2023 : https://ici.radio-canada.ca/tele/la-facture/site/ episodes/845148/condos-boisbriand-covid-longue-investissementfacebook-retrofacturation
2 Article 1081 C.C.Q.
3 Article 1039 C.C.Q.
4 Article 1077 C.C.Q.
Dans d’autres cas plus coûteux, une cotisation spéciale devra être assumée par les copropriétaires. Ces cotisations peuvent s’élever à plusieurs milliers de dollars par copropriétaire, leur imposant ainsi une énorme charge financière imprévue lors de l’achat de leur unité.
Recours du syndicat de copropriété
Que le syndicat ait décidé d’entreprendre les travaux ou d’attendre, il devra protéger les droits des copropriétaires en déposant une demande en justice contre le constructeur dans les trois ans de la découverte des problèmes. Les démarches judiciaires seront alors entamées et peuvent malheureusement durer plusieurs années. Précisons que le délai de trois ans pour déposer une action judiciaire débute à compter de la connaissance des vices et non pas de la date de construction de l’immeuble. Le syndicat aura le fardeau de démontrer, par l’entremise de ses expertises, que l’entrepreneur n’a pas agi selon les règles de l’art dans le domaine de la construction, par exemple que les déficiences représentent des non-conformités au Code du bâtiment pour l’année de construction de l’immeuble.
Si un jugement favorable est rendu, il faudra alors faire exécuter le jugement. L’exécution du jugement est parfois difficile en raison de la volatilité des entreprises œuvrant dans le domaine de la construction. En effet, il arrive bien trop souvent que ceux-ci aient fait faillite ou aient cessé leurs activités lorsque le jugement est rendu. La lourde charge financière devra alors être assumée par les copropriétaires. Ces derniers pourraient bénéficier de certaines couvertures.
Par exemple, dans l’éventualité où l’immeuble est une construction neuve protégée par la Garantie Construction Résidentielle (« GCR »), il existe une couverture pour les vices de construction découverts dans les cinq ans de la fin des travaux.
Également, il est possible de présenter une réclamation au cautionnement de licence auprès de la Régie du bâtiment du Québec. En effet, tout entrepreneur en construction détenteur d’une licence doit obligatoirement avoir cautionné une somme auprès de la RBQ visant à garantir l’exécution de ses obligations auprès de ses clients. Cette caution vise à indemniser les clients lésés en raison d’inexécution de travaux ou de vices de construction. Il existe cependant des limites de délais et de montant applicables à l’indemnisation qui pourraient rendre certaines situations inadmissibles.
Lorsqu’il s’agit de vices de construction affectant les parties communes du bâtiment, dans l’éventualité où le syndicat néglige ses responsabilités et manque de diligence pour la prise en charge des travaux nécessaires, les copropriétaires ne peuvent évidemment pas les faire eux mêmes. Ces derniers doivent enjoindre au syndicat d’entreprendre les travaux nécessaires afin d’empêcher la détérioration de l’immeuble. Cette démarche doit être effectuée par la transmission d’une mise en demeure au conseil d’administration. Les copropriétaires peuvent ensuite s’adresser aux tribunaux pour obtenir une injonction forçant le syndicat à agir.
Cette procédure peut s’avérer très longue et coûteuse. Les copropriétaires pourront également engager la responsabilité du conseil d’administration s’ils subissent des dommages en raison de son inaction, d’où la nécessité de contracter une bonne assurance responsabilité civile pour les administrateurs.
Les copropriétaires ayant acheté leur unité avec la garantie légale possèdent un recours envers le copropriétaire antérieur, considérant que les vices de construction étaient présents au moment de la transaction. Ce recours vise à réclamer de l’ancien copropriétaire sa contribution aux travaux par le paiement de la cotisation spéciale. Toutefois, ce recours aura pour effet d’imposer la lourde charge financière à un autre copropriétaire plutôt qu’au réel responsable : le constructeur.
En guise de conclusion, mieux vaut être diligent et prudent lors de l’achat d’une copropriété. Le fait d’effectuer une recherche sur le constructeur et ses antécédents judiciaires ou sur les plaintes déposées contre lui à la Régie du bâtiment, et de mandater un expert pour une inspection des lieux peut réduire le risque de rencontrer des problèmes, sans toutefois les éliminer entièrement.
Si vous avez des questions sur ce sujet ou sur toute autre question juridique, vous pouvez communiquer avec les avocats de votre ligne d’assistance téléphonique juridique gratuite du lundi au vendredi de 8 h à 18 h en composant le 1 877 579-7052.



La capsulotomie YAG est sûre et efficace lorsqu’elle est pratiquée par des optométristes
Lors d’une enquête réalisée après l’intervention, 99 % des participants ont constaté une amélioration de leur vision.
L’acuité visuelle de Snellen est passée d’une moyenne de 20/40 à 20/23, sans qu’aucune complication sérieuse n’ait été signalée.
Les patients ayant subi une capsulotomie au laser YAG réalisée par un optométriste ont vu leur acuité visuelle s’améliorer sans complications graves, selon une étude publiée dans Optometry and Vision Science
« Cette étude démontre que les capsulotomies peuvent être réalisées efficacement et en toute sécurité par des docteurs en optométrie avec un risque minimal pour les patients et un bénéfice significatif pour la fonction visuelle, et fournit des preuves pour soutenir l’utilisation de la capsulotomie YAG dans la pratique optométrique », écrivent Nathan Lighthizer, OD, FAAO, du Collège d’optométrie de l’Université d’État du Nord-Est de l’Oklahoma, et ses collègues.
Les chercheurs ont constaté que les capsulotomies YAG sont sûres et efficaces lorsqu’elles sont pratiquées par des optométristes.
Les chercheurs ont mené une étude prospective sur 92 yeux de 79 patients diagnostiqués avec une opacification de la capsule postérieure dans six cliniques d’optométrie de soins primaires. Tous les participants avaient une acuité visuelle de Snellen réduite (pire que 20/40) et des plaintes visuelles subjectives.
Les optométristes ont enregistré l’acuité visuelle à distance corrigée, la PIO, l’épaisseur maculaire et les défauts du cristallin avant de procéder à la capsulotomie au laser Nd:YAG 1 064 nm, et ont revérifié la PIO une heure après l’intervention. Des visites de suivi ont été programmées après 1 semaine, 1 mois et 3 mois, au cours desquelles on a demandé aux participants s’ils avaient ressenti une amélioration subjective de leur vision.
Au départ, l’acuité visuelle moyenne était de 0,302 logMAR ± 0,208 (acuité de Snellen de 20/40), et s’est améliorée à 0,058 ± 0,07 logMAR (20/23) lors de la visite de suivi à un mois. Si l’on inclut ceux qui ont terminé le suivi à 3 mois (n = 69), l’acuité visuelle moyenne avant l’intervention était de 0,305 logMAR ± 0,214 (20/41), qui s’est améliorée à 0,054 logMAR ± 0,069 (20/23; P < 0,001 pour tous).
Les chercheurs ont également rapporté une épaisseur maculaire centrale moyenne de 252,9 microns au départ, qui est passée à 252,7 microns après l’intervention, une différence non significative.
Lorsqu’on leur a demandé, dans le cadre d’une enquête après l’intervention, si leur vision s’était améliorée, 99 % des participants ont fait état d’une amélioration subjective de leur vision.
Seuls quatre participants ont connu une augmentation de la PIO supérieure à 5 mm Hg après l’intervention, et aucun n’a connu d’inflammation significative, de corps flottants dans le vitré, d’œdème cornéen, d’œdème maculaire cystoïde, de décollement de la rétine ou de perte de vision permanente.
« D’après les résultats de cette étude, les capsulotomies au laser YAG sont des traitements efficaces pour améliorer la vision des patients et peuvent être réalisées en toute sécurité et de manière efficace par des optométristes », écrivent Lighthizer et ses collègues.
Source : https://www.healio.com/news/optometry/20230907/yag-capsulotomysafe-effective-when-performed-by-optometrists

Quelles sont les causes de la conjonctivite ?
Une panoplie d’agents pathogènes, selon une étude
Malgré l’utilisation courante d’antibiotiques, la plupart des cas sont dus à des virus et le pus n’est généralement pas un signe bactérien.
Une étude transversale a montré que les agents pathogènes associés à la conjonctivite infectieuse aiguë variaient d’une région à l’autre.
Parmi 52 patients provenant de quatre sites aux États-Unis et d’un site en Israël, le séquençage profond de l’ARN a révélé la présence de l’espèce D de l’adénovirus humain chez un quart des patients. Un large éventail d’agents pathogènes, dont le coronavirus humain 229E, le SARS-CoV-2 et le virus de l’herpès simplex de type 1, a également été identifié, ont rapporté Thuy Doan, MD, Ph. D., de l’Université de Californie à San Francisco, et ses collègues.
Parmi ces patients, 62 % présentaient un écoulement purulent, souvent considéré comme un signe d’infection bactérienne, mais la conjonctivite bactérienne n’a été confirmée que chez 8 % d’entre eux. La majorité d’entre eux (54 %) étaient infectés par des virus, qui ne répondent pas aux antibiotiques, notent les auteurs dans la revue JAMA Ophthalmology
« Cette étude démontre qu’il est plus difficile de prédire les agents pathogènes en fonction de la présentation clinique que nous ne le pensions », a déclaré Gerami D. Seitzman, MD, également de l’Université de Californie à San Francisco, coauteur de l’étude. « Le profil local des agents pathogènes varie en fonction de la géographie. Dans certains endroits, il s’agira d’une infection virale, mais dans d’autres, ce seront des agents pathogènes auxquels le médecin n’avait pas pensé ».
La conjonctivite reste un problème de santé publique. Par exemple, le Pakistan a récemment fermé plus de 50 000 écoles avec plus de 300 000 cas de conjonctivite documentés. L’étiologie est actuellement inconnue.
Cette étude remet en question les croyances traditionnelles sur la conjonctivite. « On nous enseigne classiquement que la majorité des cas de conjonctivite sont d’origine virale, bien que les agents pathogènes en cause soient rarement confirmés. En outre, on nous enseigne, et nous l’enseignons, que si un patient présente des larmoiements, l’étiologie est plus probablement virale. Et s’il présente un écoulement purulent, il est plus probable qu’il s’agisse d’une bactérie ».
« Mais il s’avère que les causes pathogènes varient considérablement d’un endroit à l’autre », a-t-il ajouté.
Le coauteur de l’étude, le docteur Edmund Tsui, du Stein Eye Institute de l’UCLA à Los Angeles, a déclaré à MedPage Today que le test ARN utilisé dans l’étude n’était pas encore prêt pour le grand public.
« Les assurances ne le couvrent pas encore, car il ne s’agit pas d’un test clinique pour les maladies infectieuses oculaires, a-t-il expliqué. Avec le temps, cette technologie deviendra moins coûteuse et plus facilement accessible. Elle est idéale pour la surveillance parce qu’elle est “impartiale”. Cela signifie que le séquençage permet de détecter tout agent pathogène présent dans l’échantillon. Dans le cas de la culture ou de la PCR [réaction en chaîne par polymérase], le médecin doit « deviner » quel milieu ou quelles amorces tester ».
Anat Galor, MD, MSPH, ophtalmologue à l’université de Miami, qui n’a pas participé à cette étude, a fait l’éloge de la recherche dans une interview accordée à MedPage Today, notant que les résultats soulignent la nécessité d’améliorer les tests pour la conjonctivite.
« Notre diagnostic clinique est bon, mais pas excellent. Tous ceux qui pensaient avoir raison à 100 % devraient lire ce document, a-t-elle ajouté. Heureusement, la plupart des conjonctivites sont spontanément résolutives. Mais les tests de diagnostic permettront de traiter plus facilement la maladie et de déterminer qui doit être renvoyé chez lui pour éviter de contaminer d’autres personnes ».
En ce qui concerne l’amélioration des tests, Mme Galor reconnaît que les tests de séquençage profond de l’ARN ne sont pas encore utilisables en clinique, mais elle ajoute que le développement de meilleurs tests suscite beaucoup d’intérêt.
Pour l’avenir, M. Tsui a souligné que « la conjonctivite pourrait être l’un des premiers signes d’une épidémie ou d’une pandémie ». (M. Seitzman a fait remarquer que la COVID-19 a été détectée pour la première fois par un ophtalmologiste. L’ophtalmologiste chinois, à qui l’on attribue la diffusion de la maladie, est décédé des suites de la COVID-19 après avoir été censuré par le gouvernement).
« La surveillance publique est importante, et il est important de prêter attention aux maladies oculaires infectieuses », a ajouté M. Tsui.
Pour cette étude transversale, Dr Tsui et ses collègues ont prélevé des échantillons des yeux et du nez de 52 patients atteints de conjonctivite infectieuse aiguë à Hawaï, en Californie et en Israël entre mars 2021 et mars 2023. L’âge moyen était de 48 ans et 60 % étaient des femmes. Les patients atteints de conjonctivite allergique ou toxique ont été exclus.
En utilisant le séquençage profond de l’ARN pour examiner les échantillons, l’équipe a trouvé des adénovirus humains de l’espèce D chez 13 patients de Californie, et deux cas d’adénovirus humains de l’espèce B en Israël. Deux cas de virus d’Epstein-Barr, trois cas d’herpès simplex de type 1, deux cas de virus varicelle-zona, un cas de métapneumovirus humain, un cas de SRAS-CoV-2, trois cas de coronavirus humain 229E, un cas de molluscum contagiosum, quatre cas de bactéries et deux cas de champignons ont été recensés. Aucun agent pathogène n’a été trouvé dans 18 cas.
Les chercheurs ont relevé les limites de leur étude, notamment sa petite taille, le faible nombre de sites participants et l’absence de « détection microbienne traditionnelle par réaction en chaîne de la polymérase ou culture, bien que les tests diagnostiques, quel que soit leur type, soient rarement effectués dans le cadre ambulatoire pour une conjonctivite infectieuse aiguë présumée ».
Ils ont également indiqué qu’aucune information sur les coûts n’avait été recueillie et qu’il n’y avait donc aucun moyen de savoir si ce type de test était rentable.
Source : https://www.medpagetoday.com/ophthalmology/ generalophthalmology/107137

Selon Bausch + Lomb, MIEBO (solution ophtalmique de perfluorohexyloctane) est le premier collyre de prescription qui cible l’évaporation des larmes.
Bausch + Lomb Corp. a annoncé le lancement commercial aux États-Unis de la solution ophtalmique de perfluorohexyloctane (Miebo) pour le traitement des signes et symptômes de la sécheresse oculaire.
Selon la société, la solution ophtalmique de perfluorohexyloctane est le premier et seul collyre de prescription approuvé pour la sécheresse oculaire qui cible directement l’évaporation des larmes.
Dans un communiqué de presse, Andrew Stewart, président de Global Pharmaceuticals and International Consumer, Bausch + Lomb, souligne que de plus en plus d’Américains souffrent de sécheresse oculaire, en grande partie à cause du mode de vie multiécran d’aujourd’hui.
« Avec MIEBO, les professionnels des soins oculaires disposent désormais d’un collyre de prescription qui s’attaque directement à l’évaporation des larmes, principale cause de la sécheresse oculaire », a-t-il déclaré dans le communiqué de presse.
Selon Bausch + Lomb, plus de 38 millions d’Américains sont touchés par la sécheresse oculaire, et neuf sur dix souffrent de sécheresse oculaire par évaporation1, 2. Lorsqu’elle n’est pas traitée, l’évaporation lacrymale peut entraîner une aggravation de la maladie en déclenchant un cycle d’inflammation et de dommages à la surface oculaire3, 4
Dans son communiqué de presse, la société indique que la solution ophtalmique de perfluorohexyloctane est un collyre de prescription à ingrédient unique, sans eau, sans conservateur et sans stéroïde, qui s’étale rapidement et confortablement. Il est conçu pour traiter les signes et les symptômes de la dermatite atopique en réduisant l’évaporation des larmes à la surface oculaire5-7
Les sociétés ont noté que l’approbation de la FDA était étayée par les données positives des essais cliniques pivots de phase 3 GOBI (NCT04139798) et MOJAVE (NCT04567329), qui ont inclus 1 217 patients chez qui on avait diagnostiqué un syndrome de l’œil sec ainsi que des signes cliniques de dysfonctionnement des glandes de Meibomius (MGD), et qui ont constamment satisfait aux critères d’évaluation des signes cliniques primaires et des symptômes rapportés par les patients dans le cadre des essais.
Dans les essais cliniques, MIEBO a apporté des améliorations significatives aux signes et symptômes de la dermatite atopique et a constamment atteint son principal critère d’évaluation des signes cliniques et des symptômes rapportés par les patients. L’effet indésirable le plus fréquent de MIEBO a été une vision floue (1 à 3 % des patients ont signalé une vision floue et une rougeur des yeux).
Le traitement de l’évaporation en tant que source sousjacente des signes et symptômes de la dermatite atopique pourrait contribuer à rompre le cycle de la maladie chronique et à rétablir l’homéostasie de la surface oculaire.
La solution ophtalmique de perfluorohexyloctane est conçue pour imiter une fonction clé du meibum naturel en réduisant l’évaporation des larmes. Les glandes de Meibomius produisent du meibum, une sécrétion riche en lipides qui forme la couche lipidique du film lacrymal et contribue à maintenir une surface oculaire saine.
Données cliniques
Dans les études GOBI et MOJAVE, les 2 critères d’évaluation principaux étaient le changement par rapport à la ligne de base à la semaine 8 (jour 57 ± 2) de la coloration cornéenne totale à la fluorescéine (tCFS) et du score de sécheresse oculaire sur l’échelle visuelle analogique (VAS). Les patients ont ressenti un soulagement des symptômes dès le 15e jour et jusqu’au 57e jour, avec une réduction significative du score de sécheresse oculaire sur l’échelle VAS en faveur de la solution ophtalmique de perfluorohexyloctane observée dans les deux études. De plus, aux jours 15 et 57, une réduction significative du tCFS en faveur de la solution ophtalmique au perfluorohexyloctane a été observée dans les deux études.
Les effets indésirables les plus fréquents observés avec le collyre au perfluorohexyloctane ont été une vision trouble (1,3 % à 3 %) et une rougeur oculaire (1,3 % à 3 %).
1. Downs P. 2020 Dry eye products market report: a global analysis for 2019 to 2025. Market Scope; 2020.
2. Lemp, MA, Crews, LA, Bron AJ. (2012). Distribution of aqueous-deficient and evaporative dry eye in a clinicbased cohort: a retrospective study. Cornea. 31(5), 472478. 2012;31(5):472-478. doi:10.109/ICO.0b013e318225415a.
3. Craig JP, Nelson JD, Azar DT, et al. TFOS dews II report executive summary. Ocul Surf. 2017;15(4):802-812. doi:10.1016/j.tos.2017.08.003.
4. Baudouin C, Messmer EM, Aragona P, et al. Revisiting the vicious circle of dry eye disease: a focus on the pathophysiology of meibomian gland dysfunction. Br J Ophthalmol. 2016;300-203. doi:10.1136/ bjophthalmol-2015-307415.
5. Data on file.
6. Nichols KK, Foulks GN, Bron AJ, et al. The international workshop on Meibomian gland dysfunction: executive summary. Invest Ophthalmol Vis Sci. 2011;52(4):1922-1929. doi:10.1167/iovs.10-6997a
7. Borchman D, Vittitow J, Ewurum A, Veligandl SR. Spectroscopic study of perfluorohexyloctane human Meibum interactions. Invest Ophthalmol Vis Sci. 2022;63:1525.

Association entre la consommation alimentaire de vitamine B1 et la dégénérescence maculaire avancée liée à l’âge : une étude d’observation transversale dans NHANES 2005-2008
Introduction : La dégénérescence maculaire liée à l’âge (DMLA) est l’une des affections les plus courantes à l’origine de la cécité permanente dans le monde. L’objectif de la présente étude était de déterminer l’association entre la consommation de vitamine B1 et la prévalence de la DMLA tardive dans un échantillon représentatif des États-Unis.
Méthodes : Les données de la National Health and Nutrition Examination Survey (NHANES) entre 2005 et 2008 ont été utilisées pour cette analyse transversale. Le modèle de régression logistique a été utilisé pour évaluer l’association entre les niveaux de consommation de vitamine B1 et la DMLA tardive.
Résultats : Notre étude a porté sur 5 107 personnes âgées de 40 ans et plus. Les niveaux de consommation de vitamine B1 étaient inversement associés à la prévalence de la DMLA tardive, avec des OR de 0,40 (IC 95 % : 0,26-0,62), 0,53 (IC 95 % : 0,29-0,94), 0,55 (IC 95 % : 0,31-0,99) pour le modèle brut 1, le modèle ajusté 2, et le modèle entièrement ajusté 3, respectivement.
Conclusion : Notre étude a montré que les niveaux d’apport en vitamine B1 étaient inversement associés à la prévalence de la DMLA tardive aux États-Unis. D’autres essais cliniques randomisés entre plusieurs centres sont encore justifiés pour étudier la relation longitudinale et causale entre l’apport en vitamine B1 et la DMLA tardive.
Source : Zheng Q, Shen T, Xu M, Tan L, Shen Z, Hong C. Association between Dietary Consumption of Vitamin B1 and Advanced Age-Related Macular Degeneration: A Cross-Sectional Observational Study in NHANES 20052008. Ophthalmic Res. 2023;66(1):1353-1361. doi: 10.1159/000534819. Epub 2023 Nov 3. PMID: 37926095.
https://pubmed.ncbi.nlm.nih.gov/37926095/

Association entre les cellules immunitaires de l’intestin et les lésions oculaires dues au glaucome
Une équipe de scientifiques médicaux de l’Université des sciences et technologies électroniques de Chine, en collaboration avec un collègue de l’Université médicale de l’armée et un autre de l’Hôpital de santé maternelle et infantile de Luzhou, a découvert un lien entre les cellules immunitaires de l’intestin et les lésions de la rétine causées par le glaucome. Dans leur étude, publiée dans la revue Science Translational Medicine, le groupe a analysé le comportement des cellules T CD4+ et de la protéine intégrine β7.
Des recherches antérieures ont suggéré que les cellules T sont probablement impliquées dans les dommages causés par le glaucome, mais jusqu’à présent, la cause est restée un mystère. Dans cette nouvelle étude, l’équipe de recherche a soupçonné que les cellules T CD4+ pouvaient jouer un rôle dans la maladie.
Ils ont commencé par analyser des échantillons de sang de 519 patients atteints de glaucome et ont constaté que ceux qui avaient des niveaux plus élevés de cellules T CD4+ présentaient des lésions oculaires plus importantes.
Chez la souris, les cellules T CD4+ expriment l’intégrine β7 dans l’intestin, une protéine codée par le gène ITGB7. Les chercheurs ont également constaté que les cellules T CD4+ étaient reprogrammées dans l’intestin d’une manière qui leur permettait d’utiliser l’intégrine β7 pour accéder à la rétine et attaquer les cellules ganglionnaires de la rétine lorsqu’elles étaient transportées par le sang.
Pour en savoir plus sur l’association entre les cellules T CD4+ et les lésions du glaucome, l’équipe a administré à des souris de test des anticorps qui empêchaient les cellules d’interagir avec une protéine connue sous le nom de MAdCAM-1, ce qui a entraîné une réduction de l’inflammation dans l’œil et des lésions de la rétine.
L’équipe conclut qu’en plus d’établir un lien entre les cellules immunitaires de l’intestin et les lésions du glaucome, leur étude met également en évidence le rôle que le système immunitaire peut jouer dans des maladies telles que le glaucome.
Information : Chong He et al, Gut-licensed β7 + CD4 + T cells contribute to progressive retinal ganglion cell damage in glaucoma, Science Translational Medicine (2023). DOI: 10.1126/scitranslmed.adg1656
Source : https://medicalxpress.com/news/2023-08-association-gut-immune-cellseye.html#:~:text=A%20team%20of%20medical%20scientists,the%20 retina%20due%20to%20glaucoma

Azalea Vision annonce le premier test oculaire de son prototype de lentille de contact intelligente
La lentille de contact intelligente est conçue pour offrir une solution non invasive aux patients souffrant de kératocône, d’irrégularités de la cornée, de photophobie et de presbytie.
Azalea Vision a annoncé la démonstration de sa lentille ALMA, le premier prototype fonctionnel de la plateforme de lentilles de contact intelligentes Azalea. Selon Azalea Vision, cette lentille est conçue pour offrir une solution non chirurgicale aux patients souffrant de kératocône, d’irrégularités de la cornée, de photophobie et de presbytie1
« Ce test marque un tournant dans la recherche d’options de traitement non invasives pour des conditions oculovisuelles difficiles », a déclaré Andrés Vásquez Quintero, cofondateur et directeur technique d’Azalea Vision, qui a également porté le dispositif.
La société a également indiqué dans son communiqué que la lentille comprend un diaphragme intégré, dont l’ouverture peut être modulée pour filtrer la quantité de lumière qui pénètre dans l’œil. La conception intègre une technologie à cristaux liquides, une micropuce, une antenne RF, une microbatterie de qualité médicale et un contrôle configurable de la lumière1
En outre, la société explique que cette lentille intelligente est conçue pour être facile à utiliser et à programmer, par les patients et les médecins, ce qui permet une thérapie personnalisée.
Azalea a indiqué dans son communiqué que sa première application visera à aider les patients souffrant d’astigmatisme irrégulier dû au kératocône et à d’autres irrégularités de la cornée. En filtrant la lumière périphérique, la lentille intelligente est conçue pour permettre à la lumière focalisée d’atteindre la rétine.
Cette première application pourrait permettre de traiter près d’un demi-million de patients rien que dans l’Union européenne et aux États-Unis, ce qui représente un marché total de plus de 2 milliards d’euros par an, puisqu’il s’agit d’un marché renouvelable. Ni les lunettes ni les lentilles de contact actuellement disponibles sur le marché ne peuvent résoudre complètement les graves distorsions visuelles auxquelles la lentille ALMA d’Azalea Vision est destinée1
Rudy Nuijts, MMA, professeur de médecine et d’ophtalmologie à la Clinique ophtalmologique universitaire de Maastrich, s’est réjoui de ces résultats.
« Dans notre hôpital, nous traitons de nombreux patients atteints d’astigmatisme irrégulier grave. Les patients souffrant d’irrégularités de la cornée pourraient bénéficier d’une solution non chirurgicale conçue pour filtrer la lumière aberrante afin de récupérer leur acuité et leur qualité visuelles », a-t-il déclaré dans le communiqué de presse.
La lentille pourrait également être utile aux patients atteints de presbytie, car son principe d’optique à petite ouverture pourrait augmenter la profondeur de champ des patients et corriger les erreurs de réfraction. La technologie pourrait également aider les patients souffrant de troubles de l’iris, d’une sensibilité sévère à la lumière due à une migraine chronique ou du syndrome de l’œil sec, car elle est conçue pour diminuer la quantité de lumière atteignant leurs yeux.
Enrique Vega, PDG d’Azalea Vision, a déclaré que le succès du prototype de l’entreprise mettait en évidence l’esprit d’innovation de son équipe.
« Nous ne nous contentons pas de développer une nouvelle catégorie de produits dans le secteur des dispositifs médicaux; nous sommes les pionniers d’une plateforme aux applications diverses et révolutionnaires », conclut-il dans le communiqué de presse.
Basée en Belgique et fondée en juillet 2021, Azalea Vision est une entreprise dérivée d’imec et de l’Université de Gand et a reçu le soutien de VLAIO, ainsi que d’investisseurs MedTech et DeepTech, dont imec.xpand, Elaia Partners, Sensinnovat et Shigeru.
Leur lentille de contact intelligente est un système polyvalent conçu pour répondre à de multiples défis visuels tels que le kératocône, la presbytie et la sensibilité à la lumière. Au cœur de la lentille se trouve un diaphragme intégré, qui agit comme un filtre de lumière.
S’appuyant sur une technologie exclusive, leur lentille offre une personnalisation et une adaptabilité inégalées. Notre lentille révolutionnaire s’adapte dynamiquement aux défis visuels individuels, établissant une nouvelle norme en matière de soins optiques pour les patients.

1. Azalea Vision announces first on-eye test of Alma, its revolutionary smart contact lens. Azalea Vision. Published December 5, 2023. Accessed December 5, 2023. https://azaleavision.com/alma-lens-the-revolutionarysmart-contactlens-by-azalea-vision-promises-new-hopeforpatients-with-vision-disorders

Les inhibiteurs du canal calcique à nouveau liés
Mais un chercheur affirme qu’il n’est pas nécessaire de faire passer la plupart des utilisateurs à d’autres médicaments antihypertenseurs.
Selon une étude transversale basée sur la population, les patients prenant des inhibiteurs calciques (CCB) sont plus susceptibles de souffrir de glaucome que leurs homologues.
L’examen des données de plus de 400 000 participants à la Biobank du Royaume-Uni a révélé que l’utilisation d’inhibiteurs calciques était associée à une probabilité de glaucome supérieure de 39 % après ajustement de divers facteurs, y compris l’utilisation d’autres antihypertenseurs (OR 1,39, IC à 95 % 1,14-1,69, P = 0,001), ont rapporté Alan Kastner, MD, MSc, de la Clínica Oftalmológica Pasteur à Santiago, Chili, et ses collègues dans le JAMA Ophthalmology
Cette association n’a pas été observée avec les diurétiques, les inhibiteurs du SRA ou les bêtabloquants, et les chercheurs ont également trouvé des preuves que les CCB peuvent augmenter le risque de glaucome en amincissant les couches de la rétine.
Le risque n’est pas suffisamment grave pour que les patients qui ne souffrent pas déjà de glaucome ou dont la maladie est stable cessent de prendre des CCB, a déclaré Anthony Khawaja, MBBS, Ph. D., de l’University College London, coauteur de l’étude. Mais il vaut la peine d’envisager d’autres médicaments chez les patients qui prennent ces médicaments et qui souffrent d’une aggravation de leur glaucome, a-t-il ajouté.
« Pour ces patients, nous devons penser à d’autres facteurs que la pression oculaire, car leur état s’aggrave malgré tout ce que nous pouvons faire pour la pression oculaire, a-t-il déclaré. Si ces patients sont sous CCB, je discute des preuves imparfaites dont nous disposons avec le patient et son médecin traitant afin d’envisager un changement d’antihypertenseur. »
Des recherches antérieures ont établi un lien entre les CCB et le glaucome, a déclaré Khawaja, mais les auteurs de la nouvelle étude ont cherché à examiner un ensemble de données plus large. « Nous voulions non seulement examiner l’association entre les CCB et le glaucome dans la population générale, mais aussi la relation avec les paramètres physiques qui sont importants dans le glaucome, la pression intraoculaire (PIO) et l’épaisseur de la rétine interne ».
Kastner et ses collègues se sont concentrés sur 427 480 participants à la Biobanque britannique (recrutés entre 2006 et 2010) qui avaient subi des examens oculaires (âge moyen de 58 ans, 54,1 % de femmes, 94,8 % de Blancs). Dans l’ensemble, 26,7 % des participants souffraient d’hypertension et 7,8 % prenaient des inhibiteurs de la cholestérolémie (n = 33 175).
Le glaucome était rare, que les patients prennent ou non des CCB (0,4 % vs 0,2 %, respectivement).
Parmi les 41 023 sujets disposant de données appropriées sur l’épaisseur de la couche rétinienne interne dérivée de la tomographie par cohérence optique (OCT), les utilisateurs de CCB avaient une rétine interne significativement plus fine que les non-utilisateurs (-0,16 μm, IC à 95 % -0,30 à -0,02 μm, P = 0,03), « un paramètre important qui aide au diagnostic du glaucome », a déclaré le Dr Khawaja.
Les couches plexiformes internes des cellules ganglionnaires maculaires étaient également plus minces chez les utilisateurs de CCB (-0,34 μm, IC à 95 % -0,54 à -0,15 μm, P = 0,001).
« Il est intéressant de noter que les utilisateurs de CCB n’avaient pas une pression oculaire significativement différente de celle des non-utilisateurs », a déclaré Dr Khawaja. « Cela suggère que si les CCB ont un impact sur le glaucome, ce n’est pas via une augmentation de la pression intraoculaire et peut être via des effets plus directs sur le nerf optique ».
Dans un commentaire invité, Paula Anne Newman-Casey, MD, MS et Rithambara Ramachandran, MD, de l’Université du Michigan à Ann Arbor, ont déclaré que les auteurs de l’étude ont « analysé avec élégance » la relation entre les CCB et le glaucome. « La moitié de la population adulte des États-Unis souffre d’hypertension, de sorte que la question de l’impact des médicaments antihypertenseurs sur le glaucome et la pression oculaire est très pertinente pour les ophtalmologistes américains », écrivent-ils.
Les auteurs du commentaire ajoutent que « l’utilisation des inhibiteurs calciques en tant que traitement potentiel du glaucome à tension normale a fait l’objet d’une controverse et que des données contradictoires ont été recueillies concernant l’utilisation des inhibiteurs calciques et leur impact sur la PIO et le glaucome à angle ouvert ».
La façon dont les CCB peuvent augmenter le risque de glaucome n’est pas claire, a déclaré Dr Khawaja.
« Nous n’avons pas prouvé le lien de cause à effet. S’il y a un véritable effet, nous pensons qu’il sera dû à des effets directs sur le nerf optique plutôt qu’à des changements de la pression oculaire, a-t-il déclaré. Nous savons que les canaux calciques sont très importants pour la fonction du nerf optique, ainsi que pour la fonction des cellules entourant la tête du nerf optique, qui offrent un soutien. Mais d’autres recherches en sciences fondamentales sont nécessaires pour explorer les voies de causalité possibles. »
Qu’en est-il des autres médicaments contre la tension artérielle ? « Jusqu’à présent, nous n’avons pas trouvé de preuves cohérentes que d’autres antihypertenseurs affectent individuellement le risque », a déclaré Khawaja. « Les bêtabloquants oraux abaissent certainement la pression oculaire et peuvent réduire le risque. Certains éléments indiquent qu’une pression artérielle trop basse peut être nocive, mais la relation de cause à effet reste incertaine ».
Dans leur étude, l’équipe de recherche n’a trouvé aucune association entre le glaucome et l’utilisation d’autres agents antihypertenseurs :
Diurétiques : OU 1,03 (IC 95 % 0,84-1,28)
Inhibiteurs du SRA : OU 1,12 (IC 95 % 0,93-1,34)
Bêtabloquants systémiques : OU 0,93 (IC 95 % 0,74-1,18)
Kastner et ses coauteurs ont noté plusieurs limitations, telles que l’absence de sujets non blancs et le manque d’informations sur la durée et les doses de CCB.
Source : https://www.medpagetoday.com/ophthalmology/glaucoma/106220
Aussi : Vergroesen JE, Schuster AK, Stuart KV, Asefa NG, Cougnard-Grégoire
A, Delcourt C, Schweitzer C, Barreto P, Coimbra R, Foster PJ, Luben RN, Pfeiffer N, Stingl JV, Kirsten T, Rauscher FG, Wirkner K, Jansonius NM, Arnould L, Creuzot-Garcher CP, Stricker BH, Keskini C, Topouzis F, Bertelsen G, Eggen AE, Bikbov MM, Jonas JB, Klaver CCW, Ramdas WD, Khawaja AP; European Eye Epidemiology Consortium. Association of Systemic Medication Use with Glaucoma and Intraocular Pressure: The European Eye Epidemiology Consortium. Ophthalmology. 2023 Sep;130(9):893-906. doi: 10.1016/j.ophtha.2023.05.001. Epub 2023 May 6. PMID: 37150298.

Les défauts de l’épithélium cornéen guérissent mieux avec l’insuline topique qu’avec les larmes artificielles chez les diabétiques
Pour les patients diabétiques qui développent des défauts de l’épithélium cornéen après une chirurgie vitréorétinienne, l’insuline topique est le traitement le plus efficace.
L’insuline topique est plus efficace que les larmes artificielles pour guérir les défauts de l’épithélium cornéen induits par la chirurgie vitréorétinienne chez les patients diabétiques, selon une nouvelle étude de Cornea
Le diabète et la nécessité pour les patients diabétiques de subir une vitrectomie sont en augmentation. Des études antérieures ont montré que l’insuline et le hyaluronate de sodium sont tous deux utiles pour le traitement, mais leurs taux de guérison n’ont pas été comparés.
Dans le cadre de cette étude, les chercheurs ont examiné 38 patients atteints de diabète sucré et de défauts épithéliaux postopératoires de la cornée qui avaient subi un débridement épithélial. Ils ont assigné au hasard les patients à recevoir soit de l’insuline topique 0,5 unité (25 UI/mL Actrapid), soit des larmes artificielles (hyaluronate de sodium 0,18 %) 4 fois par jour.
Les chirurgiens vitréorétiniens peuvent se sentir plus à l’aise pour effectuer un débridement afin d’obtenir une meilleure vue du fond de l’œil pendant la vitrectomie, si nécessaire, car il existe une thérapie sûre et efficace pour accélérer la guérison des défauts épithéliaux de la cornée après l’opération.
Près de 3 patients sur 5 étaient d’origine malaise. Les patients (âge moyen, 58 ans) souffraient de diabète depuis 10 ans en moyenne. Ils prenaient généralement des hypoglycémiants oraux, une combinaison d’hypoglycémiants oraux et d’insuline, ou de l’insuline seule.
Le groupe insuline topique a connu une cicatrisation plus rapide des défauts épithéliaux de la cornée (1,20 ± 0,29 mm2/h [h] vs 0,78 ± 0,20 mm2/h), comme le montrent les taux à 36 heures, 48 heures et 144 heures (P = 0,01 = 0,009, = 0,009, respectivement).
Les patients ayant reçu de l’insuline topique ont connu une cicatrisation complète des défauts épithéliaux à 72 heures, tandis que les membres du groupe DAT ont cicatrisé à 144 heures. Deux patients du groupe DAT ont dû porter des lentilles de contact après cette période. Les membres du groupe insuline topique ont toujours été en tête pour ce qui est de la cicatrisation des défauts épithéliaux, mais la différence 6 jours après l’intervention n’était pas statistiquement significative. La différence était la plus importante après 36 heures (23,6 %). Les patients ayant des niveaux variables d’HbA1c préopératoire n’ont pas développé de différences entre 2 heures après l’opération et le 6e jour. Aucun patient n’a signalé d’effets indésirables.
« Les chirurgiens vitréorétiniens peuvent se sentir plus à l’aise pour effectuer un débridement afin d’obtenir une meilleure vue du fond de l’œil pendant la vitrectomie si nécessaire, car il existe une thérapie sûre et efficace pour accélérer la cicatrisation des défauts épithéliaux de la cornée après l’opération », remarquent les auteurs de l’étude. Les patients diabétiques pourraient avoir moins besoin d’une hospitalisation prolongée en raison de défauts épithéliaux; près de 7 patients sur 10 ayant reçu de l’insuline topique ont connu une guérison complète dans les 60 heures suivant l’intervention chirurgicale.
Les limites de l’étude sont la petite taille de l’échantillon et l’impossibilité d’établir si la solution saline normale utilisée pour l’insuline accélère la cicatrisation.
Dasrilsyah AM, Halim WHWA, Mustapha M, et al. Randomized clinical trial of topical insulin versus artificial tears for healing rates of iatrogenic corneal epithelial defects induced during vitreoretinal surgery in diabetics. Cornea. 2023;42(11):1395-1403. doi:10.1097/ ICO.0000000000003308

La kératectomie personnalisée montre une efficacité à long terme dans le traitement de la dystrophie cornéenne
granulaire
Une technique de PTK personnalisée a montré une efficacité à long terme dans le traitement de la dystrophie cornéenne granulaire de type 1.
Il s’agit d’une alternative sûre, efficace et peu invasive à la transplantation de cornée.
La kératectomie thérapeutique séquentielle personnalisée s’est avérée efficace dans le traitement de la dystrophie cornéenne granulaire de type 1, conduisant à une amélioration de la vision à long terme et à une réduction de l’astigmatisme et des aberrations d’ordre supérieur, selon une étude.
« La SCTK est une technique peu invasive, sûre et efficace qui permet d’éviter ou de retarder la greffe de cornée, tout en améliorant la vision et les aberrations cornéennes », a déclaré à Healio l’auteur de l’étude, le docteur Paolo Vinciguerra. « La récurrence de la dystrophie est bien connue avec la greffe de cornée, c’est pourquoi il est préférable de la retarder ou de l’éviter.
La dystrophie cornéenne granulaire de type 1 (DCG1) est une maladie génétique progressive qui se développe dès le plus jeune âge et entraîne une érosion de la cornée, des douleurs et une baisse de la vision. La transplantation de cornée était le traitement traditionnel, mais plus récemment, la kératectomie photothérapeutique (PTK) a été utilisée.
« Nous avons développé la kératectomie photothérapeutique avec une approche transépithéliale, personnalisée et en plusieurs étapes, et nous avons défini cette technique comme la kératectomie thérapeutique personnalisée séquentielle (SCTK) », écrivent les auteurs.
Trente-sept yeux de 21 patients atteints de GCD1 ont été traités entre février 2002 et juillet 2017. Dans six yeux de cinq patients, le traitement a été réalisé sur une greffe de cornée en cas de récidive de la maladie.
L’acuité visuelle moyenne corrigée à distance s’est améliorée de 0,60 logMAR à 0,25 logMAR (P < 0,001). La différence était encore significative dans les 14 yeux qui ont eu un suivi de 5 ans (P = 0,048). Un gain de deux lignes ou plus a été obtenu dans 71,4 % des yeux, tandis que 5,7 % ont perdu deux lignes ou plus. Une diminution significative de l’astigmatisme et des aberrations cornéennes d’ordre supérieur ainsi qu’une augmentation significative de l’aberration sphérique ont été observées. Une récidive de la maladie a été observée dans un seul œil 8 ans après la SCTK. Aucun œil n’a nécessité de greffe de cornée.
La GCD1 a tendance à réapparaître à plusieurs reprises, y compris après une greffe de cornée. Par conséquent, un traitement peu invasif tel que la SCTK, qui peut être répété en toute sécurité sans causer d’ectasie, est avantageux, ont déclaré les auteurs.
Source : https://www.healio.com/news/ophthalmology/20230712/customizedkeratectomy-shows-longterm-efficacy-in-treatment-of-granular-cornealdystrophy#:~:text=Sequential%20custom%20therapeutic%20keratectomy%20proved,aberrations%2C%20according%20to%20a%20study.

Solution ophtalmique de cyclosporine 0,09 % : les données de phase 4 indiquent une amélioration durable des signes et symptômes de sécheresse oculaire chez les patients qui sont passés de l’émulsion ophtalmique de cyclosporine 0,05 % à l’émulsion ophtalmique de cyclosporine 0,09 %.
Selon Sun Pharmaceutical Industries, la conception de l’étude reflète l’expérience réelle de la sécheresse oculaire, y compris l’utilisation de larmes artificielles et la mesure de la coloration cornéenne à la fluorescéine (CFS) dans les 5 zones de la cornée.
Sun Pharmaceutical Industries Limited a annoncé que les données de phase 4 indiquent que la solution ophtalmique de cyclosporine 0,09 % (CEQUA; Sun Pharmaceutical) induit une amélioration durable des signes et des symptômes de la sécheresse oculaire (DED).
Selon la société, la solution ophtalmique de cyclosporine est un immunosuppresseur inhibiteur de la calcineurine indiqué pour augmenter la production de larmes chez les patients atteints de kératoconjonctivite sicca (sécheresse oculaire). Dans son communiqué de presse, la société indique que les chercheurs ont constaté que la solution ophtalmique de cyclosporine entraînait une amélioration significative de la coloration cornéenne à la fluorescéine (CFS, un test utilisé pour détecter les lésions de la cornée) et des scores de l’évaluation modifiée des symptômes de la sécheresse oculaire (mSANDE) chez les patients atteints de sécheresse oculaire dont la maladie n’était pas contrôlée par le traitement à l’émulsion ophtalmique de cyclosporine (Restasis; Allergan, une société d’AbbVie) à 0,05 %1
Les chercheurs ont mené une étude multicentrique de phase 4 de 12 semaines au cours de laquelle les patients ont reçu la solution ophtalmique de cyclosporine deux fois par jour. Ils ont constaté que la solution a permis d’améliorer les scores du SFC et du mSANDE dès la quatrième semaine de traitement et de maintenir ces améliorations jusqu’à la douzième semaine. La solution ophtalmique de cyclosporine offre une concentration élevée de cyclosporine pour une utilisation ophtalmique et est le premier et le seul traitement à base de cyclosporine approuvé par la FDA et délivré avec la technologie NCELL nanomicellaire, qui contribue à améliorer la biodisponibilité de la cyclosporine, ce qui se traduit par une meilleure pénétration dans les tissus oculaires.
Brittany Mitchell, OD, responsable des affaires médicales en ophtalmologie chez Sun Pharma, a fait l’éloge de cette recherche.
« Outre l’amélioration rapide et durable des symptômes chez les patients atteints de sécheresse oculaire et traités par CEQUA, cette étude est remarquable pour sa conception, qui permet l’utilisation de larmes artificielles, reproduisant ainsi les conditions du monde réel aussi fidèlement que possible pour un essai clinique contrôlé, a déclaré Mme Mitchell dans le communiqué de presse. Les données présentées lors de la réunion de l’American Academy of Optometry représentent la première d’une série d’évaluations de cet essai, les résultats étant jusqu’à présent cohérents avec l’efficacité, la sécurité et le dosage pratique de CEQUA. Nous sommes impatients de partager des informations supplémentaires au fur et à mesure que nous continuons à analyser les données de cet essai ».
L’investigateur principal, Josh Johnston, OD, FAAO, de Georgia Eye Partners à Atlanta, en Géorgie, a déclaré que les chercheurs ont été encouragés d’observer des améliorations significatives des signes et symptômes de la sécheresse oculaire dès la quatrième semaine de traitement avec la solution, et de constater des améliorations encore plus importantes à la huitième semaine et à la douzième semaine.
« En évaluant la coloration de la fluorescéine cornéenne dans les cinq zones de la cornée, nous avons pu obtenir une caractérisation plus complète de la santé de la cornée que dans de nombreux essais sur la sécheresse oculaire, qui n’évaluent généralement que quelques zones de la cornée », a déclaré Johnson dans un communiqué de presse.
La société a indiqué que son étude avait recruté des adultes souffrant de sécheresse oculaire insuffisamment contrôlée (c'est-à-dire encore symptomatique et/ou présentant des signes de la maladie) sous traitement par émulsion ophtalmique de cyclosporine depuis au moins 3 mois, et qui avaient des antécédents et un diagnostic clinique de sécheresse oculaire depuis au moins 3 mois avant le dépistage/la ligne de base. Les patients ont reçu une goutte de CEQUA dans chaque œil deux fois par jour pendant 12 semaines. Les investigateurs ont évalué les scores CFS et mSANDE au début de l’étude et aux semaines 4, 8 et 12, et/ou lors de l’arrêt prématuré de l’étude.
En outre, la société a noté que le CFS était noté sur une échelle de 0 à 4 par incréments de 0,5 point, un score de 0 indiquant l’absence de tache (c’est-à-dire une cornée saine) et un score de 4 reflétant une tache sévère; les investigateurs ont calculé un score CFS total en additionnant les cinq scores de la zone cornéenne. Le questionnaire mSANDE a évalué la fréquence et la gravité des symptômes de sécheresse et d’irritation sur une échelle de 0 à 100, 0 représentant une fréquence/sévérité très faible et 100 une fréquence/sévérité très élevée.
Les chercheurs ont présenté les résultats de 124 patients de la population en intention de traiter modifiée (mITT). L’âge moyen des patients était de 65,5 (11,6) ans; 110 d’entre eux (88 %) étaient des femmes. Le score CFS total moyen (SD) était de 5,7 (3,37) au départ et s’est amélioré de manière significative (P < 0,0001) pour atteindre 4,0 (±3,12) à la semaine 4, 2,9 (±2,54) à la semaine 8 et 2,7 (±2,36) à la semaine 12. De même, le score mSANDE moyen (SD) était de 67,1 (±21,05) au départ et s’est amélioré de manière significative (P < 0,0001) à 48,4 (±23,31) à la semaine 4, 44,2 (±24,28) à la semaine 8 et 38,3 (±25,99) à la semaine 12. Les chercheurs ont également indiqué que la solution ophtalmique de cyclosporine 0,09 % était généralement bien tolérée dans l’étude, conformément à son profil de sécurité établi, et qu’il n’y avait pas de nouveaux signaux de sécurité dans l’essai.
Dans l’ensemble, 58 patients (43,3 %) ont signalé au moins un événement indésirable (EI) lié au traitement; la plupart des EI étaient d’intensité légère (73,8 %). Les EI liés au traitement les plus fréquents étaient l’irritation et la douleur au point d’instillation; tous les autres EI liés au traitement sont survenus chez moins de 2 % des patients.
Johnston a présenté ces données lors de la réunion annuelle de l’American Academy of Optometry 2023 qui s’est tenue à la Nouvelle-Orléans, en Louisiane.
1. Johnston, J. Effect of OTX-101 0.09% on corneal staining and SANDE scores in patients with dry eye disease uncontrolled on cyclosporine ophthalmic emulsion 0.05%. Abstract presented at American Academy of Optometry 2023; October 12, 2023; New Orleans, LA.
2. New study focuses on scope of dry eye disease in the U.S. American Optometric Association; 2017. Available at: https://www.aoa.org/news/clinical-eye-care/new-studydry-eye-disease. Accessed September 10, 2019

Effet de la glucosamine sur la pression intraoculaire et le risque de développer un glaucome
Contexte : La glucosamine est le médicament à action lente le plus fréquemment recommandé pour traiter les symptômes de l’arthrose, bien que son efficacité soit discutable. Les suppléments de sulfate de glucosamine largement utilisés peuvent augmenter la pression intraoculaire (PIO).
Méthodes : Dans la présente étude, nous avons analysé les bases de données en ligne UK Biobank, MedWatch et FinnGen afin d’évaluer la relation entre la glucosamine, la PIO et le glaucome. Nous avons inclus le budésonide et la fluticasone dans l’analyse à des fins de comparaison, car ces médicaments sont associés à une augmentation de la PIO.
Résultats : Chez les sujets de la UK Biobank, l’utilisation de la glucosamine a été associée à une augmentation de la PIO compensée par la cornée (P = 0,002, test t bilatéral). Cela était également vrai chez les sujets sans glaucome (P = 0,002, test t bilatéral). Cependant, aucune association significative entre la glucosamine et la PIO n’a été détectée chez les sujets ayant reçu un diagnostic de glaucome. Dans MedWatch, 0,21 % des sujets prenant de la glucosamine ont signalé un glaucome, 0,29 % des sujets utilisant du budésonide ont signalé un glaucome et 0,22 % des sujets utilisant de la fluticasone ont signalé un glaucome. En revanche, 0,08 % des sujets utilisant un autre médicament ont déclaré un glaucome. Cette variabilité est significative (P < 0,001, test exact de Fisher bilatéral). Les données de FinnGen sur le risque de glaucome primaire à angle ouvert (POAG) ou de glaucome chez les sujets utilisant de la glucosamine avant le diagnostic de la maladie ont révélé un risque significativement accru à la fois pour le POAG (rapport de risque 2,35) et pour le glaucome (rapport de risque 1,95).
Conclusion : La supplémentation en glucosamine est courante mais peut être associée à une augmentation de la PIO et pourrait contribuer à la pathogenèse du glaucome. Il peut être prudent pour les praticiens de demander à leurs patients s’ils ont des antécédents de consommation de glucosamine et de les conseiller en conséquence. D’autres études sur le rôle de la glucosamine dans le glaucome sont justifiées.
Source : Lehrer S, Morello T, Karrasch C, Rheinstein PH, Danias J. Effect of Glucosamine on Intraocular Pressure and Risk of Developing Glaucoma. J Glaucoma. 2023 Nov 24. doi: 10.1097/IJG.0000000000002340. Epub ahead of print. PMID: 38031296. https://pubmed.ncbi.nlm.nih.gov/38031296/

La FDA approuve l’essai LYNX-2 de la phentolamine en solution ophtalmique pour le traitement de la mauvaise vision nocturne Ocuphire Pharma a reçu l’accord de la FDA dans le cadre d’une évaluation spéciale du protocole pour son essai de phase 3 LYNX-2, une étude de la solution ophtalmique de phentolamine pour le traitement de l’acuité visuelle réduite dans des conditions de faible luminosité.
Selon un communiqué de presse de la société, la FDA a reconnu que le protocole de l’essai clinique et l’analyse statistique prévue pouvaient répondre de manière adéquate aux objectifs soutenant la soumission réglementaire et la future demande de mise sur le marché.
« L’accord SPA avec la FDA offre une voie réglementaire claire pour la solution ophtalmique de phentolamine chez les patients souffrant d’une mauvaise vision nocturne après une chirurgie kérato-réfractive », a déclaré le PDG d’Ocuphire, George Magrath, MD, MBA, MS, dans le communiqué. « Les préparatifs de l’essai de phase 3 LYNX-2 ont commencé et nous prévoyons que le recrutement des patients débutera au premier trimestre 2024. »
L’essai multicentrique, randomisé, en double aveugle, contrôlé par placebo, étudiera la sécurité et l’efficacité de la solution ophtalmique de phentolamine chez un maximum de 200 patients aux États-Unis. Le principal critère d’évaluation est un gain d’au moins trois lignes, ou 15 lettres, d’amélioration de la vision de loin sur une carte à faible contraste dans des conditions de faible luminosité, après 15 jours de traitement.
« Actuellement, il n’existe aucune thérapie pharmacologique approuvée par la FDA pour traiter cette condition qui est régulièrement présentée dans nos cliniques », a déclaré Marguerite McDonald, MD, FACS, professeure clinique d’ophtalmologie au NYU’s Langone Medical Center et au Tulane University Health Sciences Center, dans le communiqué de presse. « La phentolamine en solution ophtalmique se distingue des autres antibiotiques de sa catégorie par le fait qu’elle ne réduit pas la pupille, ce qui peut diminuer le contraste et dégrader la vision ».

%
La solution ophtalmique de phentolamine 0,75 % est une solution ophtalmique sans conservateur contenant 0,75 % de phentolamine (ou 1 % de mésylate de phentolamine), un antagoniste alpha-adrénergique non sélectif qui inhibe la contraction des muscles lisses de l’iris.
Le mésylate de phentolamine est également le principe actif de deux médicaments approuvés par la FDA, REGITINE® et OraVerse®. La solution ophtalmique de phentolamine 0,75 %® est en cours de développement dans le cadre de la procédure 505 (b) (2). Dans plusieurs essais de phase 2 et de phase 3, le collyre de phentolamine 0,75 % a réduit le diamètre de la pupille, ce qui a permis d’améliorer la sensibilité aux contrastes et l’acuité visuelle. Le collyre de phentolamine 0,75 % est en cours de développement pour inverser la mydriase (RM), la presbytie et les troubles de la vision nocturne (ou de faible luminosité) induits par la pharmacologie. Chez Ocuphire, nous pensons que les résultats des trois essais de phase 1, des cinq essais de phase 2 et des quatre essais de phase 3 de phentolamine 0,75 %, totalisant plus de 650 patients exposés à la phentolamine 0,75 %, soutiennent son plan de développement actuel.
La solution ophtalmique de phentolamine 0,75 % ne contient ni conservateur ni EDTA. L’administration quotidienne chronique de phentolamine 0,75 % avant le coucher a démontré des effets durables pendant plus de 24 heures sans rougeur significative.
Le collyre de phentolamine 0,75 % est en cours de développement pour l’inversion de la mydriase, de la presbytie et des troubles de la vision nocturne (ou de faible luminosité) induits par la pharmacologie. Chez Ocuphire, nous pensons que les résultats des trois essais de phase 1, des cinq essais de phase 2 et des quatre essais de phase 3 de phentolamine 0,75 %, totalisant plus de 650 patients exposés à la phentolamine soutiennent son plan de développement actuel.

La FDA approuve RYZUMVI (solution ophtalmique de phentolamine) pour le traitement de la mydriase d’origine pharmacologique
Ocuphire Pharma et Viatris ont développé ensemble ce médicament pour inverser la mydriase pharmacologiquement induite par des agents agonistes adrénergiques ou parasympatholytiques.
La Food and Drug Administration (FDA) des États-Unis a approuvé le collyre à la phentolamine 0,75 % (Ryzumvi) pour l’inversion de la mydriase pharmacologiquement induite par des agents agonistes adrénergiques ou parasympatholytiques, ou par une combinaison de ceux-ci, qui a été formulé par Ocuphire Pharma et Viatris1. Anciennement connu sous le nom de Nyxol, le Ryzumvi, fraîchement rebaptisé, est un collyre stable, sans conservateur, qui bloque le récepteur α1 dans le muscle dilatateur de l’iris sans affecter le muscle ciliaire. Le résultat est destiné à inverser la mydriase, la presbytie et les troubles de la vision nocturne induits par la pharmacologie.

Aux États-Unis, on estime à 100 millions le nombre de dilatations oculaires effectuées chaque année pour des examens de routine, le suivi de maladies ou des interventions chirurgicales sur la rétine2. Les effets secondaires de la mydriase pharmacologique comprennent une sensibilité à la lumière (photophobie) et une vision floue pouvant durer jusqu’à 24 heures, ce qui peut rendre difficile la lecture, le travail et la conduite3
L’approbation de Ryzumvi fait suite au dépôt d’une demande d’autorisation de mise sur le marché (NDA) en décembre et à l’acceptation de la NDA par la FDA en février. La NDA a été déposée conformément aux résultats de l’essai clinique MIRA. Lors du dépôt de la NDA, Ocuphire a indiqué que la solution ophtalmique de phentolamine 0,75 % ramène rapidement les yeux dilatés à leur diamètre pupillaire de base dès 60 à 90 minutes après la dilatation4
Rick Rodgers, MBA, PDG par intérim d’Ocuphire, a parlé de l’approbation et du travail entre Ocuphire et Viatris dans un communiqué de presse1
« Nous sommes heureux de recevoir l’approbation de la FDA pour les gouttes ophtalmiques RYZUMVI et nous nous réjouissons de la réussite de l’exécution commerciale de Viatris a déclaré M. Rodgers. Nous sommes reconnaissants envers les nombreux patients et chercheurs qui ont participé à nos essais cliniques, ainsi qu’envers les équipes d’Ocuphire et de Viatris pour leur engagement envers les patients ».
Ocuphire a fait état de données préliminaires positives issues des essais cliniques MIRA — MIRA-1, MIRA-2, MIRA-3 et MIRA-4 — dans la RM, de l’essai de phase 3 LYNX-1 dans la NVD et de l’essai de phase 2 b VEGA-1 pour la solution ophtalmique de phentolamine 0,75 % en tant qu’agent unique et en tant que traitement d’appoint avec une faible dose de pilocarpine à 0,4 % dans la presbytie. Ocuphire a noté que la solution ophtalmique de phentolamine 0,75 % a été étudiée dans un total de 12 essais cliniques (3 Phase 1, 5 Phase 2, 4 Phase 3) sur un total d’environ 1 100 patients (avec plus de 650 patients traités à la phentolamine) et a démontré des données cliniques prometteuses pour l’utilisation dans les multiples indications ophtalmiques mentionnées ci-dessus.
Les essais MIRA-2 et MIRA-3 ont atteint avec succès leur objectif principal et leurs principaux objectifs secondaires, démontrant une supériorité statistiquement significative de la solution ophtalmique de phentolamine 0,75 % par rapport au placebo pour ramener rapidement les yeux dilatés à leur diamètre pupillaire de base au bout de 60 et de 90 minutes. Le collyre de phentolamine 0,75 % a montré un profil de sécurité et de tolérance favorable dans tous les essais. De plus, les résultats positifs de l’essai pédiatrique MIRA-4 soutiennent un élargissement potentiel de l’étiquetage de la solution en RM pour inclure les sujets âgés de 3 ans et plus.
Dans les essais MIRA-2 et MIRA-3, un total de 553 sujets âgés de 12 à 80 ans, ayant subi une mydriase induite par l’instillation de phényléphrine ou de tropicamide ou d’une combinaison de bromhydrate d’hydroxyamphétamine et de tropicamide (Paremyd), ont été randomisés. Deux gouttes (œil étudié) ou une goutte (œil compagnon) de placebo Ryzumvior (véhicule) ont été administrées une heure après l’instillation de l’agent mydriatique.
Effets indésirables
La gêne au point d’instillation (16 %), l’hyperémie conjonctivale (12 %) et la dysgueusie (6 %) ont été les effets indésirables les plus fréquemment rapportés.
1. Ocuphire Pharma and Viatrisannounce FDA approval of RYZUMVI™ (phentolamine ophthalmic solution) 0.75% eye drops for the treatment of pharmacologicallyinducedmydriasis produced by adrenergic agonists (e.g., phenylephrine) or parasympatholytic (e.g., tropicamide) agents. Ocuphire Pharma. Press release. Released September 27, 2023. Accessed September 27, 2023.
2. Wilson FA, Stimpson JP, Wang Y. Inconsistencies exist in national estimates of eye care services utilization in the United States. J Ophthalmol. 2015;2015:435606. doi: 10.1155/2015/435606. Epub 2015 Aug 9. PMID: 26346484; PMCID: PMC4546761
3. PARAMYD® (hydroxyamphetamine hydrobromide/ tropicamide ophthalmic solution) 1%/0.25% US prescribing information. Somerset, NJ.: Akorn, Inc.; 2001.
4. Ocuphire announces FDA acceptance of new drug application and PDUFA date of September 28, 2023 for Nyxol® eye drops for reversal of mydriasis. Press release. Released February 13, 2023. Accessed September 27, 2023. https://www.ocuphire.com/news-media/pressreleases/detail/396/ocuphire-announces-fda-acceptanceof-new-drug-application
Source : https://www.ophthalmologytimes.com/view/fda-approvesryzumvi-phentolamine-ophthalmic-solution-for-the-treatmentof-pharmacologically-induced-mydriasis

Les stabilisateurs mitochondriaux pourraient jouer un rôle dans le traitement de la DMLA sèche
Deux médicaments injectables ayant des propriétés de stabilisation des mitochondries, le risuteganib et l’élamiprétide, sont prometteurs pour inverser la perte de vision dans la dégénérescence maculaire sèche liée à l’âge.
« Les deux médicaments ont montré des caractéristiques OCT de seuil qui prédisent la réponse BCVA au traitement, et c’est là le message important », a déclaré Baruch D. Kuppermann, MD, Ph. D., lors de la réunion FLORetina-ICOOR.
Dans un essai de phase 2a, 48 % des patients ayant reçu des injections intravitréennes de risuteganib (Allegro Ophthalmics) au début de l’étude et à la 16e semaine, avec une analyse à 28 semaines, ont atteint le critère principal d’amélioration de huit lettres, et 20 % ont eu un gain de 15 lettres. Les critères OCT à l’inclusion sont en corrélation avec la réponse de la meilleure acuité visuelle corrigée, y compris l’amélioration de l’intégrité de l’ellipsoïde, l’augmentation de l’épaisseur de la rétine externe et la diminution de l’atrophie géographique.
Une analyse complémentaire de l’IA réalisée séparément par deux centres de lecture, les répondeurs étant définis comme des patients ayant obtenu un gain d’au moins huit lettres, a conclu que plus les photorécepteurs sont préservés, meilleure est la réponse au risuteganib.
« Si vous avez une couche de photorécepteurs d’au moins 30 μm, le taux de réponse augmentera de 40 % », a déclaré M. Kuppermann.
Dans l’étude ReCLAIM-2, 117 patients ayant reçu une injection sous-cutanée quotidienne de 40 mg d’élamiprétide (Stealth Bio Therapeutics) ont été comparés à 59 patients ayant reçu un placebo.
L’analyse du critère d’évaluation primaire n’a pas abouti. Le changement moyen de l’acuité visuelle à faible luminosité et le changement moyen de l’atrophie géographique n’étaient pas significatifs. Cependant, il y a eu une différence significative dans le nombre de patients qui ont gagné deux et trois lignes de vision avec le médicament par rapport au placebo.
« Ce qui est encore plus important, c’est qu’ils ont montré une réduction de l’atténuation de la zone ellipsoïde. Cette réduction était de 43 % de l’atténuation totale de la zone ellipsoïde et de 47 % de l’atténuation partielle de la zone ellipsoïde », a déclaré le Dr Kuppermann.
Il convient de noter que la FDA est disposée à considérer cet aspect comme un critère de substitution dans les essais cliniques.
Ces résultats indiquent que la restauration de la vision fonctionnelle pourrait être possible chez les patients atteints de DMLA sèche présentant une plus grande intégrité anatomique en utilisant des médicaments stabilisant les mitochondries, ce qui suggère qu’un traitement précoce de la DMLA sèche est justifié pour inverser la perte de vision. Ils suggèrent également qu’il est important d’établir des seuils, tels que l’épaisseur minimale de l’épithélium pigmentaire rétinien EZ, afin d’enrichir la population de l’étude avec des répondeurs potentiels au médicament étudié.
« La réduction de l’atténuation de l’EZ pourrait être un critère anatomique de substitution acceptable pour les essais cliniques, ce qui faciliterait la mise au point de nouveaux médicaments pour cette maladie », a déclaré M. Kuppermann.
Source : Kuppermann B. Neuroprotection and neuroenhancement for the treatment of retinal diseases. Presented at: FLORetina-ICOOR; Nov. 30-Dec. 3, 2023; Rome.
https://www.healio.com/news/ophthalmology/20231212/mitochondrialstabilizers-may-play-a-role-in-treatment-of-dry-amd

L’évolution du pouvoir d’achat des ménages depuis la pandémie : de réelles surprises !
L’inflation contribue grandement à l’érosion du pouvoir d’achat des consommateurs. C’est ce que soutient la croyance populaire. Un simple graphique récent de l’inflation permet de comprendre que depuis le début de la pandémie, nos chèques de paie rétrécissent comme peau de chagrin. Mais est-ce vraiment le cas ? Pour mieux comprendre, il serait important d’observer l’évolution des salaires au cours du dernier quinquennat. Nous pourrions être réellement surpris.

Pour mieux saisir l’actuelle période d’inflation, il est important d’ouvrir plus largement le cadre temporel. Le début de la pandémie a été particulièrement difficile pour l’économie canadienne. Ouvre-ferme, ouvre-ferme, les usines et les commerces ne sachant plus sur quel pied danser, la dynamique de prix s’était particulièrement ramollie au pays. En moyenne, sur 2020, l’inflation s’était installée à 0,7 %, ce qui signifie le calme plat, et une période de répit sur le coût de la vie, que l’on oublie souvent.
Récession éclair s’il en est une, le repli pandémique est le plus important depuis la Grande Dépression. Il ne dure cependant officiellement que deux mois, de mars à avril 2020. La reprise s’installe ensuite peu à peu, puis c’est au tour de la pression sur les prix de reprendre.
D’abord, sur les prix de l’énergie (une réalité qui rythme très souvent la reprise économique). L’invasion de l’Ukraine par les Russes en février 2022 repousse l’accalmie qui semblait vouloir s’installer en début d’année. Les prix de l’énergie contribueront positivement à l’inflation jusqu’au début 2023.
Vient ensuite la hausse du prix des biens hors énergie et aliments achetés en magasin. Avec la pandémie, les services, et particulièrement ceux offerts en proximité, ne sont plus disponibles. Restaurants, coiffures, dentisterie, massothérapie, etc. ne sont plus au goût du jour. Notre pouvoir d’achat s’exprime par l’acquisition de biens que nous commandons la plupart du temps en ligne. Une immense pression s’installe alors sur les chaînes d’approvisionnement mondiales, que les éclosions de COVID-19 dans les principaux ports du monde ne feront qu’exacerber.
Amazon se construira un petit pécule qui ne sera pas mis à mal par la mise en ligne du Panier bleu. Plus récemment, le rééquilibrage entre la dépense en biens et celle en services pousse les prix des services à la hausse, alors que la pression sur le prix des biens se tasse depuis le printemps.
Autre phénomène inattendu, les confinements répétés et les couvrefeux feront la vie dure aux petits 3 ½ L’espace de vie devient un enjeu, particulièrement pour les télétravailleurs avertis. Qui l’eût cru ? La demande pour l’immobilier explose en période pandémique. Les prix suivront et les pressions ne seront que décuplées sur le secteur du logement avec le retour en masse des populations immigrantes. Pénurie de main-d’œuvre oblige, l’année 2023 sera d’ailleurs une année record. La population canadienne n’avait pas augmenté à un tel rythme depuis les années 1950.
Pour finir, depuis près de deux ans maintenant, le prix des aliments vendus en épicerie progresse de façon horsnorme. Le gouvernement fédéral aura eu beau mettre au banc les épiciers, cette envolée des prix s’explique plutôt par un mélange d’effets résiduels de la pandémie, de la guerre en Ukraine, du réchauffement climatique et de mauvaises récoltes. Chose certaine, l’accumulation des chocs fait en sorte que l’inflation dépasse systématiquement la fourchette supérieure de la cible de 1 % à 3 % souhaitée par la Banque du Canada, et ce, depuis le printemps 2021. Et le retour vers la cible s’annonce chaotique.
La croyance populaire veut que l’inflation gruge le pouvoir d’achat du salaire. Même si l’argumentaire est vrai dans le court terme, il perd beaucoup de sa superbe lorsque l’on en gratte la surface. On oublie trop facilement que l’inflation est une des variables clés à la base du processus de négociation salariale. Le point de départ de toute négociation qui se respecte. L’inflation ne fait pas que gruger le pouvoir d’achat, elle conditionne aussi les salaires. Graphique 1
Progression des prix et des salaires pourcentage de croissance entre janvier 2019 et octobre 2023 Source: Statistique Canada
Canada Québec
Ainsi, entre janvier 2019 et octobre 2023, la progression des prix s’élève à 18,7 % au Canada et à 20,4 % au Québec. Ce qui représente une hausse du coût de la vie importante si l’on considère qu’avec un taux d’inflation stabilisé autour de la cible souhaitée par la Banque du Canada, la progression de prix n’aurait dû être que de 9,9 %. Cependant, l’augmentation des salaires s’affiche à 21,1 % au Canada et à 22,7 % au Québec sur la même période (graphique 1). C’est plus de 2 points de pourcentage au-dessus de la hausse des prix dans les deux cas. Il apparaît donc que le pouvoir d’achat du salaire aura progressé au pays au cours du dernier quinquennat, malgré la plus importante poussée inflationniste des 30 dernières années.
Les deux graphiques suivants permettent encore mieux d’apprécier l’évolution du pouvoir d’achat du salaire depuis janvier 2019. Construit à partir de la croissance du salaire horaire moyen, le pouvoir d’achat est ajusté de façon à éliminer les effets de l’inflation sur le salaire.
S’il est vrai que les années 2021 et 2022 ont montré de légers replis du pouvoir d’achat, ceux-ci ne sont pas suffisamment prononcés pour invalider l’importante progression obtenue en 2021. Et la progression récente tend à normaliser la situation économique des ménages. En somme, le pouvoir d’achat du salaire aura progressé annuellement en moyenne de 0,9 % au cours des cinq dernières années au Québec. Une progression similaire à ce qui est observé dans la province au cours des deux dernières décennies (graphique 2).
Un autre point important est à considérer : sachant que le pouvoir d’achat est calculé à partir de la progression du salaire horaire moyen, il ne prend donc pas en compte les changements fiscaux et l’aide gouvernementale ayant eu cours lors de la pandémie. Le bien-être des salariés canadiens et québécois est alors clairement sous-estimé. Depuis 2020, le fédéral a versé des sommes importantes sous la forme de prestations canadiennes d’urgence (PCU) et de prestations canadiennes de la relance économique (PCRE), et ce, sans compter les efforts du gouvernement du Québec. Le gouvernement provincial a de son côté versé des sommes ponctuelles pour contrer la hausse du coût de la vie, bonifié son soutien aux aînés et allégé les impôts payables par l’ensemble des contribuables québécois.
S’il est vrai que l’évolution du pouvoir d’achat des travailleurs québécois leur a été favorable en « moyenne », l’analyse ne révèle rien sur la répartition du pouvoir d’achat autour de la moyenne. Certains d’entre nous auront en effet perdu du pouvoir d’achat, mais attention, ce n’est pas la majorité !
Que retenir de cette analyse ? D’abord, il est vrai que l’inflation nuit au pouvoir d’achat, mais les effets en sont temporaires et la rémunération a, malgré tout, suivi l’inflation au pays au cours du dernier quinquennat. Dans les faits, le pouvoir d’achat au Québec s’est accru, et même davantage que celui des autres Canadiens. Finalement, même si le Québec est champion canadien de l’inflation, la volatilité ambiante des prix nuit à notre lecture. Notre pouvoir d’achat du salaire a augmenté cumulativement à peu près au même rythme qu’au cours des 20 dernières années. Une réelle surprise à en croire la croyance populaire.

Février était le mois de la prévention du suicide au Québec. La campagne Mieux vaut prévenir que mourir, présentée par l’Association québécoise de prévention du suicide, met de l’avant l’importance de la prévention et encourage les gens à oser parler du suicide malgré les craintes ou le malaise, puisqu’agir peut tout changer. Même en milieu de travail.

Voir, reconnaître et oser en parler
Plusieurs signes peuvent indiquer qu’un de nos proches/collègues ne va pas bien. Tous les CHANGEMENTS de comportements et d’humeur peuvent être des signaux d’alarme.
Isolement
Découragement
Perte de motivation
Tristesse
Apparence négligée
Colère
Agressivité, etc.
« Poser la question ou parler du suicide peut encourager le passage à l’acte. » – FAUX
Demander directement à une personne si elle pense au suicide, ce n’est pas lui suggérer l’idée, mais ouvrir la porte à l’expression de sa souffrance. Un simple « comment ça va ? », en prenant bien le temps d’écouter la réponse, peut aider la personne en détresse à ressentir un soulagement et constater qu’elle n’est plus seule.
Vous connaissez un collègue, un proche qui vit une situation difficile en ce début d’année, que ce soit une rupture, un deuil, des problèmes financiers, de la violence, etc. ?
Soyez proactif et OSEZ lui demander ou en parler avec un professionnel qui pourra vous aider en ce sens. Et même si cette personne n’a pas les idées noires, cela lui aura fait du bien d’en parler avec quelqu’un qui se soucie de sa santé.
Les troubles mentaux représentent plus de 31 % des invalidités les plus courantes. Face à cette tendance, il est important de se prévaloir d’un régime d’assurance qui inclut une protection d’assurance invalidité. Communiquez avec votre conseiller chez Lussier pour étudier les options d’assurance invalidité disponibles pour vous et votre famille.
:
L’Association québécoise de prévention du suicide offre une multitude d’outils et de ressources : Oseparlerdesuicide.com
Vous pensez au suicide ou vous vous inquiétez pour un proche ? Des intervenants sont disponibles pour vous aider, partout au Québec, 24 heures sur 24, 7 jours par semaine
Téléphone | 1 866 appelle (277-3553)
Texto | 535353
Clavardage, information et outils Suicide.ca

1 877 543-2960
Votre copropriété est votre maison, mais ses besoins en matière d’assurance sont bien distincts. Avec les changements apportés aux lois dans le domaine de la copropriété divise qui s’ajoutent aux nombreuses particularités de l’assurance habitation dans ce cas précis, il est facile de s’y perdre. Nous avons donc rassemblé ici les renseignements essentiels à prendre en considération lors de l’achat ou du renouvellement de votre assurance condo.

Tout d’abord, il vous faut faire la différence entre :
l’assurance du contenu de votre unité à laquelle vous devez souscrire vous-même en tant que propriétaire; et
l’assurance de l’immeuble, couverte par ce qu’on appelle le syndicat; Toutes deux sont étroitement liées; assurez-vous donc qu’elles couvrent bien ce qui vous convient.
Deux assurances, une même habitation
Votre assurance condo doit couvrir vos biens personnels, votre responsabilité civile et finalement, les améliorations que vous pourriez apporter à votre unité.
L’assurance du syndicat de copropriété, de son côté, couvre le bâtiment, les espaces communs et l’aménagement d’origine de chaque condo. Le syndicat doit obligatoirement prendre cette assurance, pour laquelle un montant vous est prélevé à même les frais de copropriété.
Envie de rénos pour votre condo ? Assurez-les aussitôt
Vous changez les comptoirs de stratifié de votre condo pour des comptoirs de granit ? Vous offrez un refacing complet à vos armoires ? Avant de vous laisser aller à vos envies créatives, soyez informé que l’assurance du syndicat de copropriété ne couvre que les aménagements d’origine, c’est-à-dire les aménagements tels qu’ils étaient à l’achat initial. Tout ce qui ne fait pas partie du « standard » de l’unité de condo est considéré comme une amélioration que vous avez la responsabilité de couvrir à l’aide de votre assurance habitation personnelle. Ceci s’applique également aux améliorations faites par les propriétaires précédents. Vérifiez donc que les montants d’assurance offerts par votre assureur habitation sont suffisants pour couvrir toutes les améliorations.
La portion responsabilité civile est alors votre meilleure alliée. Comme vous pourriez être tenu responsable de certains dommages causés à la copropriété, vérifiez que la portion responsabilité civile corresponde à vos besoins et aux exigences de la loi afin de servir à rembourser les montants réclamés. Il est prescrit que les copropriétés de moins de 13 unités soient assurées pour une somme minimale d’un million, tandis que pour celles qui comptent plus de 13 unités, la somme s’élèverait à deux millions. Nous recommandons toutefois de vous prévaloir d’une assurance plus élevée, les dommages que vous pourriez causer pouvant s’élever à de plus gros montants.
La franchise est en fait le montant que vous devez assumer en cas de sinistre. Un dégât d’eau, c’est si vite arrivé ! Par exemple, vos planchers sont trempés, gondolés et doivent être remplacés. Vous réclamez alors à votre assureur habitation personnelle un montant de 2 000 $. Par contre, la franchise figurant à votre contrat d’assurance est de 500 $. Votre assureur ne vous remboursera que la différence de 1 500 $. Bien sûr, pour la meilleure protection qui soit, allez-y avec une franchise avec laquelle vous êtes à l’aise, en fonction du montant de la prime d’assurance que vous êtes capable de payer selon votre salaire et vos autres obligations financières.
Attention à la contribution spéciale !
Un autre dégât d’eau a endommagé une partie des aires communes ?
Votre syndicat pourrait et aurait le droit de vous réclamer une contribution spéciale, un montant qui s’ajoute aux frais de condo mensuels, pour couvrir les coûts de réparation.
Effectivement, si la franchise de l’assurance du syndicat de copropriété pour le dégât d’eau ne couvre qu’une partie des réparations, celui-ci peut alors imposer une contribution spéciale à chaque copropriétaire pour combler le manque à gagner. Renseignez-vous : votre assureur vous offre souvent la possibilité d’ajouter une « garantie complémentaire – répartition » (dégât d’eau pour reprendre l’exemple) à votre contrat pour rembourser le coût de certaines cotisations spéciales liées à la réparation de dommages non indemnisables par l’assurance du syndicat. Par contre, pour que cette garantie s’applique, vous devez évidemment être assuré contre le risque en question.
Chez Lussier, nous pouvons assurer votre condo, votre responsabilité et les administrateurs de votre syndicat de copropriété ! Communiquez avec nos courtiers pour en savoir plus.
La revue spécialisée en optométrie appréciée des professionnels de la vue du Québec depuis 45 ans !
Tirage : 3 000 exemplaires
Distribution : Postes Canada



Temps partiel permanent Centre Visuel de Lorraine centrevisueldelorraine.com
Temps plein permanent Clinique d’optométrie de Buckingham buckingham@opto-reseau.com



Docteure Isabelle Ouimet, optométriste 514 570-9024 isaouimetod@hotmail.ca
Clinique indépendante, établie depuis 40 ans et membre de la bannière SOI. Nous recherchons un(e) optométriste pour se joindre à une belle équipe composée de 3 optométristes, 1 opticienne d’ordonnances et plusieurs assistantes certifiées. Notre clinique est très bien équipée : OCT / photo Nidek, Octopus 900, Tonoref III, Lenstar, dossiers électroniques. Nous avons une clientèle familiale et fidèle. N’hésitez pas à me contacter, il me fera plaisir de vous rencontrer.
Temps plein / partiel / permanent Clinique visuelle de Verchères optoplus.com
Docteure Johanne Roy, optométriste 450 583-6644 optojroy@yahoo.ca
Vous cherchez un environnement de travail agréable qui répond à vos besoins ? La clinique visuelle de Verchères, bien établie depuis 33 ans, est à la recherche d’un(e) optométriste motivé(e) pour se joindre à son équipe dynamique. En plus d’une clientèle fidèle et variée, la clinique est fermée la fin de semaine pour une conciliation travail-vie personnelle idéale. Vous aurez la chance de planifier votre horaire selon vos disponibilités et de développer la pratique que vous souhaitez. Venez pratiquer dans une clinique bien équipée (OCT, CV, laboratoire sur place) qui vous permettra de vous épanouir sur le plan professionnel ! Vous pouvez me rejoindre en toute confidentialité.
Docteure Christine Paquin, optométriste 819 213-5438 cpaquin@optobuck.ca
Clinique indépendante, membre de la bannière Opto-Réseau recherche un(e) optométriste pour joindre une équipe dynamique de 4 opticiens d’ordonnances et plusieurs assistantes. Les horaires sont flexibles et nous sommes fermés la fin de semaine. Nous avons 4 salles d’examens disponibles et avons OCT, Optomap, topographe, champ visuel Humphrey, biométrie et clinique de sécheresse (IPL, radiofréquence) ainsi qu’un laboratoire sur place. Nous avons une clientèle très diversifiée, familiale et fidèle. N’hésitez pas à me contacter en toute confidentialité.
Temps plein / partiel Optique Santé optiquesante.com
Docteure Ariane Roy, optométriste
Madame Christine Michaud 418 543-2020 ou 418 590-2021 info@optiquesante.com
Que cherchez-vous comme pratique d’optométrie ? La flexibilité, l’humanité, l’équilibre entre la vie professionnelle sociale et familiale, un environnement technologique, un personnel dévoué ? Optique Santé, clinique indépendante établie depuis 35 ans, vous offre 8 salles d’examen, 5 optométristes, 3 opticiens d’ordonnances, assistantes, OCT, caméras, Lipiview-Lipiflow et la possibilité de travailler selon vos disponibilités. On vous attend pour vivre l’expérience de notre clinique située au cœur de la ville de Chicoutimi.
Temps plein
LOPTICIEN.CA
Docteur Alain Côté, optométriste 514 244-0151 ou 514 592-3692
Madame Marie Vachon marie.vachon@lopticien.ca
LOPTICIEN.CA propriétaire indépendant avec deux boutiques dans la région de Laval offre à ses optométristes un environnement professionnel, l’utilisation d’équipements à la fine pointe de la technologie et garantit des journées complètes de rendez-vous.
Temps plein
Centre Visuel des Eskers
819 732-6831
Docteure Andrée-Anne Roy, optométriste 819 354-6078 andree-anne.roy@hotmail.com
Docteure Caroline Coulombe, optométriste 819 856-3630 caroline.coulombe@lino.com
Le Centre Visuel des Eskers d’Amos recherche un(e) optométriste à temps plein avec possibilité de travailler 4 ou 5 jours par semaine. Notre clinique établie depuis plus de 75 ans, permet aux optométristes d’avoir une pratique de l’optométrie très variée, valorisante et enrichissante. Patients fidèles à leur optométriste, clientèle variée de tous âges, pathologies, lentilles cornéennes, lunetterie, équipements de pointe, collaboration avec les ophtalmologistes, assistantes certifiées et opticienne d’ordonnances. Nous avons des horaires flexibles et très remplis. Fermé les samedis et ouvert un seul soir par semaine. C’est l’opportunité de démarrer une merveilleuse carrière en région, loin des embouteillages, de profiter des grands espaces et de travailler près de la maison. De plus, notre clinique est entièrement rénovée ! Nous vous attendons !
Temps plein / permanent / temporaire / partiel Greiche & Scaff greiche-scaff.com
Docteur André Aoun, optométriste 514 207-9211 andre.aoun@greiche-scaff.com
Nous vous offrons des conditions exceptionnelles, une très grande flexibilité de pratique et un encadrement dynamique. Nos priorités sont vos besoins pour oeuvrer à la santé de vos patients. Parce qu’avant d’être nos clients, ils sont avant tout vos patients. Saisissez dès maintenant l’opportunité de faire partie de notre grande famille Greiche & Scaff. Notre promesse ? Votre tranquillité d’esprit. Discrétion assurée.
Temps plein, temps partiel, volant, permanent ou temporaire
IRIS, Le Groupe Visuel Pour plus de détails, visitez : career.iris.ca/fr/optometristes
Docteure Jahel St-Jacques, optométriste 418 234-4510 jahel.st-jacques@iris.ca
La qualité des services aux patients vous tient à cœur ? Vous recherchez un environnement de pratique favorisant la collaboration interprofessionnelle, une clientèle familiale et fidèle ainsi que de l’équipement de pointe ? IRIS a des opportunités partout au Québec : Rive-sud de Montréal, Outaouais, Lanaudière, Trois-Rivières, Sherbrooke, Québec/ Lévis, Bas-St-Laurent, Charlevoix, Sept-Iles, SaguenayLac-St-Jean, Abitibi-Témiscamingue ! Plusieurs postes d’optométristes volants et opportunités de partenariat sont disponibles ! En plus d’une remarquable qualité de pratique, plusieurs secteurs vous offriront une qualité de vie avantageuse et de nombreux attraits touristiques et activités de plein air.
Temps partiel / remplacements ponctuels
Raymond et Côté, opticiens et optométristes mobiles visionrc.ca
Docteure Shelton Regismarianayagam, optométriste 514 946-1010 poste #3 cv@visionrc.ca
L’équipe de Raymond et Côté est à la recherche d’optométristes désireux de varier leur pratique à travers nos cliniques visuelles mobiles au service des aînés. Forts de nos 31 ans d’expertise en cliniques mobiles dans la région de Montréal, nos services s’installent dans la région de Québec. Nous offrons un environnement de travail atypique et très enrichissant auprès d’une clientèle ayant de grands besoins. Que ce soit pour des besoins ponctuels ou de façon plus régulière à temps partiel, nous serons enchantés de vous accueillir dans notre belle équipe déjà composée de 6 opticiens d'ordonnances et 7 optométristes. Au plaisir de vous rencontrer !
Temps partiel / plein
Centre Visuel Rawdon centrevisuel.ca
Docteure Émilie Coutu, optométriste 450 750-6844 emilie.coutu@centrevisuel.ca
Établie dans la région depuis plus de 30 ans, notre équipe a su développer un lien particulier avec sa précieuse clientèle, qui comble nos journées. Au Centre Visuel Rawdon, vous aurez la chance de travailler de concert avec une équipe dévouée et qualifiée qui se compose de 3 optométristes, de 6 opticiennes d’ordonnances, d’une assistante certifiée, de 3 secrétaires et d’une technicienne de laboratoire. Notre clinique est équipée à la fine pointe de la technologie : CV FDT, CV Octopus, OCT, autoréfractomètre / jet d’air automatisé, dossiers électroniques. Venez profiter de notre ambiance chaleureuse et familiale. Que ce soit à temps partiel ou à temps plein, il nous fera plaisir de vous rencontrer.
Temps plein
Optiprix optiprixgranby.com
Docteur Mario Duchemin, optométriste
Madame Marie-Joëlle Papineau 450 777-4833 info@optiprixgranby.com
Horaire flexible. Clientèle établie, bureau en pleine expansion. Trois opticiennes d’ordonnances et un optométriste. Équipe stable. Ambiance de travail agréable et sans pression. Possibilité de prime à la signature d’un contrat et ou association. Situé près de l’autoroute 10.
Temps plein ou partiel permanent
Centre Visuel de Prévost centrevisuel.net
Docteure Christine Larivière, optométriste 450 224-2993 cv@centrevisuel.net
Situé dans la région des Laurentides, installé depuis plus de 25 ans dans une chaleureuse maison en pierre, le Centre Visuel de Prévost recherche un(e) optométriste pour compléter son équipe (départ à la retraite). 2 salles d’examen sont disponibles ainsi qu’une salle de prétests incluant OCT et Octopus. Les prétests sont faits par des assistantes et un opticien d’ordonnances est présent pour la salle de montre. Le bureau est ouvert 2 soirs par semaine et fermé les week-ends. Pour nous offrir vos services, veuillez communiquer avec nous.
Temps plein selon les disponibilités / partiel / permanent Clinique d’optométrie L’Émerillon emerillon.ca
Docteur Pascal Cyr, optométriste 418 689-5553 pascalpv@hotmail.ca
Les cliniques d’optométrie L’Émerillon de Québec (clinique indépendante) sont présentement à la recherche d’un(e) optométriste pour compléter leur équipe. Possibilité d’un travail à temps plein de 4 à 5 jours en semaine (horaire flexible) et aussi un travail à temps partiel selon vos disponibilités. N’hésitez pas à me contacter en toute confidentialité.
Temps partiel / remplacements ponctuels
Raymond et Côté, opticiens et optométristes mobiles visionrc.ca
Docteure Shelton Regismarianayagam, optométriste 514 946-1010 poste #3 cv@visionrc.ca
L’équipe de Raymond et Côté est à la recherche d’optométristes un jour/semaine sur le territoire de Laval et de la Rive-Nord. Vous êtes optométriste à la recherche d’un peu d’aventure ? Nous sommes ouverts à rencontrer des professionnels de cœur qui veulent améliorer le monde. Si vous voulez explorer vos possibilités de pratique mobile en RPA et en CHSLD avec une équipe dédiée à la mission, contactez-nous pour en discuter et venir observer nos équipes sur le terrain. Nous serons enchantés de vous accueillir dans notre belle équipe déjà composée de 6 opticiens d’ordonnances et 7 optométristes. Au plaisir de vous rencontrer !
Contractuel 1 semaine ou + / année
Docteure Annie Dionne, optométriste
514 694-0836
Demandez Steffan steffandonnelly_ood@hotmail.com optiquedonnelly.com
Optique Donnelly est à la recherche d'optométristes pour accompagner ses équipes d'opticiens d’ordonnances à travers le Nunavik. Saisissez l'opportunité de découvrir les communautés du Grand Nord québécois. 14 villages de la Baie d'Hudson et d'Ungava vous attendent. Les voyages sont de 6 jours. Déplacements et hébergements pris en charge. Rémunération jusqu'à 2000 $ / jour de travail + perdiem. Expérience extraordinaire et dépaysement garanti.
Temps plein selon les disponibilités / partiel / permanent Clinique d’optométrie L’Émerillon emerillon.ca
Docteur Pascal Cyr, optométriste 418 689-5553 pascalpv@hotmail.ca
Les cliniques d’optométrie L’Émerillon de Québec (clinique indépendante) sont présentement à la recherche d’un(e) opticien(ne) d’ordonnances pour compléter leur équipe.
Possibilité d’un travail à temps plein de 4 à 5 jours en semaine (horaire flexible) et aussi un travail à temps partiel selon vos disponibilités. N’hésitez pas à me contacter en toute confidentialité.
Docteur David Yalovsky, optométriste 514 235-0787
TRK-2P (4 en 1) Topcon (2021)
12 950 $ (6 500 essais pendant 3 ans)
Biomicroscope SL-D4 Topcon (2022) 5 875 $ (avec tonomètre Goldman attache)
F.D.T Zeiss
6 000 $
Lentimètre manuel Topcon LM-8E (2023) external scale a/c adaptor 1 280 $
Montures de marque connues – rabais jusqu’à 40 %
VENDREDI, 4 OCTOBRE DE 12 H À 18 H
SAMEDI, 5 OCTOBRE DE 10 H À 14 H 30
Palais des congrès de Montréal
Permettez à vos patients de voir au-delà de la perte de vision.
Guidez-les
pour les outiller à mener la vie lumineuse dont ils rêvent.

Assurance responsabilité professionnelle
Assurance clinique d’optométrie
Assurance des particuliers
Assurance collective

Rabais
Nerf optique automatisé en 3D
Le logiciel d’analyse automatisée 3D de la tête du nerf optique de ZEISS mesure avec précision le bord neuro-rétinien, tout en tenant compte des disques inclinés, des perturbations de l’EPR et d’autres pathologies difficiles.
Analyse de la tête du nerf optique (ONH) et de la RNFL
Les analyses ONH CIRRUS SmartCube™ basées sur l’anatomie tiennent compte de la morphologie complexe des disques, notamment les disques inclinés, l’atrophie péripapillaire et d’autres pathologies difficiles. Il rapporte l’épaisseur de la RNFL sur l’ensemble de la zone péripapillaire, et pas seulement sur l’anneau TSNIT, et identifie les zones qui se situent en dehors des limites normales.
Analyse PanoMap™ Wide-Field
Les données structurelles de l’ensemble du pôle postérieur sont affichées - les mesures RNFL, ONH et GCA montrent l’étendue des dommages structurels.
Balayage angulaire HD et balayage grand angle avec mesures
L’angle irido-cornéen est parfaitement détaillé grâce aux outils de mesure inclus pour la distance d’ouverture de l’angle (AOD500/750) et la zone de l’espace trabéculaire de l’iris (TISA500/750) afin de quantifier et de suivre le degré de fermeture de l’angle.

L’ouverture de la membrane de Bruch (BMO) définit automatiquement la marge du disque optique. Calcul avancé de la section transversale minimale1 pour la quantification des bords de la neurorétine.





